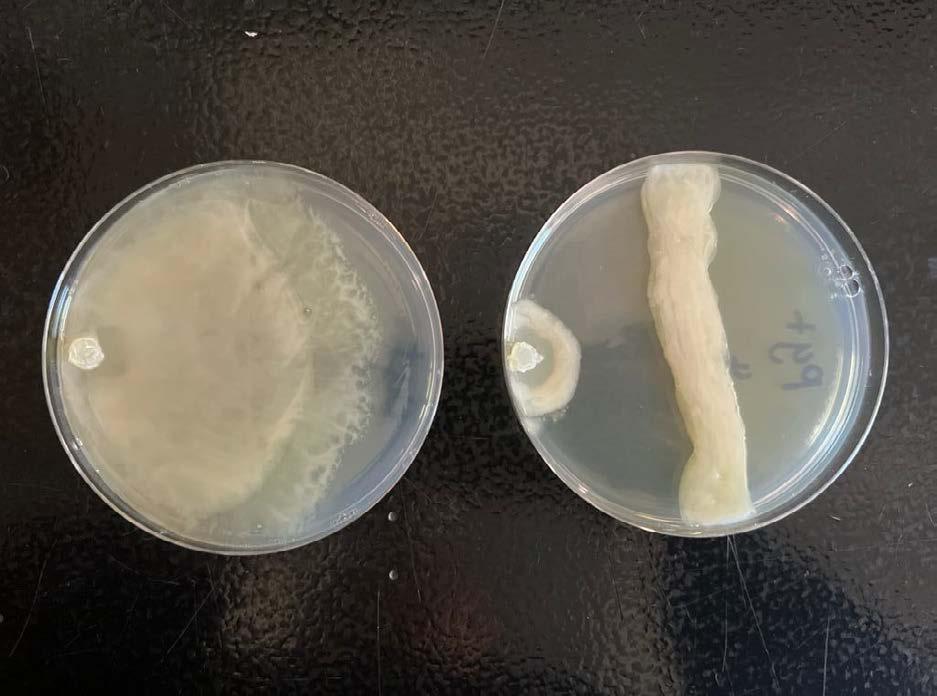
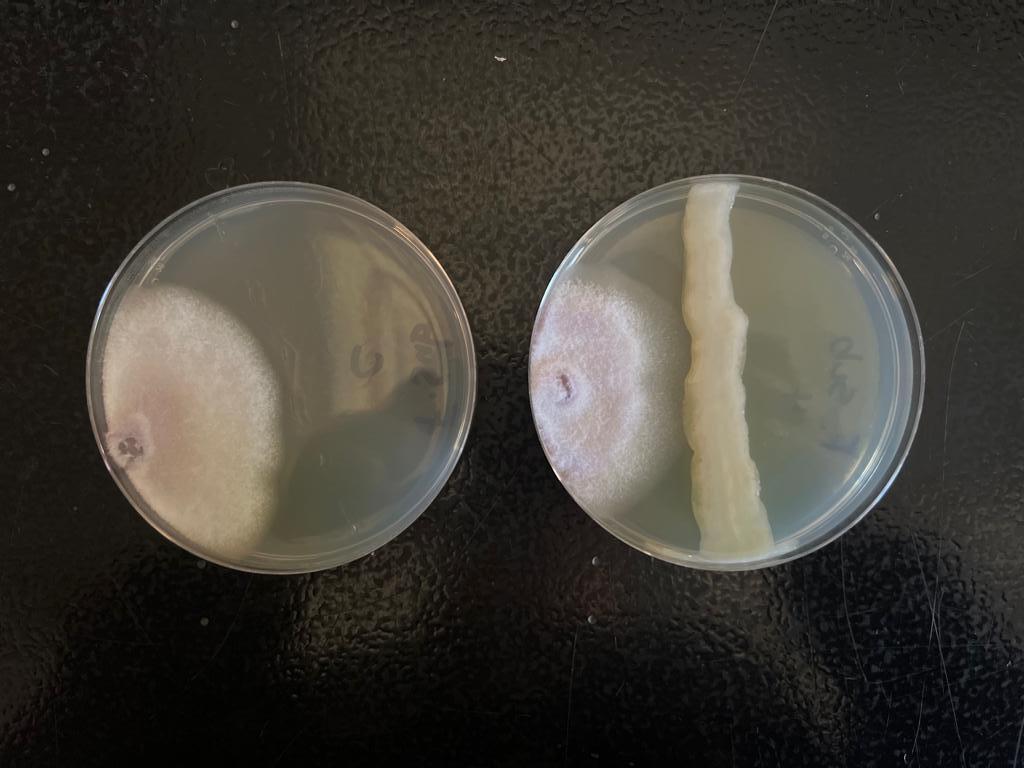

Breck School Advanced Science Research Journal




![]()




The Breck Advanced Science Research Program is the capstone course of the Breck science curriculum. This program gives students who are passionate about science and engineering the opportunity for an authentic, high-level summer research experience in collaboration with research professionals in universities, colleges or businesses.
Following the summer research component of the program, students participate in a year-long science research seminar class where they write and submit formal research papers and project presentations to the Twin Cities Regional Science Fair, Regional Junior Sciences and Humanities Symposium and the Minnesota State Science and Engineering Fair, with some students continuing on to the National Junior Sciences and Humanities Symposium or the International Science and Engineering Fair. In addition, Advanced Science Research students participate in a formal seminar at Breck where they present their work to family members, research advisors, and peers.
More information about the Breck School Advanced Science Research Program is available on our website: breckschool.org/asr
Dr. Kati Kragtorp, Director Advanced Science Research Program
A cross-sectional analysis of police contact and adverse birth outcomes in US-born Black, White, and Foreign-born Black women
Optimizing an enzyme-linked immunosorbent assay to determine antibody concentrations in glioblastoma patients
Use
Mina Adabag
Introduction
Almost 50% of US adults were exposed to dangerous levels of lead as children, and low-income communities have been impacted the most. The Twin Cities have some of the highest levels of lead pollution in the state, leading to detrimental effects ranging from delayed neurological development in children to increased rates of miscarriage for pregnant women (Blotz, 2020). Aircrafts operating on leaded fuel, leaded paint and pipes, incinerators, coal-fired utilities, and other forms of infrastructure produce toxic lead, which contaminates the air and soil (Heavy Metal Pollution and Food Security in the Twin Cities: Lead Chemistry in Urban Gardens and Local Remediation Strategies, n.d.). Often overlooked is the impact of this anthropogenic factor on ecosystem health.
As major pollinators, members of the order Lepidoptera ensure the propagation and genetic diversity of plants (Sharma et al , 2020) Additionally, butterfly larvae herbivory regulates plant and insect population levels, contributing to the intricate balance of flora in an ecosystem Regarding trophic levels, butterflies predate on many organisms that feed on both native and introduced plant species Insectivorous organisms, including birds, bats, and many insects, rely on butterflies as a part of a diverse diet As well as being ingrained in the local ecosystem, butterflies serve unique roles in rearing the offspring of certain wasp species From lessons in elementary school about metamorphosis to playing an integral role in a variety of ecosystems, lepidopterans are also relied upon by humans in a variety of ways (Why Butterflies Matter, n.d.). Although this is a global reality, this interdependence also plays

out in our own backyards, as butterflies play an integral role in the Midwest urban ecosystem
Human activity has continued to threaten the population stability of many species through fluctuating climates, habitat loss, and the introduction of invasive species Butterflies, like many insects, are particularly sensitive to these unnatural shifts, jeopardizing not only individual species but also entire ecosystems that humans rely on (Kucherov et al., 2021). However, there has been minimal research analyzing the impact of lead, or other heavy metals, on butterflies One study found that lead exposure impacts eye size of cabbage whites, though the direction of the effect depends on sex (Philips et al , 2016) Exposure to another heavy metal, zinc, decreased survival of both monarch and cabbage white butterflies (Shephard et al , 2020) Previous research has shown how heavy metals impact the fitness of other organisms, namely Drosophila and Fundulidae (Shephard et al , 2022). Despite previous research, there is still limited understanding of the impacts of lead exposure in an urban environment
Cabbage white butterflies, Pieris rapae, are an invasive species in North America. Endemic to Europe, these organisms first appeared near the United States in the 1860s and have since been largely regarded as agricultural pests. Cabbage white caterpillars have the potential to decimate entire cabbage fields, resulting in significant economic effects (Ryan et al., n.d.). Additionally, these non-native species negatively affect many butterflies native to Minnesota, including the threatened Mustard White, Pieris oleracea Despite their “pest” status, cabbage white butterflies have carved a niche as a part of the urban Minnesotan ecosystem (Investigating Life with the Cabbage White Butterfly and Brassicas in the Classroom, n.d.). They are often
subjects of evolutionary plasticity studies. Research has shown that invasive species such as P rapae exhibit a phenomenon known as fitness costs. This describes an organism that has higher survivability in varied and often polluted environments than in pristine ones (Snell-Rood & Ehlaman, 2021).
Monarch butterflies, Danaus plexippus, are a native species to Minnesota With population health fluctuating over decades, this species has been an ambassador organism to the field of conservation for years (Snell-Rood, 2012) This year, the International Union for Conservation of Nature (IUCN) reinstated monarch butterflies as an endangered species (Migratory Monarch Butterfly Now Endangered - IUCN Red List, 2022). An essential aspect of Minnesota urban ecosystems, monarchs are particularly sensitive to environmental pollution as a native population.
The fitness of individual specimens can be measured to assess the health of a species. For this study, four factors were considered: brain mass, wing length, wing area, and fertility Brain mass is used to determine the amount of neural tissue developed. Additionally, wing measurements dictate a butterfly’s ability to travel and successfully survive in their environment while fertility provides insight into the potential for reproductive success of an individual. Together, these characteristics can be used to indicate the survivability and evolutionary health of collected species (Snell-Rood, 2012).
This research aimed to determine the impact of lead pollution in the Twin Cities on two integral butterfly species in Midwest ecosystems, monarch butterflies and cabbage whites. It was hypothesized that environmental lead exposure would impact the fitness of monarch butterflies, yet not that of cabbage white butterflies. A significant decrease in the wing area, length, and brain mass was found in monarchs when compared to a gradient of childhood blood levels in collection areas, although, there was no notable impact in monarch fecundity In contrast, none of the characteristics of fitness
measured in cabbage whites correlated with childhood blood levels in collection areas
Collecting samples
Thirty sites (Figure 1) that showed childhood blood lead levels of 3+, 1-2, or 0 times the state average were chosen in the Twin Cities metro. De-identified data on the average blood lead content of the residents in these areas was obtained from MN Department of Health publicly-available databases (Blotz, 2020). Each site was approved by the city government, who designated regions and procedures for sample collection (Figure 2). Subsequently, each site was visited four times between May-August 2022, where 200+ bioindicators were collected: invasive cabbage white butterflies (Pieris rapae) and native monarch butterflies (Danaus plexippus). Butterflies were kept dormant in a cooler (4.4°C). They were contained in wax envelopes labeled with independent IDs, the date of collection, and the site title.

Google Earth).
Mina Adabag

Figure 2. Map of Marydale Park, a collection site, exhibits how approved collection regions were designated (Figure by Snell-Rood lab)
To euthanize the butterflies, the head was rapidly removed from samples dormant in a cooler. The bodies were subsequently stored in a lab freezer (-20℃ ) Using a dissecting microscope, the antennae, proboscis, and palps were removed in 1x phosphate-buffered saline (PBS) Small incisions were made in the eyes to ensure saturation of preservatives and fixture of brain tissue The sample was transferred to a 2ml vial of 10% formalin and formaldehyde buffer The individually-labeled vials were placed on a shaker plate for 15-18 hours The following day, the samples were transferred from the buffer to 0.01 M cacodylate buffer in a chemical fume hood In 1x PBS, butterfly heads were detached from the thorax using 0 04 mm forceps The two optic lobes and central dense neural tissue were removed from the cuticle The ommatidia and soft trachea were collected with the neural tissue for all specimens. All dissected brain tissue was transferred to a vial of 95% ethanol, labeled, and stored in the lab refrigerator (4 4℃ ) Empty tins were weighted using an analytical scale. All neural tissue was transferred from ethanol vials to individual aluminum tins Samples were subsequently dehydrated in a drying oven set to 50℃ for 24 hours Finally, each tin was weighed to calculate the brain mass of each specimen
The forewing of each specimen was removed from the thorax Using a digital camera (Canon), wings were photographed beside a ruler to set relative scale. After calibrating the scale using this measurement, data was collected using FIJI ImageJ software (Schindelin et al , n d ) Wing length was measured from the apex of the wing to the point at which it connects to the thorax If this junction was not a single small point, the topmost connecting point was used. In P. rapae, the apex is the top edge point before it rounds off In D plexippus, the apex appears between the second and third white spots at the point that the wing perimeter drops downwards Wing area was similarly measured using the polygon border tool in FIJI ImageJ. In the case of an incomplete wing, the edges of the rip were used to approximate the missing area to avoid obstructing the measurements.
Under a dissecting microscope at 10x and 20x magnification, the abdomen of female butterflies was removed from each specimen. The abdominal cavity was subsequently dissected to access the ovaries. Using a tally counter, the number of mature eggs was recorded. Eggs were considered mature only if they were fully yolked, determined by comparing each to a fully mature egg nearest to the ovipositor.
Continuous variables were shown as mean ± standard deviation (SD). Data from the sites with childhood blood lead levels of 3+, 1-2, or 0 times were compared using ANOVA. An unpaired t-test was used to compare the data from sites with 3x lead levels with those obtained from sites with lower lead levels. All analyses were performed using Microsoft Excel (Microsoft Corporation, 2018)
Brain mass
The mean brain mass for P. rapae was 0.211 ± 0 057 mg (n =20), 0 152 ± 0 267 mg (n =16), and 0.218 ± 0.059 mg (n =17) at sites with 0x, 1-2x, and 3+x the average lead concentration, respectively (Figure 3) An ANOVA revealed no significant difference between mean butterfly brain mass collected in areas with 0x, 1-2x, and 3+x average childhood blood lead levels (p=0.619). A two-tailed t-test comparing sites with low (0x and 1-2x) and high (3x) average childhood blood lead levels also revealed no significant difference (p=0.464).

Figure 3. Pieris rapae average brain mass across lead levels
In D plexippus butterflies collected in areas with 0x, 1-2x, and 3+x the average childhood blood lead concentration, the mean brain masses were 0 705 ± 0 150 mg (n =14), 0 658 ± 0 148 mg (n = 9), and 0 549 ± 0 130 mg (n =7), respectively (Figure 4). An ANOVA revealed no significant difference between butterflies collected in areas with 0x, 1-2x or 3x average childhood blood lead levels (p=0.460). A two-tailed t-test comparing low (0x and 1-2x) and high (3x) average childhood blood lead levels revealed a significant decrease in mean brain mass in high lead level areas (p<0 05)

Figure 4. Danaus plexippus average brain mass across relative area childhood blood lead levels
Wing length
At 0x, 1-2x, and 3+x the average lead concentration, the P rapae mean wing length was 2.594 ± 0.149 cm (n =122), 2.582 ± 0.139 cm (n =44), and 2.536 ± 0.140 cm (n =18) respectively (Figure 5) An ANOVA revealed no significant difference between butterflies collected in areas with 0x, 1-2x, and 3+x average childhood blood lead levels (p=0 608) A two-tailed t-test comparing low (0x and 1-2x) and high (3x) average childhood blood lead levels also revealed no significant difference (p=0.185).

Figure 5. Pieris rapae average forewing length across lead levels
At 0x, 1-2x, and 3+x the average lead concentration, the D plexippus mean wing length was 5.436 ± 0.207 cm (n=11), 5.501 ± 0 354 cm (n=7), and 5 115 ± 0 301 cm (n=7) respectively (Figure 6) An ANOVA revealed no significant difference between butterflies collected in areas with 0x, 1-2x, and 3+x average childhood blood lead levels (p=0 085) A
two-tailed t-test comparing low (0x and 1-2x) and high (3x) average childhood blood lead levels revealed a significant decrease in mean wing length in high lead level areas (p<0.01).

Figure 6. Danaus plexippus average forewing length across lead levels
Wing area
At 0x, 1-2x, and 3+x the average lead concentration, the mean P rapae wing area was 2.570 ± 0.271 cm2 (n=22), 2.561 ± 0.238 cm2 (n=44), and 2 522 ± 0 249 cm2 (n=18) respectively (Figure 7) An ANOVA revealed no significant difference between butterflies collected in areas with 0x, 1-2x, and 3+x average childhood blood lead levels (p=0 935) A two-tailed t-test comparing low (0x and 1-2x) and high (3x) average childhood blood lead levels also revealed no significant difference (p=0.521).

Figure 7. Pieris rapae average forewing area across lead levels
At 0x, 1-2x, and 3+x the average lead concentration, the mean D plexippus wing area was 9.852 ± 0.789 cm2 (n=11), 10.136 ± 0.997
cm2 (n=7), and 8.834 ± 1.069 cm2 (n=7) respectively (Figure 8) An ANOVA revealed no significant difference between butterflies collected in areas with 0x, 1-2x, and 3+x average childhood blood lead levels (p=0 089) A two-tailed t-test comparing low (0x and 1-2x) and high (3x) average childhood blood lead levels revealed a significant decrease in mean wing area in high lead level areas (p<0 05)

Figure 8. Danaus plexippus average forewing area across lead levels
At 0x, 1-2x, and 3+x the average lead concentration, the P rapae mean egg count was 40.5 ± 23.512 (n=16), 57.95 ± 37.475 (n=20), and 32.2 ± 25.265 (n=15) respectively (Figure 9) An ANOVA revealed no significant difference between butterflies collected in areas with 0x, 1-2x, and 3+x average childhood blood lead levels (p=1 02) A two-tailed t-test comparing low (0x and 1-2x) and high (3x) average childhood blood lead levels also revealed no significant difference (p=0 0636)

9. Pieris rapae average mature eggs across lead levels
At 0x, 1-2x, and 3+x the average lead concentration, the D plexippus mean egg count was 33 286 ± 30 647 (n=7), 80 ± 71 433 (n=4), and 54.2 ± 17.413 (n=5) respectively (Figure 10) An ANOVA revealed no significant difference between butterflies collected in areas with 0x, 1-2x, and 3+x average childhood blood lead levels (p=0 421) A two-tailed t-test comparing low (0x and 1-2x) and high (3x) average childhood blood lead levels also revealed no significant difference (p=0 872)

Figure 10. Danaus plexippus average mature eggs across lead levels
Discussion
This study showed that there was a significant decrease in brain mass, wing area, and wing length of D plexippus collected from areas with low (0-2x) versus high (3+x) childhood blood lead levels. However, there was no correlation between fecundity and lead exposure in D plexippus. Thus, the hypothesis that D. plexippus will be impacted in this way was supported in terms of size, but not fecundity Importantly, there was no significant difference in brain mass, wing length, wing area, or the number of mature eggs for P rapae This result supports the hypothesis that P. rapae fitness is not notably impacted by lead exposure. These results indicate that the native species, D plexippus, potentially has reduced resilience to pollution and the impact of human activity in their habitat, whereas invasive species like P rapae have potentially greater resistance to a modified environment.
The sample sizes in this analysis were relatively small for each exposure level and type of butterfly, in part due to increasing restrictions on protocol for collecting D. plexippus. This was likely the reason that no ANOVA test showed a significant difference between the groups, while combining ‘low’ area measurements returned significant results Work is currently underway to increase the sample size for a more accurate representation of lead’s ecological impacts and ability to detect differences
This study used human blood concentration as a proxy for butterfly’s lead exposure. However, this is possibly inaccurate due to fundamental differences in the behavior of these distinct populations. For example, humans are generally more directly exposed to infrastructure, while butterflies are in greater contact with metal pollutants in soil and plants.
While wing measurements, fecundity, and brain mass can be used as proxies of fitness, this is an imperfect procedure. Likewise, factors outside of lead pollution can influence fitness. Areas with high levels of lead are degraded in various ways, meaning other conditions could potentially be causing the significant impact of lead on D. plexippus Additionally, though the collected D plexippus (not migratory) and P. rapae remain in the regions where they metamorphosed, the potential relocation of an individual impacts the amount of lead they were exposed to. Future work will address these factors through lab-rearing the samples in the presence of known levels of lead. This type of study will allow both a determination of causation and clarify whether the results might be due to other environmental factors. A combination of ecological studies is ideal for understanding the anthropological impact on urban ecosystems To determine lead exposure with greater accuracy, soil collected from the sampled environments at the time of butterfly collection is currently undergoing analysis for lead levels. Once this data is available, it will be compared with the specimen fitness measurements presented here to see if specific, local lead levels are more clearly correlated with butterfly fitness. Testing soil,
plants, and pollinators could further reveal how the heavy metal is moving through the trophic levels of the ecosystem
The differences reported here between P. rapae and D. plexippus highlight the potential impacts of invasive species Further research on this distinction can be used to inform management policies as we explore what makes a species resilient to anthropogenic changes to the environment. In terms of monarch conservation, this is an especially timely discussion, as the US federal government has yet to declare the species endangered, though the International Union for Conservation of Nature has made this decision in July 2022 Multiple factors perpetuated by humans are threatening these species’ survival from habitat loss to less predictable climates. It is hoped that the results of this study can be used as we create new species-protection policies and make decisions that will shape the future of all life in the Twin Cities, and beyond
I’d like to thank Dr. Snell-Rood for hosting me in her lab and mentoring me through the summer Thank you to Lindsey Kemmerling, Ashley Darst, and all members of the Snell-Rood lab for sharing your wisdom and mentorship, and for answering my endless questions. Finally, I’d like to thank Dr. Kragtorp for mentoring and guiding me through my research process As an aspiring researcher, I am incredibly grateful for the invaluable opportunities that these mentors have given me
Blotz, T (2020, January 22) Interactive map shows Minnesota neighborhoods at higher risk of lead exposure Fox 9 KMSP https://www fox9 com/news/interactive-map-shows-minnesot a-neighborhoods-at-higher-risk-of-lead-exposure
Heavy metal pollution and food security in the Twin Cities: Lead chemistry in urban gardens and local remediation strategies (n d )
https://files zotero net/eyJleHBpcmVzIjoxNjU3NjQyMjUzL CJoYXNoIjoiYmJiZWQzZjk2ZmVjY2E4OGNhNWM1MG E4ZGZhNDNlNTEiLCJjb250ZW50VHlwZSI6ImFwcGxpY 2F0aW9uXC9wZGYiLCJjaGFyc2V0IjoiIiwiZmlsZW5hbW UiOiJJb25FIFBiIGNvbW11bml0eSBnYXJkZW5zIHYyLnB kZiJ9/dc883e276a1143b21cb71e42d8e8982ca975e6d882d87 15fbddccf1e1b0f0bb5/IonE%20Pb%20community%20garde ns%20v2 pdf
Investigating Life with the Cabbage White Butterfly and Brassicas in the Classroom. (n.d.). Fast plants. https://www fastplants org/pdf/activities/Butterfly Activity pd f
Migratory monarch butterfly now Endangered IUCN Red List (2022, May 1) International Union for Conservation of Nature Red List https://www iucn org/press-release/202207/migratory-monarc h-butterfly-now-endangered-iucn-red-list
Philips, K , Kobiela, M , & Snell-Rood, E (2016) Developmental lead exposure has mixed effects on butterfly cognitive processes Pubmed Gov https://doi org/10 1007/s10071-016-1029-7
Ryan, S , Lombaert, E , Espeset, A , Vila, R , Talavera, G , Dica, V , Doellman, M , Renshaw, M , Eng, M , Hornett, E , Li, Y , Pfrender, M., & Shoemaker, D. (2019). Global invasion history of the agricultural pest butterfly Pieris rapae revealed with genomics and citizen science The Proceedings of the National Academy of Sciences https://www pnas org/doi/pdf/10 1073/pnas 1907492116
Schindelin, J , Arganda-Carreras, I , Frise, E , Kaynig, V , Longair, M , Pietzsch, T , Saalfeld, S , Schmid, B , Tinevez, J -Y , White, D. J., Hartenstein, V., Eliceri, K., Tomancak, P., & Cardona, A (n d ) Fiji An Open Source platform for biological image analysis https://doi org/10 1038/nmeth 2019
Shephard, A , Mitchell, T , Henry, S , Oberhauser, K , Kobiela, M , & Snell-Rood, E (2020) Assessing zinc tolerance in two butterfly species: Consequences for conservation in polluted environments Royal Entomological Society https://resjournals.onlinelibrary.wiley.com/doi/full/10.1111/ic ad 12404
Shephard, A , Zambre, A , & Snell-Rood, E (2022) Evaluating costs of heavy metal tolerance in a widely distributed, invasive butterfly Evolutionary Applications, 14(5), 1390–1402
Snell-Rood, E (2012) Selective Processes in Development: Implications for the Costs and Benefits of Phenotypic Plasticity Oxford Academic https://academic oup com/icb/article/52/1/31/740291?login=t rue
Snell-Rood, E , & Ehlaman, S (2021) Ecology and Evolution of Plasticity In Phenotypic Plasticity and Evolution (1st ed , pp 139–153) CRC Press https://www.taylorfrancis.com/books/oa-edit/10.1201/978042 9343001/phenotypic-plasticity-evolution-david-pfennig?refId =37724480-2454-4c52-9d2d-e2fd4f6a23b4&context=ubx
Sam Bae and William McNally
Sam Bae and William McNally
Introduction
Cardiovascular diseases are the leading cause of death worldwide, representing approximately 31% of all causes (Liu et al., 2021). The majority of cardiac diseases are characterized by cell death, including heart failure, myocardial infarction, and ischemia/reperfusion (Chiong et al., 2011). Survivors of myocardial infarction have a higher risk of recurrent heart disease, myocardial infarction, and mortality (Peters et al., 2021). The heart’s inability to regenerate, due to its limited capacity to repair, causes it to be prone to injury from stress, highlighting how cardiac injury can lead to an abundance of problems in the future (Chiong et al , 2011)
Since the mammalian heart is incapable of complete regeneration, it responds to injury by undergoing a process called ventricular remodeling (Cui et al , 2018) As one of the hallmarks of ventricular modeling, cardiac fibrosis is a major cause of pathology during the development of cardiovascular disease (Liu et al., 2021). This process is mainly driven by activated cardiac fibroblasts (Liu et al , 2021)
Cardiac fibroblasts produce large amounts of extracellular matrix (ECM) during fibrosis, which is a common characteristic of nearly every type of heart disease (Czubryt & Hale, 2021) The excessive accumulation of ECM material hinders cardiac function by increasing the stiffness of the heart, forcing the remaining cardiac muscle to work harder. No current therapies exist that target cardiac fibroblasts and their ECM secretion after cardiac injury
Secreted growth factors from myofibroblast activation may play a role in the activation of other cell types within the heart in response to cardiac injury. However, recent evidence suggests that fibroblast activation not only

stimulates ECM secretion but also alters paracrine signaling from cardiac fibroblasts to other cell types, such as cardiomyocytes (Liu et al., 2021). As a form of cellular signaling, paracrine signaling is a variation of cellular communication in which cells transmit signals over relatively small distances by passively diffusing secreted messages through extracellular fluid (Roy & Kornberg, 2015)
Pleiotrophin (PTN) is a secreted growth factor expressed in all vertebrate species (Papadimitriou et al , 2021) In humans, PTN’s coding gene is located on chromosome seven. Rauvala et al. isolated the 18Kd protein from perinatal rat brains and demonstrated its role in the growth and maturation of the brain (Rauvala, 1989). PTN has been shown to create and be secreted as a non-covalent dimer when heparin or other glycosaminoglycans are present (Bernard-Pierrot et al., 1999). Additionally, (Lu et al , 2005) observed two forms of PTN at 15 and 18 kDa in glioblastoma, but the different functions are not yet known. PTN is similar to fibroblast growth factors in its molecular mass and its aptness to bind to heparins. Importantly, PTN is robustly expressed by activated fibroblasts after myocardial infarction in neonatal mouse hearts (Ruiz-Villalba et al., 2020).
PTN is secreted into the ECM from fibroblasts and may play a role in affecting other cells via paracrine signaling (Nicin et al., 2022). PTN plays an essential role in the growth of neurites and the proliferation of neurons in the central nervous system (CNS). Additionally, it promotes angiogenesis, the formation of new blood vessels, by activating the proliferation and migration of endothelial cells (Wang, 2020). In addition, PTN’s highly proliferative behaviors have been implicated in the growth of some
cancers such as glioblastoma and breast cancer (Wang, 2020) The increased expression level of PTN following tissue injury has been demonstrated in the brain, heart, liver, and bone marrow Following neural damage, PTN promotes regeneration by activating angiogenesis in injured areas as well as macrophages, white blood cells specialized in killing bacteria (Wang, 2020) However, PTN’s role in adult cardiac injury response is currently unknown.
Based on its expression in neonatal activated fibroblasts and its established role in the proliferation of other cell types, we hypothesized that PTN plays a significant role in modulating response to cardiac injury We explored the role of PTN after cardiac injury in mice, using Transverse Aortic Constriction (TAC). TAC is a standard experimental model for pressure overload-induced cardiac hypertrophy and heart failure in mice (deAlmeida et al., 2010). TAC initially induces compensated heart hypertrophy, which is often associated with a relative increase in ventricular contractility (deAlmeida et al., 2010) The induced cardiac hypertrophy comes from the ligation of the transverse aorta, causing pressure overload that simulates natural heart failure (deAlmeida et al , 2010) This process allows researchers to measure cardiac hypertrophy by comparing TAC samples with sham-treated samples, where no constriction is induced.
We performed a Western blot analysis on murine hearts after TAC treatment and observed increased PTN levels in injured heart samples as compared to sham-treated heart samples. To test for an increase of PTN+ fibroblasts post-infarction, we performed immuno-histochemistry (IHC) on 1-week TAC mouse cardiac sections, staining for fibroblasts, myofibroblasts, and PTN. There was a significant increase in the percent of cells expressing PTN and the proportion of fibroblasts for 1-week TAC cardiac sections when compared to sham-treated cardiac sections. However, the difference in the number of fibroblasts expressing PTN was not significant.
Mouse treatments and sample preparation
All mouse treatments and sample collection were performed by a trained researcher prior to our involvement as a part of an ongoing research project in the lab under an existing IACUC protocol The mice were treated with isoflurane prior to surgeries. For the Trans Aortic Constriction (TAC), a thoracotomy was performed around the second rib Using silk sutures, the researcher tied two knots around the transverse aorta to create a constriction of 0.4 mm in diameter For sham-treated mice, constriction of the transverse aorta was not conducted. The incision was then closed using a prolene suture After surgery, the mice were returned to their enclosures and allowed to rest undisturbed for 7 days. Hearts were collected one week after surgery Isoflurane was administered to the mice before they were euthanized by a trained researcher via cervical dislocation Next, an incision was made on the mouse’s chest and the heart was harvested.
To prepare the samples for a Western Blot procedure, the hearts were each added to a microcentrifuge tube and immersed in liquid nitrogen. Lysis buffer was added to the tubes. Then, the samples were homogenized and placed in a centrifuge at 4℃ After centrifugation, the liquid from each tube was extracted and added to a new tube The tubes were placed on ice and the pellet was discarded Next, a bicinchoninic acid assay was performed to determine the protein concentration (BCA) In BCA, a bicinchoninic assay was added to the dissolved samples in an alkaline medium. The Cu2+ ions in the samples were reduced to Cu1+ which then bonded with the bicinchoninic acid, causing the solutions to turn different shades of purple. The number of Cu2+ ions reduced is representative of the concentration of the sample So, the darker the solution, the higher the concentration of protein in the sample A spectrometer was used to determine the exact concentrations Once the exact concentrations of each sample were known, the amount of sample added to the wells was adjusted accordingly Computations for this
process were done using a program in Excel that calculates how much of each sample should be added to the western blot gel so that the protein concentration across all samples is equivalent. Finally, loading dye was added to the samples and the tubes were stored in a -80℃ freezer
To prepare the samples for an IHC staining, the hearts were embedded in an OCT block and frozen in isopentane The samples were then sectioned to about 6 µm thick using a cryostat. After the sections were added to a fresh glass slide, the slides were stored in a -80℃ freezer This IHC preparation was done by a professional researcher.
We prepared running gels using distilled water, 1.5 M Tris buffer (pH 8.8), 30% acrylamide, 20% SDS, 10% ammonium persulfate (APS), 20% SDS, and TEMED. This solution was poured into the casings and isopropyl alcohol was added to get rid of any air bubbles Once the running gel solidified, the alcohol was removed. We then prepared the stacking gel with the same reagents as the running gel except 0 5 M Tris buffer was used (pH 6.8) in place of the 1.5 M Tris.
We added 2-Mercaptoethanol (BME) to each mouse heart sample so that the final solutions were 5% BME. BME acts as a reducing agent that straightens the proteins in the samples Next, the samples were loaded into an Eppendorf Thermomixer for 5 minutes. The gels were then put into a Bio-Rad blotting tub filled with 1X Running Buffer Next, the samples were added to the submerged gels. The power machine was set to run at 120V for 60 minutes Once the run was complete, we submerged filter paper, membrane sheets, and the gels in transfer buffer solution (80% buffer, 20% Methanol) Then, we added them to a Bio-Rad Semi-Dry Transfer Cell for 30 minutes at 22 V. Once the transfer was complete, the primary antibody to pleiotrophin (PTN, Abcam) was added and the membranes were washed with tris-buffered saline with tween (TBST) Then, donkey anti-rabbit H RP (Cell Signaling) was added The
Sam Bae and William McNally
membranes were washed with 0.01% TBST for the last time SuperSingal™ West Pico PLUS Stable Peroxide was added to SuperSignal™ West Pico PLUS in a small falcon tube (1:1). We then added this mixture to a container separate from the membranes Each membrane was soaked in the solution and placed in a Bio-Rad ChemiDoc XRS+ imager
Immunohistochemistry (IHC) Staining
Slides of mouse heart tissue were removed from storage at -80℃ , brought to room temperature, and then incubated in 4% paraformaldehyde (PFA) for 10 minutes at room temperature. Next, we washed the slides three times using 1X Phosphate Buffered Saline (PBS) solution to remove any remaining PFA. Next, a 5% Bovine Serum Albumin (BSA) solution was added to the slides and incubated for 45 minutes at room temperature. To prepare the antibody solution, we added the antibodies to Pleiotrophin (PTN), Vimentin (abcam), and aSMA (abcam) to 2% BSA. The slides were incubated in the solution overnight at 4℃ Next, the slides were washed in 1X PBS three times to remove any remaining antibody solution. The secondary antibodies donkey anti-rabbit IgG (1:200; Invitrogen), donkey anti-goat IgG (1:200; Invitrogen), and donkey anti-mouse IgG (1:200; Invitrogen) was then added to 2% BSA solution Next, DAPI (1:1000) was added to the BSA solution The solution was added to each of the slides, covered with parafilm, and incubated for 45 minutes at room temperature Finally, we washed the slides three times using 1X PBS. Before imaging, the hearts were coated with Vectashield antifade media The slides were imaged on a Zeiss Axioscope at 200x magnification.
Image analysis
Positive DAPI cells were quantified by Fiji ImageJ. Pleiotrophin and Vimentin were then quantified by hand, by us. Data wereanalyzed in Excel using a t-test to compare the two treatment groups.
Western blot analysis was used to assess the overall level of expression of Pleiotrophin between injured (1-week TAC) and uninjured mouse cardiac tissue samples Three 1-week TAC mouse samples and two sham-treated samples were loaded into the western blot Two bands were formed close to 22kDa (the higher band around 16kDa and the lower band around 20kDa) PTN was clearly present in two of the three TAC-treated samples, for both bands, but only the lower band appeared faintly visible in sham-treated counterparts Due to the limited availability of sham-treated samples, only two samples could be run, preventing statistical analysis GAPDH, a housekeeping protein, was used as a loading control for protein normalization (Figure 1).

Figure 1. Western blot for PTN (approx 22 kDa) in tissue from three injured (TAC) mouse hearts and two sham-treated mouse hearts. GAPDH was used as a loading control.
To investigate PTN activation specifically in cardiac fibroblasts, IHC was performed to look for PTN Vimentin (a marker of total fibroblasts) and alpha-SMA (a marker of myofibroblasts) were used to stain 1-week post-TAC and sham-treated cardiac sections DAPI was used to mark the nuclei of individual cells (Figure 2).
The number of PTN-positive cells in IHC images was quantified using Image-J, and the percentage of all cells expressing PTN was calculated for all 1-week TAC and sham-treated sections The average percent of total cells expressing PTN in TAC mouse cardiac sections was significantly higher than in sham-treated counterparts (p < 0 05; Figure 3)

Figure 3. The average percentage (± SEM) of PTN positive cells in 1-Week TAC (red; n = 16) and sham-treated (blue; n= 24) adult mouse cardiac sections.

2. Representative images of IHC staining of sham-treated (top) and TAC (bottom) heart sections for DAPI (blue), alpha-SMA (white), PTN (red), and Vimentin (green).
The average percentage of cells that were fibroblasts was significantly higher in 1-week TAC as compared to sham-treated sections (p < 0.05; Figure 4).

Figure 4. The average percentage (± SEM) of total cells that were fibroblasts in 1-Week TAC (red; n = 16) and sham-treated (blue; n= 24) adult mouse cardiac sections
The average percentage of fibroblasts expressing PTN was higher for 1-Week TAC adult cardiac mouse heart sections when compared to their sham-treated counterparts, but the difference was not significant (p = 0 056; Figure 5)

Figure 5. The average percentage (± SEM) of fibroblasts expressing PTN in 1-Week TAC (red; n = 16) and sham-treated (blue; n= 24) adult mouse cardiac sections
We began experimentation using a western blot assay of cardiac mouse samples to determine whether there was enough evidence of a general increase in PTN to justify further study The concentrations of the samples were equalized
Sam Bae and William McNally
prior to receiving the samples. There was a visible increase in expression for the 1-week TAC samples when compared to their sham-treated counterpart samples for the bands located around 22 kDa The western blot for PTN contained two separate bands, which was not expected. It is possible that these represent the different forms of PTN described by Lu et al (2005) Both bands were qualitatively darker in the TAC samples as compared to the sham-treated samples After viewing this promising visible increase in expression, which supported our hypothesis, we decided to stain cardiac mouse sections to search for a difference in the presence of PTN between injured and sham-treated mouse heart sections specific to fibroblasts
The average percent of total cells expressing PTN and the average percent of PTN+ fibroblasts were significantly higher in TAC tissue samples than in sham-treated samples This data suggests a potential role of PTN in the heart following cardiac injury. The observed increase potentially could have been due to the significant increase in overall fibroblasts. Additionally, the increase could also have been driven by other non-fibroblasts expressing PTN that were observed, but not quantified. The increase in the average percentage of fibroblasts expressing PTN between 1-Week TAC adult cardiac mouse heart sections compared to their sham-treated counterparts was not statistically significant, so there was no clear evidence that fibroblasts specifically increase pleiotrophin expression after cardiac injury.
We were unable to quantify our results for the performed western blot analysis, as not enough samples were used to be able to quantify the data collected. Immunohistochemistry can show the number of cells expressing PTN, but cannot analyze the amount of PTN per cell as western blot analysis can. Additionally, the image quality on the immunohistochemistry pictures contained several unwanted blemishes caused by errors while staining. This complication may have caused some images to be incorrectly quantified.
Quantification was only conducted once by hand, so additional trials will be needed to ensure accurate results
Our findings indicated that PTN levels rise after cardiac injury, providing a solid basis for future research on the role PTN plays in the response of the adult heart to injury. A better understanding of the role of PTN in fibroblasts post-injury could lead to the creation of more beneficial treatments for cardiac injury in the future that could curb the dangerously high mortality rate of heart disease
Further experiments should be conducted to understand the function of the PTN expressed by fibroblasts after cardiac injury. Immunocytochemistry (ICC) was performed by another member of the van Berlo lab on rat cardiomyocytes to determine whether the secretion of PTN from myofibroblasts played a role in the activation of cardiomyocytes, causing hypertrophy. This experiment found that there was no significant increase in cardiomyocyte hypertrophy in samples treated with PTN (unpublished results). Additional experiments conducted by the van Berlo lab did not find a significant difference in the amount of fibroblast activation between healthy and injured heart samples after being stimulated by TGF-beta signaling (unpublished results) More research is needed to find out the role of secreted PTN in response to cardiac injury; specifically regarding the cells in our IHC stainings that expressed PTN but not Vimentin, and thus were cells other than fibroblasts. Future steps would involve identifying those cell types and determining the effect of PTN on their function.
We appreciate Dr. van Berlo hosting us in his lab and providing us with supervision over the summer. Furthermore, we would like to express our gratitude to Dogacan Yucel, Calvin Smith, and the entire van Berlo lab team for exposing us
to higher levels of research, supporting us with various advanced techniques, and evaluating and revising our work Finally, we would like to express our gratitude to Dr. Kragtorp for helping us with our study and serving as a mentor We are immensely appreciative of the special learning experiences that each of the aforementioned mentors has provided for us
Research involving non-human vertebrate subjects was conducted under the supervision of an experienced teacher/researcher and followed state and federal regulatory guidance applicable to the humane and ethical conduct of such research.
Bernard-Pierrot, I , Héroult, M , Lemaître, G , Barritault, D , Courty, J , & Milhiet, P E (1999) Glycosaminoglycans promote HARP/PTN dimerization Biochemical and Biophysical Research Communications, 266(2), 437–442 https://doi org/10 1006/bbrc 1999 1835
Chiong, M , Wang, Z V , Pedrozo, Z , Cao, D J , Troncoso, R , Ibacache, M , Criollo, A , Nemchenko, A , Hill, J A , & Lavandero, S (2011) Cardiomyocyte death: Mechanisms and translational implications Cell Death & Disease, 2(12), e244–e244 https://doi org/10 1038/cddis 2011 130
Cui, B , Zheng, Y , Sun, L , Shi, T , Shi, Z , Wang, L , Huang, G , & Sun, N (2018) Heart Regeneration in Adult Mammals after Myocardial Damage Acta Cardiologica Sinica, 34(2), 115–123 https://doi org/10 6515/ACS 201803 34(2) 20171206A
Czubryt, M P , & Hale, T M (2021) Cardiac fibrosis: Pathobiology and therapeutic targets Cellular Signalling, 85, 110066 https://doi org/10 1016/j cellsig 2021 110066
deAlmeida, A C , van Oort, R J , & Wehrens, X H T (2010) Transverse Aortic Constriction in Mice Journal of Visualized Experiments, 38, 1729 https://doi org/10 3791/1729
Liu, M , de Juan Abad, B L , & Cheng, K (2021) Cardiac fibrosis: Myofibroblast-mediated pathological regulation and drug delivery strategies Advanced Drug Delivery Reviews, 173, 504–519. https://doi.org/10.1016/j.addr.2021.03.021
Lu, K V , Jong, K A , Kim, G Y , Singh, J , Dia, E Q , Yoshimoto, K , Wang, M Y , Cloughesy, T F , Nelson, S F , & Mischel, P S (2005) Differential Induction of Glioblastoma
Migration and Growth by Two Forms of Pleiotrophin Journal of Biological Chemistry, 280(29), 26953–26964
https://doi org/10 1074/jbc M502614200
Nicin, L., Wagner, J. U. G., Luxán, G., & Dimmeler, S. (2022). Fibroblast-mediated intercellular crosstalk in the healthy and diseased heart FEBS Letters, 596(5), 638–654
https://doi org/10 1002/1873-3468 14234
Papadimitriou, E , Mourkogianni, E , Ntenekou, D , Christopoulou, M , Koutsioumpa, M , & Lamprou, M (2021) On the role of pleiotrophin and its receptors in development and angiogenesis
Sam Bae and William McNally
International Journal of Developmental Biology, 66(1-2–3), 115–124. https://doi.org/10.1387/ijdb.210122ep
Peters, S A E , Colantonio, L D , Dai, Y , Zhao, H , Bittner, V , Farkouh, M E , Dluzniewski, P , Poudel, B , Muntner, P , & Woodward, M (2021) Trends in Recurrent Coronary Heart Disease After Myocardial Infarction Among US Women and Men Between 2008 and 2017 Circulation, 143(7), 650–660 https://doi org/10 1161/CIRCULATIONAHA 120 047065
Rauvala, H. (1989). An 18-kd heparin-binding protein of developing brain that is distinct from fibroblast growth factors The EMBO Journal, 8(10), 2933–2941 https://doi org/10 1002/j 1460-2075 1989 tb08443 x
Roy, S , & Kornberg, T B (2015) Paracrine signaling mediated at cell-cell contacts: Insights & Perspectives BioEssays, 37(1), 25–33 https://doi org/10 1002/bies 201400122
Ruiz-Villalba, A , Romero, J P , Hernández, S C , Vilas-Zornoza, A , Fortelny, N , Castro-Labrador, L , San Martin-Uriz, P , Lorenzo-Vivas, E , García-Olloqui, P , Palacio, M , Gavira, J J , Bastarrika, G , Janssens, S , Wu, M , Iglesias, E , Abizanda, G , de Morentin, X M , Lasaga, M , Planell, N , Prósper, F (2020) Single-Cell RNA Sequencing Analysis Reveals a Crucial Role for CTHRC1 (Collagen Triple Helix Repeat Containing 1) Cardiac Fibroblasts After Myocardial Infarction. Circulation, 142(19), 1831–1847
https://doi org/10 1161/CIRCULATIONAHA 119 044557
Wang, X (2020) Pleiotrophin: Activity and mechanism In Advances in Clinical Chemistry (Vol 98, pp 51–89) Elsevier https://doi org/10 1016/bs acc 2020 02 003
The Effect of Artificial UVB Light on Vitamin D Levels in Boa imperators
Chloe Chu
Introduction
Reptile ownership has greatly increased over the past few years, going from 6 million to 9 4 million reptiles in homes from 2017-2020. Sadly, 75% of reptiles purchased from shops die within the first year of ownership (Cove, 2021) Clearly, there is a lot we don’t yet understand about how to keep reptiles alive and thriving. An example of this is whether or not to provide UVB lighting to captive snakes. Providing UVB to captive snakes is a controversial subject. Online posts and discussions provide conflicting recommendations, with little to no data backing up the assertions. Some keepers feel very strongly that snakes do need UVB to prevent metabolic bone disease, immune system deficiencies, and other health problems (Jill E. Maddison, 2015; Pet Reptiles Need Vitamin D and Calcium for Bone Health, n.d.; Understanding Metabolic Bone Disease in Reptiles - WCVM Today - Western College of Veterinary Medicine, n.d.; VetFolio, n.d.). Others argue that snakes do not have the same UVB requirements as lizards, because they receive all the nutrients they need from their diet (BackwaterReptiles, 2019; What Kind of Lights Does Your Pet Snake Need?, n d ) UVB bulbs often don’t include all of the wavelengths that natural light has, further making it questionable whether they provide any benefit when provided in captivity (Diehl et al., 2018).
The role of UVB light in the production of vitamin D and the physiological function of vitamin D in calcium regulation is a conserved process across many animal species, including reptiles (Hedley & Eatwell, 2013) UVB radiation (wavelengths 280-315 nm) converts 7-dehydrocholesterol, a naturally occurring cholesterol found in the skin, into previtamin

D3. Previtamin D3 is converted into cholecalciferol (vitamin D) through a temperature-sensitive isomerization (Hedley & Eatwell, 2013). Cholecalciferol then binds to the vitamin D binding protein, and is transported through the blood plasma to the liver (Hedley & Eatwell, 2013). In the liver, the cholecalciferol is converted to 25-hydroxyvitamin D3, the storage form of vitamin D (Hedley & Eatwell, 2013) When these stores are needed, 25hydroxyvitamin D is transported to the kidneys, where it is converted into 1,25-dihydroxyvitamin D3, the active form of vitamin D (Hedley & Eatwell, 2013) 1,25-dihydroxyvitamin D3 controls calcium levels in the bloodstream by allowing the gut to absorb dietary calcium and regulating calcium storage in the bones (Baines et al , 2017) Appropriate calcium levels are essential for proper muscle and nerve function, normal growth, and reproduction (Baines et al , 2017) If 1,25-dihydroxyvitamin D3 levels are too low, it can cause metabolic bone disease, a condition that results in low bone density, bending of the bones, and fractures (Mariah, 2020). When there is more 25-hydroxyvitamin D3 in the liver than needed by the kidneys, other organs can convert 25-hydroxyvitamin D3 into 1,25-dihydroxyvitamin D3 in their own cells. 1,25-dihydroxyvitamin D3 can control the expression of as many as 2,000 genes and is involved in many bodily functions, such as the immune system and cell division (Baines et al , 2017) Since the skin converts excess subcutaneous cholecalciferol into inert metabolites to prevent hypervitaminosis, extra UVB exposure does not result in excess 25-hydroxyvitamin D3 (Mariah, 2020).
The importance of UVB exposure in lizards is well established A comparison of UVB compact lamps in enabling vitamin D synthesis in
juvenile bearded dragons found that commercial lamps do not enable vitamin D synthesis to the level recorded in free-living bearded dragons exposed to natural sunlight, but still raise the vitamin D levels significantly when compared to unexposed lizards (Diehl et al , 2018) Female panther chameleons raised with mid-level long/low exposure to UVB produced a higher percentage of viable eggs with a higher percentage of hatching when compared to females raised with other levels and exposures of UVB (G Ferguson et al , 2002) Panther chameleons also behaviorally regulate vitamin D levels related to dietary intake of vitamin D by altering basking behaviors (G Ferguson et al , 2003). A study on the skin sensitivity to UVB of anoles showed a correlation between lower natural UVB exposure and higher sensitivity to UVB, along with the ability to synthesize higher levels of vitamin D (G W Ferguson et al , 2005) Although common, a strict requ irement for UVB is not universal across all lizard species, especially those of nocturnal nature Leopard geckos, a nocturnal species, can use UVB to synthesize vitamin D, but receive enough from their diet during the first six months of life to promote normal growth (Oonincx et al., 2020).
Although the processes of endogenous vitamin D synthesis are conserved across many vertebrate species and the benefit of UVB exposure in lizards is well established, little is known about the requirements for UVB in snake species. Snakes and reptiles see more wavelengths of light than humans do, which may indicate that they benefit from the ability to perceive those wavelengths (Baines et al., 2017; Mariah, 2020; Staff, 2011). The observation that reptiles are known to self-regulate the amount of UVB they receive through diet and sunlight exposure suggests a baseline need for UVB through sunlight exposure for those species (G Ferguson et al., 2003).
The question becomes even more complicated with nocturnal species (Hedley & Eatwell, 2013). It is often suggested that, since nocturnal snakes are not out during the day, they don’t
receive or require any UVB radiation. However, observations of voluntary exposure of different species of lizards and snakes to UVB radiation in the field that were used to develop the Ferguson zone scale, a guideline on how much UVB to provide to different reptiles in captivity, contradicts this (G. W. Ferguson et al., 2010). Species that are regarded to require high UVB and that are placed in Zone 4 as a “mid-day sun basker” are animals such as the Rhinoceros Iguana and Chuckwalla (G Ferguson et al , 2002) There are not any snake species in Zone 4, but diamond pythons and other snakes in the Morelia genus fall into Zone 3 (G W Ferguson et al , 2005) A crepuscular species, Pantherophis guttatus (corn snake), is placed in Zone 1 as “crepuscular or shade dweller” (G W Ferguson et al , 2010) This is a strange placement, since another study demonstrated that corn snakes show a significant increase in vitamin D concentration when exposed to UVB lighting (Acierno et al., 2008). The presence of this physiological process suggests they do not receive all of their required nutrients from their diet, and thus need the ability to endogenously synthesize vitamin D from UVB
The Ferguson Zones place the nocturnal species Boa constrictor and Boa imperator in Zone 2 as “partial sun or occasional basker” meaning that in the wild, they would be exposed to a moderate level of UVB radiation (G. W. Ferguson et al., 2010). If corn snakes require UVB to synthesize vitamin D, it would make logical sense that a species naturally exposed to more UVB might have a similar requirement. In addition, in Burmese pythons, another nocturnal species, vitamin D levels increase significantly with exposure to UVB lighting (Bos et al., 2018). However, in nocturnal ball pythons, vitamin D concentration and calcium metabolism does not significantly change before and after UVB exposure (Hedley & Eatwell, 2013) This contrast in data suggests the need for more research to ascertain the optimal husbandry for specific snake species, especially those that are nocturnal.
Chloe Chu
This study utilized eight snakes of the nocturnal species Boa imperator divided into one group of four snakes that were exposed to high levels of UVB and another group of four snakes exposed to significantly lower levels of UVB. The snakes were each housed in individual enclosures of an identical size and setup, with the same temperatures and humidities. All snakes were provided with the same UVB bulb, but a plexiglass sheet was placed beneath the bulbs of the control group to block some of the radiation. Both groups showed a significant increase in 25hydroxyvitamin D3 concentrations Individual levels of 1,25-dihydroxyvitamin D3 also increased for a few of the snakes, but the change did not reach significance within the groups The 25-hydroxyvitamin D3 levels after exposure to UVB were not significantly different between the low and high UVB level groups These results suggest that even a small amount of UVB can produce a significant increase in 25-hydroxyvitamin D3 levels, while exposure to higher levels of UVB can produce an even more significant increase in 25-hydroxyvitamin D3 levels, indicating a benefit of including UVB lighting in captive Boa imperator enclosures.
The snakes used in this study were sub-adult Boa imperators. Seven of the snakes were males and one of the snakes was female The species Boa imperator was chosen because of their manageable size and nocturnal behavior (“Boa Constrictor Care,” n d ; Boa Constrictor Care Guide and Bioactive Terrarium Maintenance, n.d.; BOA CONSTRICTOR Caresheet | Reptile Rapture, n d ) The snakes are all captive bred and were sourced from Boas Abound, Gypsy Exotics, Boa World, Black Brook Serpents, Bloodline Boas, Blakes Boas, Indian River Constrictors, and J&K Reptiles
The snakes were randomly divided into two groups of four snakes each, the experimental group that would be exposed to high levels of
artificial UVB and the control group that would be exposed to low levels of artificial UVB
After the initial four week quarantine, the experimental group was exposed to artificial UVB light using the Arcadia T5 12% desert dweller bulb system The control group was provided with the same UVB lamps, but some of the UVB wavelengths were blocked using a plexiglass sheet The hides of the snakes were turned upside down to allow for hiding spaces but maintain equal exposure opportunities to UVB The UVB radiation was measured for each enclosure from multiple points in the enclosure at different distances from the bulbs. The device used to measure the UVB output was the Solarmeter Model 6.2R which gives readings in µW/cm2.
Blood samples were taken by a licensed veterinarian to determine the plasma 25hydroxyvitamin D3 levels and 1,25- dihydroxyvitamin D3 levels. Blood samples were taken at the beginning of the study and then again at the end of the study, mimicking studies conducted by Acierno and Hedley & Etwell (Acierno et al., 2008; Hedley & Eatwell, 2013). The samples were sent to the veterinary diagnostic laboratory at Michigan State University. A radioimmunoassay was used to determine the levels of 25-hydroxyvitamin D3 (storage form) and 1,25-dihydroxyvitamin D3 (active form) in the blood serum samples.
To assess the behavioral and physiological effects of UVB light supplementation, the snakes’ lethargy levels were measured The lethargy testing took place at the beginning and end of the study. A pegboard was used and the percentage of time the snake’s head was moving was quantified by recording the trials using an iPhone 13. The snakes were placed on the top pegs and left on the board for 10 minutes During the trial, if at any point the snake's head left the camera frame, was no longer visible, or the snake was about to fall off of or leave t he board they were gently replaced in the frame or
on the board. Afterward, the recordings were analyzed for the percentage of time the snake's head was moving This was done by watching the video and marking the timestamps of the starts of periods of movement and the ends of periods of movement The total number of seconds in each period was totaled up and then divided by 600 to find the percentage of movement during the trial
Data was analyzed and two tailed t-tests were performed using Google Sheets and Excel spreadsheets.
The UVB levels in the enclosures of the high UVB exposure group were significantly higher than the UVB levels in the enclosures of the low UVB exposure group (t-test; top warm side p<0.0001, top cool side p<0.01, back center p<0 0001, front center p<0 001, directly below lamp p<0 0001; Table 1) Without the lamp on, UVB levels in all enclosures were zero at all points of placement (data not shown)
Table 1. Average levels of UVB radiation taken from multiple places in the enclosures
The blood serum concentration of 25hydroxyvitamin D3 (the storage form of Vitamin D) was measured in all eight snakes before and after exposure to UVB. All snakes in both groups had a higher blood serum level of 25-hydroxyvitamin D3 after UVB exposure than their level before UVB exposure (Table 2). The average 25-hydroxyvitamin D3 concentrations significantly increased for both groups after exposure, though the increase in the high UVB exposure group reached a higher level of significance than the low UVB exp osure group’s increase (high: p<0.01, low: p<0.05; Figure 3). There was no significant difference in 25-hydroxyvitamin D3 levels between the high UVB and low UVB groups either before exposure (p=0 278; Table 2) or after exposure (p=0 545; Figure 3)
Table 2. Individual 25-hydroxyvitamin D3 levels before and after UVB exposure for low (L) and high (H) exposure groups
Snake
25-hydroxyvitamin D3 (nmol/L) Before UVB After UVB
UVB Meter Placement
Average ± s.d. UVB exposure (µW/cm2 ) Unblocked UVB Blocked UVB
Top of Warm Side Hide 13 5±1 29 4±1 41
Top of Cool Side Hide 14 75±0 96 5 75±2 22
Back Center of Enclosure at Substrate Level 52±4 24 22 25±4 50
Front Center of Enclosure at Substrate Level 9 5±1 29 3 5±1 29
4 inches Below Center of Lamp 184±8 04 67 25±13 60

Figure 3. Average blood serum 25-hydroxyvitamin D3 concentrations (± s d ) before and after exposure to UVB by group in nmol/L
The blood serum concentration of 1,25-dihydroxyvitamin D3 (the active form of vitamin D) was measured in all eight snakes before and after exposure to UVB Three snakes, one low UVB exposure snake and two high UVB exposure snakes, had an increase in 1,25-dihydroxyvitamin D3 concentration after UVB exposure (Table 3), while the concentrations were lower after exposure for the rest of the snakes Average concentrations of 1,25-dihydroxyvitamin D3 were lower after exposure for both groups, though the change was not significant (p=0 315; Figure 4) There was no significant difference in 1,25-dihydroxyvitamin D3 concentrations between the groups either before (p=0 192) or after UVB exposure (p=0 198; Figure 4)
Table 3. Individual 1,25-dihydroxyvitamin D3 levels before and after UVB exposure for low (L) and high (H) exposure groups
Snake 1,25-dihydroxyvitamin D3 (nmol/L)

Figure 4. Average blood serum 1,25-dihydroxyvitamin D3 concentrations (± s d ) before and after UVB exposure by group in nmol/L
Activity level, as measured by the percent of time a snake’s head was in motion during a ten minute observation, was successfully assessed for six snakes before UVB exposure and for five snakes after UVB exposure. This assessment was not performed when snakes displayed highly reactive behavior, as this could alter the data and cause undue stress for the snake. One high exposure group snake and two low exposure group snakes had a higher activity level after exposure while the remaining snakes decreased or were not assessed (data not shown) The data (not shown) was representative of the difference in percentage between lethargy measurements as either an increase (+) or a decrease (-). The results did not suggest a difference between the low UVB exposure group and the high UVB exposure group but there was insufficient data for statistical analysis.
The goal of this research was to examine the relationship between artificial UVB light exposure and the vitamin D levels in Boa imperators, a nocturnal snake species The storage form of vitamin D3 (25-hydroxyvitamin D3) increased in both the low UVB exposure and high UVB exposure groups However, the change reached a higher level of significance in the high UVB exposure group snakes. The levels of the active form of vitamin D3 (1,25dihydroxyvitamin D3) did not change significantly. Although the activity level
measurements were not able to be performed on all snakes, preliminary trends don’t suggest a difference between the two groups The data suggests a possible benefit of providing artificial UVB light to Boa imperators, but more research needs to be conducted
Limitations
It was expected that the 25-hydroxyvitamin D3 levels, but not 1,25-dihydroxyvitamin D3, would change, since it is typically documented in humans that the storage form of vitamin D3 is not as tightly controlled as 1,25-dihydroxyvitamin D3 (Holick, 2009; Hurst et al., 2020; Major et al , 2013) 25-hydroxyvitamin D3 can be influenced by outside variables and is considered the best indicator of changes in vitamin D status (Holick, 2009; Hurst et al , 2020; Major et al , 2013) However, it was surprising that the 1,25-dihydroxyvitamin D3 levels measured before and after UVB exposure were quite different for each snake 1,25-dihydroxyvitamin D3 levels typically do not change in relation to outside variables, such as sunlight exposure, as the levels are regulated by parathyroid hormone levels (Don’t Routinely Measure 1,25-dihydroxyvitamin D Unless the Patient Has Hypercalcemia or Decreased Kidney Function., n.d.). In humans and other vertebrate species, 1,25-dihydroxyvitamin D3 levels change in relation to illness but otherwise usually maintain a very stable range (Hurst et al., 2020) 1,25-dihydroxyvitamin D3 levels are also not known to change in relation to 25hydroxyvitamin D3 levels (Holick, 2009; Hurst et al , 2020; Major et al , 2013) It is unclear why the pre-UVB and post-UVB 1,25-dihydroxyvitamin D3 levels were different in the snakes of this study It is unlikely that the change is due to illness since the snakes were regularly examined by a veterinarian. Little is known about the appropriate ranges of 25-hydroxy- vitamin D3 and 1,25-dihydroxyvitamin D3 concentrations in reptiles, specifically snakes. Therefore, it is difficult to tell whether the results of the study are within a healthy range, or if the fluctuation of 1,25-dihydroxyvitamin D3 is normal.
Inconsistent concentrations of either 25hydroxyvitamin D3 or 1,25-dihydroxyvitamin D3 could also be caused by the type of analysis used. Different methods of measuring vitamin D can have a variability between 15-20%, making obtaining accurate results difficult (Dealing with Vitamin D Assay Variability, n.d.; Major et al., 2013; Stokes et al , 2018) This study used a radioimmunoassay to measure vitamin D levels, as it is the most readily available and cost efficient method of measurement Although 90% of the tests run to detect vitamin D use radioimmunoassays (RIA), there are many complications that arise when using this type of assay (Dealing with Vitamin D Assay Variability, n.d.; Major et al., 2013; Stokes et al., 2018) Currently, vitamin D levels are reported without distinguishing between protein bound, albumin bound, and unbound metabolites, which can have an effect on the accuracy of the measurement since the balance may change with different health conditions (Dealing with Vitamin D Assay Variability, n d ; Major et al , 2013; Stokes et al , 2018) Liquid chromatography-tandem mass spectrometry (LC-MS) is accepted as the gold standard and most accurate measurement technique for vitamin D, as it is able to differentiate between the different epimers and metabolites of vitamin D as well as account for protein bound and unbound molecules (Dealing with Vitamin D Assay Variability, n d ; Major et al , 2013; Stokes et al , 2018)
Another limitation in drawing conclusions from this study is the observation that both the low UVB and high UVB exposed groups had an increase in 25-hydroxyvitamin D3. There are a couple of possible explanations for this. Most of the snakes arrived underweight and reached a healthy weight over the experimentation period (healthy weights were verified by the veterinarian), so it is possible that at least part of the increase in 25-hydroxyvitamin D3 levels was caused by an initial deficiency followed by a rise back to “normal ” Another potential factor in this experiment was that the plexiglass sheet did not fully block out the UVB rays. The snakes in the low UVB exposure group were meant to be
exposed to no UVB radiation. To limit other variables such as heat and visible light exposure, all snakes were provided with the same UVB lamp and the minimal exposure to UVB was initially deemed acceptable in the control group However, if the low UVB exposure group had not been exposed to any UVB radiation, it would have allowed for a better analysis of the specific effect of UVB on the snakes It is important to note that while both groups increased in 25-hydroxyvitamin D3 concentration, the increase of the high UVB exposure group did increase at a higher significance value than the low UVB exposure group Thus, even if diet was a factor, this still may suggest that the higher UVB exposure still played a role in increasing production of 25-hydroxyvitamin D3
Another major limiting factor in this experiment was the small sample size. Small sample size reduces the power of statistical analysis and limits the conclusions that can be made, since other differences between the snakes could have an outsized effect on the results. For example, only one of the snakes was female It is unknown whether gender differences would affect the blood serum levels of vitamin D or the usage of UVB to produce vitamin D in snake species (Hedley & Eatwell, 2013). The snakes were not from the same clutch or breeder and, though they were all similar ages, they were not the exact same age. Different life stages could account for different vitamin D requirements and thus different blood serum levels and/or different abilities to utilize UVB (Hedley & Eatwell, 2013; Oonincx et al., 2020).
In future research, more snakes should be used to decrease the likelihood of statistical inaccuracies, with a longer pre-trial period to ensure all snakes’ weights were stable prior to experimentation. Increasing blocking of UVB in the control group, or even testing multiple levels of UVB exposure could also clarify whether any changes in circulating or storage levels are directly due to UVB exposure A longer experimental time frame could also be utilized to measure changes over different seasons or even
over the course of a snake's lifetime. Gender controlled studies could examine the differences between male and female snakes’ vitamin D requirements and whether gender affects the ability to endogenously synthesize vitamin D using UVB light Future research could also examine multiple species of snakes to allow for interspecific comparisons and generalizations Different species inhabit areas with varying levels of sunlight exposure which could cause physiological changes based around adapting to vitamin D, calcium, and UVB needs Thorough research on crepuscular, diurnal, and nocturnal snake species is required to understand the differences in vitamin D and UVB requirements
This research represents an important step towards understanding physiological functions in snakes in order to better care for them. It suggests that snakes can produce vitamin D from minimal UVB exposure and that high UVB exposure produces an even more significant increase in concentrations of the storage form of vitamin D This potentially indicates a requirement for endogenously synthesized vitamin D and, thus, UVB light, beyond what is supplied by the diet The results of this study contribute to a greater pool of knowledge of snake physiology, husbandry, and conservation It is the hope of this author that this work can be expanded upon to further deepen our understanding of snakes
I would like to thank Dr Jaime Nalezny for her veterinary expertise and time taken to provide me with advice and assistance I want to thank my research advisor and teacher Dr Kati Kragtorp for giving me the opportunity to explore the field of reptile physiology and for her endless encouragement and invaluable feedback. Finally, I would like to thank my Advanced Science Research classmates and my family
Acierno, M J , Mitchell, M A , Zachariah, T T , Roundtree, M K., Kirchgessner, M. S., & Sanchez-Migallon Guzman, D. (2008). Effects of ultraviolet radiation on plasma 25-hydroxyvitamin D3 concentrations in corn snakes (Elaphe guttata) American Journal of Veterinary Research, 69(2), 294–297 https://doi org/10 2460/ajvr 69 2 294
BackwaterReptiles (2019, August 19) Do Pet Snakes Require UV Lighting? Backwater Reptiles Blog https://backwaterreptilesblog.com/do-pet-snakes-require-uv-lightin g/
Baines, F M , M A , VetMB, & MRCVS (2017, January 11) An In-Depth Look At UV Light And Its Proper Use With Reptiles Reptiles Magazine https://reptilesmagazine com/an-in-depth-look-at-uv-light-and-its-p roper-use-with-reptiles/
Boa Constrictor Care. (n.d.). ReptiFiles®, LLC. Retrieved December 6, 2021, from https://reptifiles com/boa-constrictor-care/
Boa Constrictor Care guide and bioactive terrarium maintenance (n d ) The Bio Dude Retrieved December 6, 2021, from https://www thebiodude com/blogs/reptile-and-amphibian-careshee ts-with-cited-veterinary-and-herpetology-sources/boa-constrictor-c are-guide-and-bioactive-terrarium-maintenance
BOA CONSTRICTOR Caresheet | Reptile Rapture. (n.d.). Retrieved December 6, 2021, from https://reptilerapture net/boa-constrictor-caresheet html
Bos, J H , Klip, F C , & Oonincx, D G A B (2018)
ARTIFICIAL ULTRAVIOLET B RADIATION RAISES
PLASMA 25-HYDROXYVITAMIN D3 CONCENTRATIONS IN BURMESE PYTHONS ( PYTHON BIVITTATUS) Journal of Zoo and Wildlife Medicine: Official Publication of the American Association of Zoo Veterinarians, 49(3), 810–812 https://doi org/10 1638/2017-0243 1
Cove, R (2021, January 31) A Report on Reptile Pet Ownership in The United States | Reptiles’ Cove https://reptilescove com/featured/a-report-on-reptile-pet-ownership -in-the-united-states
Dealing with Vitamin D Assay Variability. (n.d.). Clinical Lab Manager Retrieved May 6, 2022, from https://www clinicallabmanager com/trends/clinical-chemistry/deali ng-with-vitamin-d-assay-variability-23721
Diehl, J J E , Baines, F M , Heijboer, A C , van Leeuwen, J P , Kik, M , Hendriks, W H , & Oonincx, D G a B (2018) A comparison of UVb compact lamps in enabling cutaneous vitamin D synthesis in growing bearded dragons. Journal of Animal Physiology and Animal Nutrition, 102(1), 308–316 https://doi org/10 1111/jpn 12728
Don’t routinely measure 1,25-dihydroxyvitamin D unless the patient has hypercalcemia or decreased kidney function (n d ) Retrieved January 9, 2023, from https://www aafp org/pubs/afp/collections/choosing-wisely/140 ht ml
Ferguson, G , Gehrmann, W , Chen, T C , Dierenfeld, E , & Holick, M (2002) Effects of Artificial Ultraviolet Light Exposure on Reproductive Success of the Female Panther Chameleon (Furcifer pardalis) in Captivity https://doi org/10 1002/ZOO 10054
Ferguson, G , Gehrmann, W , Karsten, K B , Hammack, S H , McRae, M , Chen, T -C , Lung, N P , & Holick, M (2003) Do
Panther Chameleons Bask to Regulate Endogenous Vitamin D3 Production? Physiological and Biochemical Zoology. https://doi org/10 1086/374276
Ferguson, G W , Brinker, A M , Gehrmann, W H , Bucklin, S E , Baines, F M , & Mackin, S J (2010) Voluntary exposure of some western-hemisphere snake and lizard species to ultraviolet-B radiation in the field: How much ultraviolet-B should a lizard or snake receive in captivity? Zoo Biology, 29(3), 317–334 https://doi.org/10.1002/zoo.20255
Ferguson, G W , Gehrmann, W H , Karsten, K B , Landwer, A J , Carman, E N , Chen, T C , & Holick, M F (2005) Ultraviolet exposure and vitamin D synthesis in a sun-dwelling and a shade-dwelling species of Anolis: Are there adaptations for lower ultraviolet B and dietary vitamin D3 availability in the shade? Physiological and Biochemical Zoology: PBZ, 78(2), 193–200 https://doi org/10 1086/427055
Hedley, J , & Eatwell, K (2013) The effects of UV light on calcium metabolism in ball pythons (Python regius) The Veterinary Record, 173(14), 345 https://doi org/10 1136/vr 101555
Holick, M F (2009) VITAMIN D STATUS: MEASUREMENT, INTERPRETATION AND CLINICAL APPLICATION Annals of Epidemiology, 19(2), 73–78 https://doi org/10 1016/j annepidem 2007 12 001
Hurst, E A , Homer, N Z , & Mellanby, R J (2020) Vitamin D Metabolism and Profiling in Veterinary Species Metabolites, 10(9), 371 https://doi org/10 3390/metabo10090371
Jill E Maddison, Bvs (2015) World Small Animal Veterinary Association World Congress Proceedings, 2008 VIN Com http://www vin com/doc/?id=6696755
Major, J M , Graubard, B I , Dodd, K W , Iwan, A , Alexander, B H , Linet, M S , & Freedman, D M (2013) Variability and Reproducibility of Circulating Vitamin D in a Nationwide U S Population The Journal of Clinical Endocrinology and Metabolism, 98(1), 97–104 https://doi org/10 1210/jc 2012-2643
Mariah (2020, May 30) Essay: Why All Pet Reptiles Need UVB Light ReptiFiles®, LLC https://reptifiles.com/reptile-uvb-light-necessity/
Oonincx, D G A B , Diehl, J J E , Kik, M , Baines, F M , Heijboer, A C , Hendriks, W H , & Bosch, G (2020) The nocturnal leopard gecko (Eublepharis macularius) uses UVb radiation for vitamin D3 synthesis Comparative Biochemistry and Physiology Part B: Biochemistry and Molecular Biology, 250, 110506 https://doi org/10 1016/j cbpb 2020 110506
Pet Reptiles Need Vitamin D and Calcium for Bone Health (n d ) College of Agricultural, Consumer & Environmental Sciences Retrieved December 3, 2021, from https://aces illinois edu/news/pet-reptiles-need-vitamin-d-and-calci um-bone-health
Staff, S (2011, December 1) The Other Kind Of Reptile Light: Sunlight Reptiles Magazine https://reptilesmagazine.com/the-other-kind-of-reptile-light-sunligh t/
Stokes, C S , Lammert, F , & Volmer, D A (2018) Analytical Methods for Quantification of Vitamin D and Implications for Research and Clinical Practice Anticancer Research, 38(2), 1137–1144
Understanding metabolic bone disease in reptiles WCVM Today Western College of Veterinary Medicine. (n.d.). WCVM Today Retrieved December 3, 2021, from https://wcvmtoday usask ca/articles/2019/09/Understanding-metab olic-bone-disease-in-reptiles php
VetFolio (n d ) Retrieved December 3, 2021, from https://www vetfolio com/learn/article/diet-supplementation-in-rept iles-prevention-and-treatment-of-common-disorders
What Kind of Lights Does Your Pet Snake Need? (n.d.). The Spruce Pets Retrieved December 3, 2021, from https://www thesprucepets com/snake-lights-1239471
Noah DeMichaelis
Introduction
Reading is an essential skill for a successful future, so falling behind is catastrophic for both the individual and society as a whole. The social ills of illiteracy emerge in a variety of ways, some seemingly unintuitive. For instance, crime is significantly associated with illiteracy: 85 percent of juvenile delinquents are functionally illiterate (The Economic & Social Cost of Illiteracy, 2018). Additionally, illiteracy can impact health, since illiteracy limits a person’s ability to understand health information and increases the likelihood of high-risk sexual behaviors (The Economic & Social Cost of Illiteracy, 2018). Furthermore, the negative consequences of illiteracy are not strictly personal but can have large cumulative effects on society. According to a 2018 report from The World Literacy Foundation Illiteracy costs the global economy 800 billion pounds (965 billion dollars) a year (The Economic & Social Cost of Illiteracy, 2018).
Despite the impact of reading ability on future success and social well-being, many struggling students never receive the help they need. Only 35 percent of fourth-grade students in the United States scored as proficient in reading, as of 2019 Despite substantial evidence to guide effective reading programs, often implementation is lacking Insufficient allocation and dedication of funds frequently leave otherwise effective programs lacking the resources to be effective (Hollands et al , 2016) However, money is not the only barrier. Education programs also require training and time to be effective For these reasons, an ideal form of educational intervention would have to be easy to implement, cost-effective, and require little extra training

Research indicates a powerful association between rhythmic skills and pre-literacy
While the association between the pitch-related capabilities and reading related skills is unclear, the opposite is true for synchronization related skills. Research suggests that a synchronization-based assessment offers an effective means of early detection of future reading difficulties, while rhythm-based education represents a potential remedy (Bonacina et al , 2021) Contrary to popular conception, musicality is not innate. Synchronization ability improves with practice (Thompson et al , 2015) Musical training enhances auditory-motor development improving synchronization ability and is associated with superior reading ability (Steinbrink et al., 2019). The benefits are most pronounced in underserved populations. Music education was associated with superior maintenance and improvement of grade-level reading performance in students of low-socioeconomic backgrounds (Slater et al , 2014). For these reasons, reading education that utilizes music shows its appeal. Supporting reading skills by making music is free, fun, accessible, culturally ubiquitous, and most importantly, effective (Kraus & Chandrasekaran, 2010)
The Rock ‘n’ Read Project is a Minnesota-based nonprofit founded to use the power of musical training to help underserved students learn to read On the understanding that musical ability can be taught and that it presents benefits in other academic areas, The Rock ‘n’ Read Project retrofitted city buses to include computers with Tune Into Reading, a music-based educational software, to teach students to read through musical intervention Through working with the
program, participants saw significant gains in reading ability (Rocknreadproject Org/RealResults, n d ) Motivated by such notable results, the organization decided to take their work even further and launched the “Zap the Gap'' campaign Through their campaign, The Rock ‘n’ Read Project is placing emphasis on musical ability at very young ages (prenatal to 5 years old), arguing that addressing current shortfalls in reading ability through musical training can prevent deficits from becoming more pronounced over time To aid in this effort, The Rock 'n’ Read Project produced an accessible, holistic measure of musical fitness in the form of a free Musical Fitness Assessment (Musical Fitness Assessment, n.d.) The Musical Fitness Assessment measures proficiency in beat synchronization, synchronization with a song, syllable identification, matching a pitch, and singing in tune This assessment provides a simple, standardized measure of musical ability intended to help parents and teachers assess students’ musical capabilities
Currently, research into the benefits of music education either focuses explicitly on at-risk populations or does not intentionally test populations with exceptionally high educational access. What has not been explored are the benefits of musical exposure among students with greater general access to educational and economic resources. If there are measured benefits to musical education even among a more privileged population, then we could control for the possibility that increased attention, regardless of musical focus, is the cause of improved reading ability
The population tested in this study represents a natural case study to identify spontaneously occurring trends regarding the efficacy of musical education in promoting musical fitness and phonemic awareness. Students enrolled at Breck School in Golden Valley, MN receive a music education at each grade level, therefore many students will have received a formal music education in school Furthermore, as an independent school that tends to represent a population with greater access to resources, it is
likely that many participants will have received some formal musical education outside of school or before or while attending Breck Because of this, it has had a population with a diverse range of musical histories but with a baseline of musical experience from attending music classes at Breck. Furthermore, because Breck offers superb educational resources, this controls for the possibility that increased attention, regardless of musical focus, could contribute to differing phonemic ability Testing a population with varied musical education coupled with substantial educational resources enabled investigation of whether early music education, specifically, is linked with greater phonemic ability. Another question explored in this research is the impact that the timing of music introduction has on the relationship between musical ability and reading proficiency. It is common knowledge among musicians that those who begin early tend to be better players, but what has not been shown is if early musical training would also correlate with reading abilities
Three sets of data were used to investigate the association between musical proficiency and reading readiness: a survey on each participant’s past musical training before and after kindergarten, an assessment of their musical skills, and their most recent phonemic ability scores.The survey included other relevant questions including years at Breck School, current age, and amount and types This was coupled with an assessment of musical skills and an assessment of phonemic awareness. The Musical Fitness Assessment, developed by the Rock ‘n’ Read program, covered skills including synchronization to a beat, syllable perception with a song, and singing in tune Phonemic awareness scores were positively correlated with Musical Fitness Assessment scores. However, it was pitch and syllable perception, and not synchronization, that largely contributed to this correlation. Music education experience correlated with higher Musical Fitness Assessment scores, but not with phonemic awareness scores. This was due to a stronger
correlation between musical education and synchronization skills, rather than with pitch
Despite the strong association between synchronization skills and reading/pre-reading characteristics, there has been less research into a similar relationship between pitch matching and pitch contour perception. The research into this association that does exist is either contradictory or indicates a more limited association. Even within the same study, among the two groups measured (third graders and preschool students), pitch perception only correlated with phonemic awareness (the ability to use and manipulate speech sounds) in the younger group, while rhythmic skills remained the strongest predictor of phonological and phonetic awareness (the ability to use and manipulate sounds in spoken language) among both groups (Steinbrink et al., 2019). Both phonological and phonetic awareness are important literacy/pre-literacy skills and contribute to reading ability. This indicates that the associations between pitch perception and literacy, if present, might only emerge in certain age ranges. A study of young adults, ages 1924, suggested an association between pitch contour perception and phonological skills (Foxton et al., 2003). Interestingly, students diagnosed with developmental dyslexia had impaired absolute pitch perception and pitch contour perception. Among the tested dyslexic population both types of pitch perception correlated with reading skills, however, no such association was demonstrated in the non-dyslexic control group (Ziegler et al., 2012).
The research participants were first-grade students (ages 6-7) from Breck School in Golden Valley, MN Breck School is a suburban, independent, pre-K through grade 12 college preparatory school This study represented an age, gender, and racial/ethnic composition representative of the first-grade student body at this institution This study did not include any otherwise-listed vulnerable populations An
introductory email containing a link to an online Google Form survey was sent to all parents/guardians of 2022/23 first-grade students at Breck School in the fall of 2022, inviting them to participate in the study
Beginning with the consent and assent forms, the survey asked for information about their children, including years at Breck School, current age, and the amount and type(s) of musical education before and after kindergarten
Parents of first-grade participants were asked to state if their child had ever received any formal musical education, either in or out of school If parents selected “no”, the survey moved to ask about the participant's history with Breck. Next, the survey asked if participants had ever received a formal musical education before kindergarten Following an answer, the survey asked what types of education each participant had received before kindergarten Options included “lessons for a specific instrument or voice lessons,” “A general music program where parents/guardians and a child participate together,” “preschool with designated music times,” and an option for free response On the same page, parents were asked to list specific programs their child had participated in. Next, the survey asked the same questions in quotations except in reference to their participant’s past musical education since beginning kindergarten. Subsequently, the parents of the participants were asked about the grade when their participant first came to Breck Lastly, the survey asked the participant’s current age After parents/guardians concluded the survey, the data was anonymized by a faculty member and paired with an audio recording of their participant performing the Musical Fitness Assessment described below
Each first-grade participant was administered the Rock ‘n’ Read Basic Musical Fitness Assessment (Musical Fitness Assessment, n.d.). The Musical Fitness Assessment was produced by Rock ‘n’ Read, a nonprofit organization from Minnesota, as an aid for educators to determine
musical proficiency for young children. Participants were tested individually during scheduled music class time or during scheduled morning meeting time by a faculty member at the school with musical training The musical assessment asked participants to perform the following tasks: patting in synchronization to a metronome set to 120 beats per minute (bpm), consistently patting the beat while singing “Twinkle Twinkle Little Star,” clapping the syllables of "Twinkle Twinkle Little Star,” vocally matching pitch (F above middle C), and singing “Twinkle Twinkle Little Star” in tune, starting on middle C For the rhythm portion of the assessment, participants patted the beats on their lap, as a tactile stimulus was shown to improve rhythmic ability in students (Kuhlman & Schweinhart, 1999) All results were scored on a yes/no, or 1/0, basis. A yes (1) was only assigned if the participant performed the skill completely and accurately Scores were assigned both during the testing and, as testing sessions audio was recorded and re-assessed a second time for accuracy Singing in tune was assessed both locally (participants sang correct intervals with respect to the starting note) and globally (participants sang intervals that were consistent with each other). To protect anonymity, the scores were de-identified prior to being provided to me for analysis
Reading readiness test scores were collected from preexisting testing data for each participant gathered by the Breck Lower School reading specialist as a regular part of the Breck first-grade curriculum The test used was the Heggerty Guidelines for Scoring the 1st Grade Baseline Phonemic Awareness Assessment (The National Reading Panel Report, 2000) This phonemic awareness assessment covers the following phonemic skills: rhyme production, onset fluency, blending phonemes, isolating final sounds, segmenting words into phonemes, isolating medial sounds, adding additional phonemes, deleting additional phonemes, substituting initial phonemes. Test data from participating participants was anonymized by a
faculty member, who assigned each participant’s data to the number associated with musical assessment and survey data
Survey data was combined with Musical Fitness Assessment data and Phonemic Awareness Assessment scores for statistical analysis. Pairwise comparison between individual phonemic awareness component scores, Musical Fitness Assessment component scores, and survey responses was performed in MatLab (MATLAB, 2010), using Mann-Whitney U Test Pearson Correlation Coefficients between overall Phonemic Awareness Assessment scores, Musical Fitness Assessment overall, and skill-specific scores were combined with survey data responses and calculated using Excel (Microsoft)
A total of 29 first-grade participants participated in this study The participants ranged in age from six to seven years old. Of the 29 participants, 20 reported in-school music education as preschoolers, 14 reported extracurricular music education as preschoolers, 28 reported in-school music education since kindergarten, and nine reported extracurricular music education since kindergarten (Table 1). 13 participants reported participation in a general music program with parent or guardian participation before starting kindergarten, five participants reported participation in a general music program without parent or guardian participation before kindergarten, while one participant reported taking lessons for a specific instrument or voice lessons before kindergarten Since beginning kindergarten, three participants reported participation in a general music program for children without parent/guardian participation, while seven participants reported participation in voice or instrument lessons
Table 1. Summary of Music Experience Survey for the 29 participants.
Type of Musical Experience
Number Reporting Experience
Preschool music 20 (69%)
Preschool extracurricular music 14 (48%)
Kindergarten music 28 (97%)
Kindergarten extracurricular music 9(31%)
Musical Fitness Assessment Results
The Musical Fitness Assessment required participants to perform five musical tasks: synchronize to a beat, synchronize with a song, detect syllables in a song, match pitch, and sing a song in tune. Within singing a song in tune, participants were scored on both local and global pitch perception, giving a maximum possible score of six. The average score was 2.9 (±1.7), with only one participant achieving all six and four participants unable to perform any of the skills assessed. Most participants were able to synchronize to a beat (62%) and synchronize to a beat with a song (51%), match a pitch (58%), and detect the syllables within a song (62%). On the other hand, only 21% of participants were able to sing in tune To sing in tune globally participants must increase and decrease pitch appropriately with the song, while singing in tune locally involves matching the notes exactly, based on the starting pitch. Relatively few participants were able to sing in tune locally (20%), while more were able to sing in tune globally (34%; Table 2).
Heggerty Phonemic Awareness Assessment Results
Heggerty Phonemic Awareness Assessment test scores were collected from preexisting testing data for each participant Each of the 11 sections consisted of five questions relating to each phonemic skill, giving participants a score out of five for each skill (Table 3) The average performance on the Heggerty Phonemic Awareness Assessment was 41.3 out of 45.
Table 2. Summary of Music Experience Survey for the 29 participants.
Type of Musical Skill
Number of Participants Successfully Demonstrating the Skill (%)
Synchronization 18 (62%)
Synchronization with a Song 15 (51%)
Syllable Perception with a Song 18(62%
Pitch Matching 28 (97%)
In Tune Local 9(31%)
In Tune Global 10 (34%)
Table 3. Summary of Heggerty Phonemic Awareness Assessment section scores and standard deviations for 29 participants
Phonemic Skill
Average (± s.d) Section Score out of 5
Blending Syllables 4 86 (± 52)
Segmenting Syllables 4.27 (± 1.28)
Rhyme Production 4 31 (± 89)
Onset Fluency 4 69 (± 60)
Blending Phonemes 4 72 (± 65)
Isolating Final Sounds 4.83 (± .38)
Segmenting Words into Phonemes 4.62 (± .73)
Isolating Final Sounds 4.31 (± 1.3)
Adding Initial Phonemes 4 62 (± 1 0)
Deleting Initial Phonemes 4 31 (± 1 1)
Pairwise Comparisons
A Mann-Whitney U-Test was used to compare the differences in total and component Heggerty scores between participants, grouped by who could or could not perform each of the six components of the Musical Fitness Assessment, as well as the total and component Heggerty scores for groups of participants with and without preschool music education. None of the groups separated by either performance of a specific musical skill or by the experience of
preschool music education were significantly different in either component or total Heggerty scores (data not shown)
Pearson correlation coefficients were calculated by comparing different musical skills combined with the total Heggerty score. Among the compared characteristics, there was no significant correlation between age of attending Breck and Heggerty Score (r = 0.157), or age of attending Breck and Musical Fitness Assessment Score (r = 0 130)
There was a significant positive correlation (r = 0.383) between participants’ total Heggerty scores and total Musical Fitness Assessment scores (p<0.05; Figure 1).

Figure 1. Total Heggerty Score vs Total Musical Fitness Assessment Score
Although there was a moderate positive correlation between total Heggerty score and total pitch score (r = 0 366), the relationship did not reach statistical significance (p = 0 051; Figure 2).

2. Total Heggerty Score vs. Total Pitch Score
There was no significant correlation between total Heggerty Score and total Synchronization score (r = 0.88; p = 0.65). There was a positive correlation between total Heggerty Score and the combined Pitch and Syllable scores (r = 0 441) that did reach statistical significance (p<0.01; Figure 3).

Figure 3. Heggerty Score vs. Musical Fitness Pitch + Syllables Score
There was a positive correlation between Musical Fitness Assessment score and Level of Musical Exposure (r = 0 383), that did reach significance (p<0.05; Figure 4).
Noah DeMichaelis

Figure 4. Level of Musical Exposure vs. Total Musical Fitness Score
There was no significant correlation between total Heggerty Score and Level of Musical Exposure (r = 0.005; p = 0.98) or between total Pitch Score score and Level of Musical Exposure (r = 0 340; p = 0 71)
There was a positive correlation between Level of Musical Exposure and Total Synchronization score (r = 0 388) that did reach significance (p<0.05); Figure 5).

Figure 5. Level of Musical Exposure vs Total Synchronization Score
Discussion
Although there was a correlation between musical fitness and reading readiness, pitch perception and syllable awareness had the highest correlation with phonemic awareness in this study. Early exposure to music education appeared to support improved musical fitness; however, this was due to the association between
increased early musical education and synchronization, while no such association was seen with pitch-related skills T his is likely why no association between musical exposure and phonemic awareness was noted Exposure to music education was only linked with synchronization, not pitch, while only pitch, and not synchronization, was linked with phonemic awareness
Reading readiness in this study was only assessed through the metric of phonemic awareness, which relies heavily on a student’s ability to listen to and discriminate sounds, similar to pitch-related skills. Performance on an alternate reading assessment, looking at skills other than phonemic awareness, might show a better correlation with the synchronization components of the Musical Fitness Assessment and, consequently, with exposure to early music education. Alternatively, pitch-related skills could relate to phonemic ability at a first grade age, while synchronization will develop a stronger correlation with reading at later ages, as was reported in other research (Steinbrink et al , 2019).
The results reported in this investigation are limited to a small sample population that is receiving an independent school education, although it does show trends consistent with similar studies in larger, more diverse populations (Slater et al., 2014). This provides support for a robust connection between musical proficiency and phonemic ability, even among a more privileged population. Furthermore, participants ranged from six to seven years old, so the results are limited to students within that age range. Lastly, this investigation only reports correlations between different musical proficiency, extent of musical exposure, and phonemic awareness, and does not necessarily show a causal link between each characteristic.
In future research, it will be especially interesting to investigate how associations with different musical areas (pitch versus synchronization) and reading proficiency evolve as our tested population matures or as new participants are added. Future research is
currently being planned to follow this cohort to see if the trends observed in this study continue as this cohort moves beyond phonemes into learning to read, as well as incorporate assessments that test reading-associated skills other than just phonemic awareness It may also be worthwhile to investigate whether increased pitch training could improve phonemic awareness, especially among the participants with the lowest scores on the Heggerty Phonemic Awareness Assessment
These results contribute to the growing body of research supporting a strong link between reading skills and musical ability and extend that association even to students with a high level of access to resources. This investigation provides specific support for an association between pitch-related skills and phonemic ability in early elementary-age students. Musical exposure at early ages does seem to support synchronization-related skills, which may still prove important in later reading proficiency. More research should be conducted into the association between reading and pitch, not just synchronization. Such research could provide deeper insights into how music relates to reading and the best ways to support all students learning to read regardless of access or ability.
I want to thank Ms Ann Kay, and Dr Kati Kragtorp, for helping me through this research project with guidance, advice, and support.
Bonacina, S , Krizman, J , White-Schwoch, T , & Kraus, N (2018) Clapping in time parallels literacy and calls upon overlapping neural mechanisms in early readers: Clapping in time parallels literacy Annals of the New York Academy of Sciences, 1423(1), 338–348 https://doi org/10 1111/nyas 13704
Bonacina, S , Krizman, J , White-Schwoch, T , Nicol, T , & Kraus, N (2021) Clapping in Time With Feedback Relates Pervasively With Other Rhythmic Skills of Adolescents and Young Adults Perceptual and Motor Skills, 128(3), 952–968. https://doi org/10 1177/00315125211000867
Foxton, J M , Talcott, J B , Witton, C , Brace, H , McIntyre, F , & Griffiths, T D (2003) Reading skills are related to global, but not local, acoustic pattern perception Nature Neuroscience, 6(4), 343–344 https://doi org/10 1038/nn1035
Hollands, F M , Kieffer, M J , Shand, R , Pan, Y , Cheng, H , & Levin, H. M. (2016). Cost-Effectiveness Analysis of Early Reading Programs: A Demonstration With Recommendations for Future Research Journal of Research on Educational Effectiveness, 9(1), 30–53 https://doi org/10 1080/19345747 2015 1055639
Https://www rocknreadproject org/real-results (n d ) Rock “n” Read Project https://www rocknreadproject org/real-results
Kraus, N , & Chandrasekaran, B (2010) Music training for the development of auditory skills. Nature Reviews Neuroscience, 11(8), 599–605 https://doi org/10 1038/nrn2882
Kuhlman, K , & Schweinhart, L J (1999) Timing in Child Development High/Scope Educational Research Foundation
MATLAB (version 7 10 0 (R2010a)) (2010) The MathWorks Inc Musical Fitness Assessment. (n.d.). Rock “n” Read Project. Retrieved May 27, 2022, from https://www rocknreadproject org/musical-fitness-assessment
Slater, J , Strait, D L , Skoe, E , O’Connell, S , Thompson, E , & Kraus, N (2014) Longitudinal Effects of Group Music Instruction on Literacy Skills in Low-Income Children PLoS ONE, 9(11), e113383 https://doi org/10 1371/journal pone 0113383
Steinbrink, C., Knigge, J., Mannhaupt, G., Sallat, S., & Werkle, A. (2019) Are Temporal and Tonal Musical Skills Related to Phonological Awareness and Literacy Skills? – Evidence From Two Cross-Sectional Studies With Children From Different Age Groups Frontiers in Psychology, 10, 805 https://doi org/10 3389/fpsyg 2019 00805
The Economic & Social Cost of Illiteracy (2018) World Literacy Foundation. https://worldliteracyfoundation org/wp-content/uploads/2021/07/T heEconomicSocialCostofIlliteracy-2 pdf
The National Reading Panel Report (2000) https://heggerty org/Phonemic-awareness-research/
Thompson, E C , White-Schwoch, T , Tierney, A , & Kraus, N (2015) Beat Synchronization across the Lifespan: Intersection of Development and Musical Experience. PLOS ONE, 10(6), e0128839 https://doi org/10 1371/journal pone 0128839
Woodruff Carr, K , White-Schwoch, T , Tierney, A T , Strait, D L , & Kraus, N (2014) Beat synchronization predicts neural speech encoding and reading readiness in preschoolers Proceedings of the National Academy of Sciences, 111(40), 14559–14564 https://doi org/10 1073/pnas 1406219111
Ziegler, J C , Pech-Georgel, C , George, F , & Foxton, J. M. (2012) Global and local pitch perception in children with developmental dyslexia Brain and Language, 120(3), 265–270 https://doi org/10 1016/j bandl 2011 12 002
Dureti Gamada
Introduction
Corn is one of the most important crops for supplying nutrients to both humans and animals (Ghazy & El-Nahrawy, 2021). As the third most grown crop, corn is commonly produced throughout the world However, when corn plants are exposed to fungal pathogens, they can develop diseases. As a result, these crops cannot be used for consumption (Degani, 2021) In 2019, diseases destroyed an estimated value of 25.4 million metric tons of corn produced in the United States and Ontario, Canada (Mueller et al., 2020). Fungi infecting a single plant can quickly spread to cause disease throughout an entire field To prevent large sections of crops from developing diseases and becoming inedible, we need to find ways to control these pathogens (Degani, 2021)
In agriculture, fungicides are commonly applied to seeds and crops to prevent the spread of diseases in plants (Lamichhane et al , 2020) However, the use of chemical pesticides not only leads to pathogens developing resistance to the chemical, but it also poses a risk to the environment (Degani, 2021) For example, fungicides pollute soil, consequently killing important microorganisms present in the soil that provide nutrients to plants (Verma et al , 2022) Fungicides also enter bodies of water. The chemicals in fungicides can be toxic to aquatic organisms and prevent them from performing essential ecological functions such as photosynthesis (Zubrod et al , 2019) Fungicide exposure can harm bees and other nonpathogenic fungi as well, impacting these organisms' contributions to the ecosystem (Lamichhane et al , 2020) Due to the various negative effects of fungicide usage, we need to find replacements that do not harm the

environment (Degani, 2021). Researchers are looking into using microbes that plants naturally recruit for their ability to control the growth of pathogens that harm plant health (Li et al., 2021)
Microbes commonly live on and inside plants
Different regions of plants each host a unique community of microbes, called ‘microbiomes.’ These include the phyllosphere, which is found on plant leaves; the endosphere, which is found inside plant tissues; and the rhizosphere, which is found in the soil and on the roots of plants (Turner et al., 2013). However, out of these three microbiomes, plants depend mainly on the microorganisms in the rhizosphere for supporting plant growth and providing several other benefits to the plant (Mendes et al., 2011). Microbes in the rhizosphere can increase the availability of nutrients, such as nitrogen, help plants adapt to various environmental stresses, and even combat fungal pathogen infections (Negi et al., 2022). Some bacteria found in the rhizosphere produce antifungal compounds and enzymes that are toxic to fungal pathogens and inhibit the growth of, or destroy, pathogenic fungal cells (Ram et al., 2022). The severity of infections in a corn plant decreases when it is treated with beneficial bacteria. This is likely due to the presence of antifungal properties in the chosen bacteria (Ghazy & El-Nahrawy, 2021).
Plants influence their own rhizosphere by secreting substances from their roots The specific substances and compounds secreted by a plant will attract different bacterial species (Li et al , 2021) Plants of the same species tend to have similar microbiomes, as plants with similar genomes will secrete similar substances (Turner et al , 2013) However, plants of different species have their own unique microbiome, attracting
bacteria that are the most beneficial to each plant species (Glick & Gamalero, 2021) When a plant undergoes environmental stresses, such as pathogen invasion or dramatic shifts in temperature, the plant’s metabolic processes and the substances it secretes from its roots will change. The microbiome of the plant will also shift, due to this change in secreted substances, as different microbes are attracted by specific compounds that a plant secretes (Glick & Gamalero, 2021) Similarly, when a plant is invaded by a pathogen, the plant microbiome appears to shift in a way that specifically attracts bacteria that produce antimicrobials However, plants are only able to recruit the bacteria that are present within the soil. Therefore, it may be beneficial to manipulate a plant’s rhizosphere to include bacteria that are known to produce antimicrobials in order to prevent diseases in plants in the future (Li et al , 2021)
On corn seeds, it has been shown that groups of bacteria that live together in a plant’s rhizosphere are more effective at controlling the growth of a fungal pathogen than individual strains of beneficial bacteria (Niu et al., 2017). This is likely because several different species of bacteria typically live in a plant’s rhizosphere, each recruited for their ability to contribute to antifungal activity in different ways (Glick & Gamalero, 2021) Additionally, treating plants with a larger number of bacterial strains can increase the likelihood of certain strains adapting to environmental conditions and stress, overall increasing the chance of plants receiving benefits from the bacteria in their microbiome (Ram et al , 2022) Therefore, to accurately replicate a plant’s antifungal microbiome in the rhizosphere and all the benefits microbes may provide to a certain plant, the use of more than a single strain of bacteria is probably required (Glick & Gamalero, 2021). However, it is necessary to first research the effects of individual bacterial species on fungal pathogens in order to understand the inhibitory qualities of each bacterial type
In a recent study, out of seven tested bacterial strains that were isolated from corn plant roots,
Enterobacter cloacae was the most effective at inhibiting the growth of Fusarium verticillioides on corn seeds (Niu et al , 2017) Bacteria of the genus Enterobacter are coliforms: Gram-negative, rod-shaped bacteria that are commonly found in healthy intestines, though some species can cause infection in immunocompromised patients (Guentzel, 1996) E cloacae, specifically, is a coliform bacteria that is commonly found throughout the environment in soil, water, and food Although E cloacae can contaminate medical equipment and, as a result, can cause infections in patients in hospitals, the bacteria commonly lives in the intestines of humans and animals in a commensal relationship (Davin-Regli & Pagès, 2015) E cloacae has the potential to be a useful biocontrol agent against pathogenic fungi since it is generally not pathogenic to humans and possesses the ability to inhibit the growth of one known corn fungal pathogen
One way to test the effects of specific species of bacteria on fungi is by testing their interactions in a controlled environment To do this, a bacterial inoculum is first streaked onto Potato Dextrose Agar (PDA) plates. A fungal disc is cut from a PDA plate that was used to grow the fungal pathogen, and the disc is added to the PDA plate containing the bacteria. Then, the plate is incubated, and the distance of growth of the fungus is compared to a control lacking the bacterial treatment, to determine if the bacteria is an effective biocontrol agent against the fungal pathogen (Ghazy & El-Nahrawy, 2021).
I used this procedure to test the effect of E. cloacae, a bacterial strain naturally recruited by corn that was shown to inhibit the growth of the fungus F. verticillioides, against four different corn fungal pathogens I found that, on agar plates, E. cloacae significantly reduced the growth of two of the four fungal pathogens I tested and showed potential to inhibit the remaining two fungi. Overall, the results suggest that E. cloacae has the potential to inhibit fungal growth in corn plants Application of E cloacae to crops, instead of chemical fungicides, may be
Dureti Gamada
a viable way to reduce the harmful effects of fungicide use on humans and the environment
Materials and Methods
Making PDA plates
Potato Dextrose Agar (PDA) media was prepared at a concentration of 39 grams of PDA powder per liter of water. The media was sterilized by autoclaving, and it was shaken after autoclaving to ensure the agar was evenly distributed. The media was placed in a water bath of 56°C to cool down until it could be touched Sterile petri dishes were poured half f ull with PDA in a sterile biosafety cabinet. After the media had solidified, the plates were stored in a refrigerator at 4°C
Growing fungal plates
Rhizoctonia, F. graminearum, F. subglutinans, and Pythium were grown from existing stocks maintained by the lab, originally supplied by the lab of D. Malvick. To do this, a sterilized cork borer was used to cut plugs into these previously grown plates, and a spatula was used to place a single fungal plug from each of the four fungi onto four separate PDA plates The fungal plugs were placed in the center of the new agar plates so that the side with the fungal growth was faced towards the agar plate to allow for fungal growth These plates were incubated at 28°C for seven days before they were used.
Making TSA plates
Tryptic Soy Agar (TSA) was prepared at a concentration of 15 grams of Agar Type A and 30 grams of Tryptic Soy Broth per liter of water
The media was autoclaved, and the container was subsequently shaken to prevent agar from settling at the bottom The media was cooled in a 56°C water bath When they had cooled, the TSA plates were poured into a sterile biosafety cabinet Once the plates had solidified, they were refrigerated at 4°C
Growing bacteria in TSA plates
Enterobacter cloacae, from the lab of B Niu, which had been stored at -80°C, was spread with
a micropipette tip on a TSA plate in a biosafety cabinet The bacteria was streaked in three portions of the plate in order to form single colonies that could be collected. A third of the plate was initially streaked with the bacteria A second micropipette tip was used to streak another third of the plate, using only the bacteria already present on the plate A third micropipette tip was used to streak the last third of the plate using the previously streaked bacteria After finishing streaking the bacterial solution, the plate was incubated for two days at 25°C.
5 mL of autoclaved water was poured into a sterile container. A micropipette was used to scrape off one to two E cloacae bacterial colonies from the TSA plate These colonies were added to the sterile water, and the bacteria within the container was evenly distributed in the liquid by mixing with a micropipette A spectrophotometer was calibrated using a cuvette with sterilized water before the number of bacterial cells per mL in the container was measured with a sample cuvette. Th e solution in the container was diluted until it reached an OD600 value near 0 100, or a concentration of approximately 108 cells per mL.
Streaking bacteria
PDA plates were separated into four groups of ten plates for each of the four fungal pathogens. A micropipette was used to streak five plates from each group in a straight line across the center of the agar plate with 20 µL of water. 20 µL of bacterial inoculum was used to streak the remaining five agar plates from each group with E. cloacae in a straight line. After all the plates had been streaked, the plates were incubated for two days at 28°C for the bacteria to grow and to ensure all antifungal compounds had been secreted into the agar.
Placing fungal plugs
After two days of incubation, a sterilized, size three cork borer was used to cut plugs into the four previously prepared fungal plates To
prevent contamination, this procedure was performed in a sterile biosafety cabinet Ten fungal plugs from each of the four fungal plates were placed onto the appropriate group within the 40 plates Sterilized spatulas were used to place the fungal plugs onto the edge of all 40 plates, perpendicular to the line of the bacterial growth (Figure 1) All the fungal plugs were placed onto the agar plates so that the side of the fungal growth was faced down towards the agar. The plates were incubated for seven days at 28°C
Effect of E. cloacae on growth of Rhizoctonia
The growth of Rhizoctonia was tested in agar plates both with and without the presence of the bacterial strain E. cloacae. In all plates, regardless of the presence of the bacteria, the distance of growth of Rhizoctonia was eight centimeters in length, which is the full distance across the plate (Table 1) Although there was no difference in the distance of Rhizoctonia growth in the presence of E. cloacae, there was a qualitative difference in the n of the fungus While the without E. cloacae appeared brown, onia with E cloacae had a lighter n and appeared white (Figure 2)

the placement of the bacterial strain and fungal plug in an agar plate. Figure by author.
The fungal growth on each plate was measured in centimeters (cm), using a ruler. They were measured from the center of the fungal plug to the farthest point of mycelium growth, horizontally across the plate from the plug. The data for the fungal growth of the plates was recorded in a spreadsheet.
Calculating p values
The treatment and control values for F graminearum and F. subglutinans were entered into Google Sheets, and the p values were calculated using the Google Sheets t-test function.
owth of Rhizoctonia in Agar Plates in Treatment Conditions

control plate, on the left, contains a fungal plug and water streaked across the center. The treatment plate, on the right, contains a fungal plug and E. cloacae streaked across the center Photo by author
Effect of E. cloacae on growth of Pythium
The growth of Pythium was tested both with and without the presence of the bacterial strain E cloacae. Three of the five trials were contaminated, and therefore could not be included in the analysis In the remaining two trials, the distance of Pythium growth across the plate was reduced in the presence of E. cloacae, compared to the distance of growth in the absence of the bacteria. However, due to the small sample size, the significance of this difference could not be determined (Table 2) In the control plates, the fungus appeared slightly transparent throughout the plate, whereas in the treatment plates, the fungus appeared more concentrated and opaque around the fungal plug (Figure 3).
Table 2. Growth of Pythium in Agar Plates in Control and Treatment Conditions
Effect of E. cloacae on growth of F. subglutinans
The growth of F. subglutinans was tested both with and without the presence of the bacterial strain E. cloacae. In all the plates treated with E. cloacae, the distance of F. subglutinans growth was lower compared to the plates that were not treated with the bacteria (Table 3). One plate that was not treated with bacteria was not analyzed, as it was contaminated There was a significant decrease in the average distance of F. subglutinans growth in the presence of the bacteria compared to the absence of the bacteria (Figure 4; p<0.01). In the control plates, parts of the fungus appeared beige, whereas in the treatment plates, the fungus appeared white (Figure 5).
Table 3. Growth of F. subglutinans in Agar Plates in Control and Treatment Conditions
Maximum Distance of Growth
plates with Pythium after incubation. The control plate, on the left, contains a fungal plug and water streaked across the center The treatment plate, on the right, contains a fungal plug and E cloacae streaked across the center Photo by author

Figure 4. Growth of F. subglutinans under Control and Treatment Conditions. The average distance (+/- s d ) of growth of F subglutinans in control plates (n = 4; No bacteria) was significantly greater than in plates streaked with E cloacae (n = 5; E cloacae; p<0.01).
control plate, on the left, contains a fungal plug and water streaked across the center The treatment plate, on the right, contains a fungal plug and E cloacae streaked across the center Photo by author
Effect of E cloacae on growth of F graminearum
The growth of F graminearum was tested both with and without the presence of the bacterial strain E cloacae In all the plates treated with E cloacae, the growth of F graminearum was lower when compared to the plates that were not treated with the bacteria (Table 4) There was a significant decrease in the average distance of F graminearum growth between the plates that were tested in the presence of the bacteria, and in the absence of the bacteria (Figure 6; p<0.0001). There was no consistent difference observed in the color of the F graminearum in the presence of the bacteria as compared to F graminearum in the absence of the bacteria (Figure 7)
Table 4. Growth of F graminearum in Agar Plates in Control and

Figure 6. Growth of F. graminearum under Control and Treatment Conditions. The average distance (+/- s.d.) of growth of F. graminearum in control plates (n = 5; No bacteria) was significantly greater than in plates streaked with E cloacae (n = 5;

g p
agar plates with F graminearum after incubation The control plate, on the left, contains a fungal plug and water streaked across the center. The treatment plate, on the right, contains a fungal plug and E. cloacae streaked across the center Photo by author
Discussion
This research demonstrates that E cloacae shows potential as an effective treatment against fungal diseases in corn E cloacae significantly reduced the growth of fungal mycelium growth in agar plates containing F. subglutinans and F. graminearum In both the control and treatment plates containing the fungal pathogen Rhizoctonia, the fungal growth covered the entire agar plate In spite of this, the density of the fungal growth qualitatively appeared to decrease with treatment, as the fungi in the treatment plates were a pale color instead of brown In the control and treatment plates containing Pythium, there was contamination in
three of the five trials. In the remaining two trials, the treatment plates had reduced fungal growth in comparison to the control plates However, due to the contamination, statistical analysis of this difference was not possible
I was unable to analyze six of the ten Pythium plates, and one of the F. subglutinans plates due to the fact that these plates were contaminated As a result, statistical analysis of these plates was not done, leading to a lack of conclusive results for Pythium Also, since I only measured the horizontal distance of fungal growth to determine the impact of the bacteria on the fungus, I was unable to account for other, more subtle aspects of fungal growth, such as the density of the fungus between control and treatment plates For example, Rhizoctonia in both the control and treatment plates grew the same distance from the fungal plug, but the notably lighter pigmentation in the treatment plates may indicate that, in the presence of the bacteria, the fungal growth was less dense, and, thus, was inhibited by the bacteria Ultimately, determining the density of the fungi could give additional, useful information about the impact of the bacteria on fungal growth in the future Lastly, the bacteria were tested against fungal species on agar, rather than in a natural environment, such as a field containing corn crops. There are additional variables in the environment that may impact the interactions between bacteria and fungi
E. cloacae is one of the many beneficial bacterial strains that plants can recruit As several beneficial microbes tend to interact in soils in order to benefit a plant, it would be most effective to create treatments for plants containing combinations of several bacteria, instead of using a single strain of bacteria (Glick & Gamalero, 2021) As a result, in the future, it will be necessary to determine the most effective combinations of bacteria to combat different types of fungal disease Once researchers determine optimal combinations, it is necessary
to then create treatments that can be applied to fields of crops to test the effectiveness of these treatments in preventing the spread of fungal diseases under real-world conditions. These treatments could eventually be used in fields as a replacement for fungicides By stopping the use of fungicides, we could reduce or even eliminate the use of fungicides that contribute to harming the environment
This research project would not have been possible without the help of Dr Devanshi Khokhani, a plant pathologist at the University of Minnesota, as well as Pranaya Kaki, a graduate student at the University of Minnesota I am thankful for the opportunity they gave me to work on the experiments occuring their lab, and the help they provided me while carrying out my project With their guidance, I have learned essential skills in conducting microbiology research I would also like to thank Dr Kati Kragtorp for the opportunity to conduct laboratory research through the Advanced Science Research program, and for providing me with continuous support throughout my project I am grateful for the valuable experiences I have gained in this program
Davin-Regli, A., & Pagès, J.-M. (2015). Enterobacter aerogenes and Enterobacter cloacae; versatile bacterial pathogens confronting antibiotic treatment Frontiers in Microbiology, 6 https://www frontiersin org/articles/10 3389/fmicb 2015 00392
Degani, O (2021) A Review: Late Wilt of Maize The Pathogen, the Disease, Current Status, and Future Perspective Journal of Fungi, 7(11), 989 https://doi org/10 3390/jof7110989
Ghazy, N , & El-Nahrawy, S (2021) Siderophore production by Bacillus subtilis MF497446 and Pseudomonas koreensis MG209738 and their efficacy in controlling Cephalosporium maydis in maize plant Archives of Microbiology, 203(3), 1195–1209 https://doi org/10 1007/s00203-020-02113-5
Glick, B R , & Gamalero, E (2021) Recent Developments in the Study of Plant Microbiomes Microorganisms, 9(7), 1533 https://doi.org/10.3390/microorganisms9071533
Guentzel, M N (1996) Escherichia, Klebsiella, Enterobacter, Serratia, Citrobacter, and Proteus In S Baron (Ed ), Medical Microbiology (4th ed ) University of Texas Medical Branch at Galveston http://www ncbi nlm nih gov/books/NBK8035/
Lamichhane, J R , You, M P , Laudinot, V , Barbetti, M J , & Aubertot, J.-N. (2020). Revisiting Sustainability of Fungicide Seed Treatments for Field Crops Plant Disease, 104(3), 610–623 https://doi org/10 1094/PDIS-06-19-1157-FE
Li, J , Wang, C , Liang, W , & Liu, S (2021) Rhizosphere Microbiome: The Emerging Barrier in Plant-Pathogen Interactions Frontiers in Microbiology, 12 https://www frontiersin org/article/10 3389/fmicb 2021 772420
Mendes, R., Kruijt, M., de Bruijn, I., Dekkers, E., van der Voort, M , Schneider, J H M , Piceno, Y M , DeSantis, T Z , Andersen, G L , Bakker, P A H M , & Raaijmakers, J M (2011) Deciphering the Rhizosphere Microbiome for Disease-Suppressive Bacteria Science, 332(6033), 1097–1100 https://doi org/10 1126/science 1203980
Mueller, D S , Wise, K A , Sisson, A J , Allen, T W , Bergstrom, G. C., Bissonnette, K. M., Bradley, C. A., Byamukama, E., Chilvers, M I , Collins, A A , Esker, P D , Faske, T R , Friskop, A J , Hagan, A K , Heiniger, R W , Hollier, C A , Isakeit, T , Jackson-Ziems, T A , Jardine, D J , Wiebold, W J (2020) Corn Yield Loss Estimates Due to Diseases in the United States and Ontario, Canada, from 2016 to 2019 Plant Health Progress, 21(4), 238–247 https://doi org/10 1094/PHP-05-20-0038-RS
Negi, S , Kumar, P , Kumar, J , Singh, A , & Dubey, R C (2022) Chapter 2 Indigenous nitrogen fixing microbes engineer rhizosphere and enhance nutrient availability and plant growth In R C Dubey & P Kumar (Eds ), Rhizosphere Engineering (pp 19–43) Academic Press https://doi org/10 1016/B978-0-323-89973-4 00005-3
Niu, B , Paulson, J N , Zheng, X , & Kolter, R (2017) Simplified and representative bacterial community of maize roots Proceedings of the National Academy of Sciences, 114(12). https://doi org/10 1073/pnas 1616148114
Ram, R M , Debnath, A , Negi, S , & Singh, H B (2022) Chapter 22 - Use of microbial consortia for broad spectrum protection of plant pathogens: Regulatory hurdles, present status and future prospects In A Rakshit, V S Meena, P C Abhilash, B K Sarma, H B Singh, L Fraceto, M Parihar, & A K Singh (Eds ), Biopesticides (pp. 319–335). Woodhead Publishing. https://doi org/10 1016/B978-0-12-823355-9 00017-1
Turner, T R , James, E K , & Poole, P S (2013) The plant microbiome Genome Biology, 14(6), 209 https://doi org/10 1186/gb-2013-14-6-209
Verma, V C , Acharya, S , Kumar, R , Verma, B C , Singh, A , & Tiwari, V K (2022) Chapter 5 Rhizobium as soil health engineer. In R. C. Dubey & P. Kumar (Eds.), Rhizosphere Engineering (pp 77–95) Academic Press https://doi org/10 1016/B978-0-323-89973-4 00023-5
Zubrod, J P , Bundschuh, M , Arts, G , Brühl, C A , Imfeld, G , Knäbel, A , Payraudeau, S , Rasmussen, J J , Rohr, J , Scharmüller, A , Smalling, K , Stehle, S , Schulz, R , & Schäfer, R B (2019) Fungicides: An Overlooked Pesticide Class? Environmental Science & Technology, 53(7), 3347–3365. https://doi org/10 1021/acs est 8b04392
Noah Getnick
Introduction
Biomimicry, the incorporation of biological shapes and structures into engineering design, can improve the efficiency and effectiveness of modern technologies The evolution of many species has created biological mechanisms best adapted to a variety of environments (Yan, 2007) In particular, squid propulsion can be studied in the context of biomimicry squid propel themselves using a unique mode of jet propulsion, in which they take water into their hollow mantle, before ejecting it through a small funnel to generate thrust (Anderson & Grosenbaugh, 2005). During high speed escapes, squid rapidly expel water from their bodies by deflating their mantle from a spherical shape (Steele et al., 2017). This type of shape change reduces drag by limiting the width of the wake produced by the squid (G. D. Weymouth & Triantafyllou, 2013). Mimicking this shrinking motion offers the potential for improvements to human designs.
Fluid simulations reveal subtle changes in flow velocity and direction that animals take advantage of, providing an important resource to researchers seeking to mimic the evolved traits of aquatic organisms (Sun et al., 2018). However, fluid simulations are often extremely difficult to use, requiring high levels of computational processing power and time (G D Weymouth, 2015)
Lily Pad, a 2D fluid simulation created by Dr Gabriel Weymouth, was written with the goal of improving accessibility to fluid simulation Lily Pad is available as public software that can be downloaded from its Github page It is run with the Processing digital art software (G Weymouth, n d -a), which uses Java as its coding language The basis of Lily Pad are the 2D Navier Stokes equations, a set of differential

equations used to determine fluid flow. It also uses the Boundary Digital Immersion Method method for its fluid calculations, which organizes fluid and solid interactions into separate steps (Battitsta, n d ) Through this, Lily Pad is able to accurately model the dynamics of a fluid moving past a stationary body, while being accessible and easy to use
My goal was to modify Lily Pad to analyze the performance of a shrinking, squid-like body First, I wrote new code in Lily Pad to create complex shapes and model expansion and contraction To improve data analysis, I wrote new methods to calculate and display kinetic energy, force, and power From this point, I analyzed shrinking ellipses as a model for the shrinking of a squid to develop an understanding of how shape changes cause differences in performance.
When Lily Pad runs, it holds solid bodies stationary, while running the fluid through the simulation window Parameters that can be displayed include fluid velocity, pressure, and vorticity, with negative (counterclockwise) values being in blue and positive (clockwise) values being in red.
The overall goal of this project was to simulate shrinking bodies in Lily Pad. To adapt the fluid calculations to a changing body, I first created a new boolean to trigger the adjustment of the flow calculations to adapt to any changing body
I then created a method to redefine individual points to cause an overall shape change By removing a point from a body, moving it, and
immediately adding it back, this function could change the shape of specific parts of a body. I then used “for” loops to repeatedly run the method to uniformly expand and contract shapes To maintain a steady rate of expansion/contraction, the initial distances from each point to the center of the body were saved at the start of the simulation I could then move each point a percentage of the distance to the center, thus allowing a steady rate of contraction/expansion to be done relative to the initial size of the body With this new system, shapes could be shrunk horizontally and/or vertically, and the shrinking rate could also be adjusted
Lily Pad’s calculations use non-dimensional numbers. Lily Pad scales calculations based on the grid cell dimension, the uniform flow velocity, and the fluid density (G. Weymouth, n.d.-b). Each calculation that was saved returned a nondimensionalized value that could be compared with other data sets from Lily Pad. I measured time by counting the number of frames, using a variable “t” that was incremented every loop of the simulation.
I added several methods to analyze different data values in Processing, including pressure, kinetic energy, and power The original Lily Pad code contains a method titled “pressForce,” which takes pressure data and calculates forces on the body This is done by taking the pressure at the midpoint of each line segment making up a body, and solving for force in the formula: pressure = force / area
In this case, the length of each segment is the area, since the simulation is in 2D space This value is then multiplied by the cosine of the angle of the segment to form a X value, and multiplied by the sine to create a Y value These values are put into vectors for each segment, and then summed, producing an overall force vector
Kinetic energy of the fluid flow was also calculated, using the formula: KE = 0.5 * mass * velocity2
Instead of determining the kinetic energy of each fluid cell in the simulation, I found the average
velocity of the fluid, and used the formula for the entire fluid. Since data was nondimensional, the mass of the body was set to 1, meaning that the kinetic energy values could only be compared between tests Since the simulation holds the body stationary and moves the fluid, I adjusted the calculations to reduce the value of the X component of velocity by the free stream velocity of the flow, in order to study the intended situation of a body moving through a stationary fluid
Lastly, the power enacted on the body by the fluid was calculated The formula of:
P = f v (Power = Force dot Velocity) • was applied for each segment of the body, and the resulting products were added together. The velocity vector was obtained for each segment by subtracting the initial position of the center from the end position of the center for each frame. As with kinetic energy, the velocity vector was adjusted by subtracting the free stream velocity from the X component of velocity.
Lily Pad has a set of methods, located in the “saveData'' class, which collects the data in the form of txt files I first declared an instance of the saveData class at the start, before saving data during each frame
Initially, I saved data in the form of a txt file, which consisted of long lists of numbers The data was reorganized by inserting spaces and reordering the way the data was printed I also created data tables with Lily Pad, using functions included with Processing to save data in .csv files. While these tables were not used during data analysis in this project, they provide the opportunity to enhance the process by making data much easier to understand.
As more data types were developed, I reworked the saveData class in LilyPad to better organize data. I added 1-4 string parameters in the constructor of the class. The code in the constructor would then check for the names of any data types (force, kinetic energy, or power) in the four strings. During each frame, the code saved data types depending on which booleans
were selected. This allowed for any combination of 1-4 data types to be saved without the need to create specialized code.
I enhanced data analysis using Octave (GNU Octave, n d ), a mathematical software, to create graphs to visualize data changes I took data from Lily Pad in the form of single row matrices created in txt files I created a “main” function called “mainSetup,” serving as a hub from which subsidiary functions could be automatically run I would input up to 4 matrices, each representing a test into the “mainSetup” function, and it would automatically generate a set of graphs based on the data types (e g , force, kinetic energy power) saved I also used Processing’s “saveFrame” function to save screenshots of the code, allowing me to view the simulation slowly and repeatedly, revealing small changes
Testing
I tested different bodies in Lily Pad, using the modified simulation to model shrinking bodies. When testing shrinking shapes, the shrinking would occur at the beginning of the simulation, shrinking vertically only No bodies were moved in the simulation, and the free stream flow velocity also remained steady To represent the flattening motion of a squid during propulsion, I started shapes off as circles, before only shrinking vertically down to ellipses (Steele et al , 2017) In the first set of tests, I shrank these shapes at a constant rate of 2% of their initial height per frame, but shrank them for different periods of time to end with four different ellipses

Dureti Gamada
with the same lengths, but different height to length ratios of 1:5, 1:4, 1:3, and 1:2. I compared these tests to a rigid circle and four rigid ellipses with the same height to length ratios I also tested different rates of shrinking by testing three shrinking rates These also started as a circle and shrank only in the Y direction down to the same shape with a 1:5 height to length ratio The shapes shrinking at a rate of 1%, 2%, and 5% of their initial height per frame were compared to a rigid circle and rigid ellipses with the same height to length ratios However, the results of these tests of shrinking rate are not discussed in this article Data was saved using Lily Pad and was converted into graphs using Octave
Phases of Lily Pad
To simplify the process of how the fluid develops around a simple body, the simulation can be divided into four parts: the initiation, development, release, and periodic phases. In the initiation phase, the fluid starts interacting with the body Drag briefly peaks, before decreasing as the fluid develops around the body (Figure 1a) In the development phase, the fluid continues to develop behind the body into two vortices Drag is relatively stable during this period (Figure 1b) The vortices grow backwards slowly until the release phase, in which they begin to separate from the body Drag increases due to the disruption in flow created by the separated vortices (Figure 1c)



Figure 1. Simulation of 1:2, rigid ellipse during initiation (a), development (b), release (c), and periodic (d) phases. Red represents clockwise/positive values and blue represents negative/counterclockwise values The numbers displayed below the key on each screenshot represent the maximum and minimum values for each data point in the entire simulation Figure by author

F ellipses with phases labeled. Units are non dimensional Positive values indicate drag Figure by author
After the release of the initial set of vortices, the periodic phase begins, when additional vortices are created on alternating sides, forming a periodic pattern of formation and release. This repeating pattern continues indefinitely (Figure 1d). For the 1:2 rigid ellipse, the initiation phase happened between 0 and 50 frames, the development phase happened between 50 and 350 frames, the release phase happened between 350 and 500 frames, and the periodic phase happened after 500 frames. Different shrinking rates and magnitudes changed the timing of the phases.
A comparison of the drag between the 1:2 shrinking and rigid ellipses allows for a general understanding of the effects of the shrinking motion In the initiation phase, the 1:2 shrinking shape saw a spike in drag, due to it starting off as a circle (Figure 2)
However, drag rapidly decreased once the shape had shrunk After the shrinking was finished, the development phase began, and the shrunken shape performed slightly better until the beginning of the release phase At this time, the drag increased sharply in the shrinking shape, while drag increased more slowly in the rigid shape. Once the periodic phase began, the two shapes performed relatively similarly because differences caused by the shrinking wore off over time.
During the development phase, both shapes formed a large set of opposite vortices behind their bodies (Figure 3a, 3b) This set of vortices was the initial set formed and remained attached to the body until the start of periodic vortex formation (addressed in next section). However, the large set of vortices was slightly bigger in the shrinking shape (Figure 3b) as compared to the rigid shape. The shrunken bodies likely had a larger set of vortices because they started off as a larger shape. Even after shrinking, the shrunken bodies continued to have larger vortices. Fluid was directed around these vortices in both tests (Figure 3c, 3d), but fluid was accelerated more in the shrunken body (Figure 3d). This accelerated flow reduced drag observed during the development phase (Figure 2).
At the beginning of the release phase, the shrinking shape had a rapid increase in drag (Figure 2) This increase was due to the release of the larger initial set of vortices formed by the shrinking shape (Figure 4a, 4b), which created a much wider, less efficient wake in the shrinking shape (Figure 4b) By the periodic phase, the differences between the shrinking and rigid shapes wore off, and the alternating vortices became identical in size and scale As a result, the drag values became the same between the two tests (Figure 2)
As in the 1:2 tests, the 1:5 shrinking shape experienced a spike in drag during the initiation phase, but during the development phase, the 1:5
shape performed better than the rigid shape after the shrinking finished. The shrinking shape saw a dip in performance in the release phase, but the increase in drag was only 42 6% in the 100
frames before peak drag was reached at 288 frames (Figure 5), much less than in the 1:2 tests, where drag increased 77.3% (Figure 2).




Figure 3. Screenshots of 1:2 shrinking and 1:2 rigid shapes during the development phase at 150 frames showing (a, b) vorticity and (c, d) velocity. For vorticity, red represents clockwise/positive values and blue represents negative/counterclockwise values The numbers displayed below the key on each screenshot represent the maximum and minimum values for each data point in the entire simulation Figure by author


se at 450 frames. The rigid tests are on the left, while the shrinking tests are on the right Red represents clockwise/positive values and blue represents negative/counterclockwise values. The numbers displayed below the key on each screenshot represent the maximum and minimum values for each data point in the entire simulation Figure by author

Figure 5. Force data for 1:5 rigid and shrinking data. Units are non-dimensional. Positive values indicate drag. Figure by author.


c d


Figure 6. Screenshots of 1:2 and 1:5 shrinking ellipses in the development phase at 150 frames showing (a, b) vorticity and (c, d) velocity. For vorticity, red represents clockwise/positive values and blue represents negative/counterclockwise values The numbers displayed below the key on each screenshot represent the maximum and minimum values for each data point in the entire simulation Figure by author


aFigure 7. Screenshot of 1:2 (a) and 1:5 (b) shrinking ellipses in the release phase at 450 frames showing vorticity. The 1:2 tests are on the left, while the 1:5 tests are on the right. For vorticity, red represents clockwise values and blue represents counterclockwise values The numbers displayed below the key on each screenshot represent the maximum and minimum values for each data point in the entire simulation Figure by author
During the development phase, the initial set of vortices was smaller in the 1:5 shrinking shape than in the 1:2 shrinking shape (Figure 6a), due to the smaller size of the 1:5 ellipse This led to less improvement in performance over the rigid shape, as the fluid was accelerated more slowly around the 1:5 shrinking ellipse than around the 1:2 shrinking ellipse (Figure 6b).
The release phase began earlier in the 1:5 ellipse, since its more streamlined shape produced more frequent vortices than the 1:2 shape The 1:5 shrinking shape had a smaller increase in drag when the first set of vortices was released (Figure 5) This was due to the narrower 1:5 body, which formed smaller vortices that were directed straight back instead of outwards, reducing the drag on the body (Figure 7)
Comparing the overall percent difference in total impulse between the shrinking and rigid shapes gives a general idea of the reduction in drag caused specifically by shrinking Using Octave, the impulse, the integral of the forces on the body over time, was taken by adding up every force value taken for each frame To make the comparison between the shrinking and rigid shapes, the impulse was taken only for the period after shrinking had finished, to isolate the effect of the shrinking on drag, while ignoring drag data caused by initial differences in size. Since the shrinking rate was held constant, the shrinking duration was longer for the more streamlined shapes.
When the initial shrinking period was not taken into account, the 1:5 shrinking shape had less impulse over this later period than the 1:5 rigid shape, while the 1:2 shrinking shape had slightly
more impulse than the 1:2 rigid shape (Figure 8). This is because the more streamlined 1:5 shape reduced the drag caused by vortex formation during the release phase. Overall, shrinking the 1:5 ellipse reduced drag relative to its rigid counterpart (Figure 8), while the less streamlined 1:4, 1:3, and 1:2 shapes saw more drag when shrunk

Figure 8. Percent change in impulse of drag force from rigid to shrinking shape for each aspect ratio. The range in parentheses is the range of time in frames over which impulse data was taken Impulse data is non-dimensional. Figure by author.
The collected data showed that, following an initial spike in drag, the shrinking tests temporarily performed better than the rigid shapes after the shrinking was finished. This was due to the acceleration of the fluid around the wake. However, the release of vortices caused drag to rapidly increase in the shrinking tests. As a result, following the shrinking period, the 1:2, 1:3, and 1:4 shrinking shapes had more drag than the rigid shape of the same size during the same period. In contrast, the 1:5 shrinking shape performed better than the 1:5 rigid shape, due to the smaller vortices formed by the more streamlined body. The data shows that more streamlined shapes reduce drag when shrunk by retaining the benefits of accelerated flow, while reducing the increase in drag caused by vortex formation.
Ultimately, the modified version of Lily Pad created in this project provides enhanced functionality as compared to the original program New methods model shrinking and expanding shapes that can be applied to squid propulsion New data calculations in Lily Pad provide new insights on variables like force, power, and kinetic energy The reworked data analysis system is interactive and easy to use Raw data files can be sent to Octave, where they are graphed and further calculations can be done to analyze the data Moving forward, Lily Pad provides a base for future work, providing new opportunities to analyze the performance of solid bodies in a fluid The modifications in Lily Pad also make it more accessible to students and other individuals who lack access to complex simulation software.
Lily Pad’s greatest strength, its simplicity, also limits its accuracy It is only able to calculate data for a limited area of fluid, meaning that the propagation of flow outside of the window is not taken into account. This means that placing a body in different positions within the window changes the length of the wake that Lily Pad simulates, which will cause inconsistencies in drag values, since much of the drag of an object depends on its wake. In this project, this inaccuracy was mitigated by placing different bodies at a fixed distance from the right edge of the simulation window, but this cannot prevent all major inconsistencies, especially with bodies that are taller/narrower, which have different vortex formation frequencies.
Moreover, Lily Pad has a limited resolution of grid cells, preventing the simulation of a real fluid, consisting of individual molecules Using a more powerful computer could reduce these issues by allowing an increase in the simulation resolution and window size Finally, since, in this project, Lily Pad was used to construct bodies with no more than 100 line segments, it is unable to perfectly model complex bodies like those of squid
The shrinking motion used also has potential errors associated with it. The shrinking motion coded into Lily Pad only shrinks the shape of the body without affecting the flow around it It is possible that this change meant that the new area of fluid created by the retraction of the body was filled by generating new fluid, instead of forcing the surrounding fluid into the empty space This would cause errors around calculations near the boundary layer
The real world applications of this data are also limited by several factors It was not possible to adjust the viscosity and density of the fluid in Lily Pad in order to specifically model water Moreover, Lily Pad’s non-dimensional numbers prevent the direct application of numerical values into real world data An additional consideration to be taken into account would be the effect of different accelerations on the body Faster shrinking bodies would move the body faster, increasing drag. Potentially, the benefits of shrinking faster would be outweighed by the increase in drag caused by faster movement. In this project, the inability to change the uniform fluid velocity reduced the accuracy of the modeling of squid propulsion.
Additional modifications to Lily Pad should focus on adjusting the viscosity and densities of the fluid to match those of water. Adding code to accelerate and decelerate the fluid velocity in the simulation could facilitate more accurate analysis of squid propulsion at different stages, since faster and larger shrinking rates would also increase the total impulse during a cycle of propulsion Calculations to reinsert units into the non-dimensional data values could enable real world application of data These revisions to Lily Pad would further improve the ability to accurately test complex, biomimetic shapes in the real world
Further experimental work would also focus on improving real world applications More realistic models of squid could be created by modeling arms and fins, which are key parts of propulsion Testing full cycles of expansion and contraction in a squid-like body would also provide insights on the effects of the shape
changes of squid. Ultimately, the final step in analyzing the performance of squid-like shapes would be to create a squid-based soft robot based on the parameters suggested by this virtual model and test it in water This could provide further applicable insights to understanding squid propulsion and how it can be used to enhance human engineering
I would like to express my gratitude to Dr Perry Li at the University of Minnesota Twin Cities for all of his time and feedback throughout the summer Thank you as well to Dr Li’s research group, who gave their time for me to present my findings I would also like to thank Dr Kati Kragtorp, whose constant support was provided throughout both the research and writing processes.
Anderson, E J , & Grosenbaugh, M A (2005) Jet flow in steadily swimming adult squid Journal of Experimental Biology, 208(6), 1125–1146 https://doi org/10 1242/jeb 01507
Battitsta, N (Director) (n d ) IB2d Video Tutorial 1: An introduction to the immersed boundary method Retrieved May 27, 2022, from https://www.youtube.com/watch?v=PJyQA0vwbgU
GNU Octave (n d ) Retrieved June 22, 2022, from https://octave org/index
Steele, S C , Weymouth, G D , & Triantafyllou, M S (2017) Added mass energy recovery of octopus-inspired shape change Journal of Fluid Mechanics, 810, 155–174 https://doi org/10 1017/jfm 2016 701
Sun, P -N , Colagrossi, A , & Zhang, A -M (2018) Numerical simulation of the self-propulsive motion of a fishlike swimming foil using the δ + -SPH model Theoretical and Applied Mechanics Letters, 8(2), 115–125 https://doi org/10 1016/j taml 2018 02 007
Weymouth, G (n d -a) Documentation weymouth/lily-pad Wiki GitHub Retrieved May 26, 2022, from https://github.com/weymouth/lily-pad
Weymouth, G (n d -b) Non dimensional weymouth/lily-pad Wiki GitHub Retrieved May 26, 2022, from https://github com/weymouth/lily-pad
Weymouth, G D (2015) Lily Pad: Towards Real-time Interactive Computational Fluid Dynamics https://doi org/10 48550/ARXIV 1510 06886
Weymouth, G D , & Triantafyllou, M S (2013) Ultra-fast escape of a deformable jet-propelled body Journal of Fluid Mechanics, 721, 367–385 https://doi org/ct
Yan, Y Y (2007) Recent advances in computational simulation of macro-, meso-, and micro-scale biomimetics related fluid flow problems Journal of Bionic Engineering, 4(2), 97–107 https://doi.org/10.1016/S1672-6529(07)60021-3
Ava Jaffe and Romy Peterson
Introduction
Fear is a mechanism that evolved to protect animals from danger; however, animals must also overcome this fear in appropriate situations. In nature, fear is used to weigh risks and evaluate whether a reward is worth the danger. If an animal decides to take a risk, it must be able to overcome its fear in order to survive Animals are more likely to take risks if the risk is necessary for their survival (Choi & Kim, 2010). For example, a hungry animal is more likely to attempt to steal food near a predator as compared to an animal that is well-nourished. There is evidence that when an animal is conditioned to a risk, amygdala activation, the part of the brain believed to be responsible for fear, decreases, making it easier for the animal to overcome their fear (Büchel, 2000).
Fear disorders such as PTSD, panic, and phobia are related to amygdala dysfunction in the brain (Gafford & Ressler, 2016) Control of fear and anxiety relies on a neural system, which is typically experimentally assessed through Pavlovian fear conditioning (Lesting et al , 2011). Pavlovian fear conditioning is a form of associative memory formation where a conditioned stimulus (CS) such as a loud noise is paired with a fear arousing unconditioned stimulus such as a foot shock (Lesting et al , 2011) As a result, a memory is formed which allows the CS to elicit a fear-based response (Lesting et al , 2011) Experiments using Pavlovian fear conditioning indicate that theta coupling, a neurophysiologic process underlying working memory, provides a means for pathway coordination in conditioned behavioral responsiveness (Lesting et al., 2011). More specifically, oscillations in theta coupling seem to contribute to a population code, a neural code shared across a population, indicating conditioned stimuli during the recall of fear

memory before and after extinction (Lesting et al , 2011) Fear extinction is defined as a decline in conditioned fear responses following non-reinforced exposure to a feared conditioned stimulus (CS; Lesting et al , 2011) Despite research done on behavioral analysis during fear situations and what happens when fear is incited, there hasn’t been focused research on what happens in the brain when innate fear is overcome.
One way researchers have studied innate fearful behavior in rats is through the use of a semi-realistic robotic mock predator called a Robogator (Choi & Kim, 2010) The Robogator was built using Lego Mindstorms and was designed to act as a predator to induce fear in hungry rats attempting to obtain a food reward It was programmed to surge at the rat when it nears the food pellet, though not actually touch or harm it, thus scaring them and forcing them to retreat. This process was repeated until the rat either eventually overcame its fear and retrieved the food pellet or gave up Although it is reasonable to expect that animals are more likely to take risks when the reward outweighs the alternative, very little research has been done to explicitly test what is happening in their brains as they make these decisions (Ludvig et al., 2014)
The role of the amygdala in fear is highly conserved between species (Adolphs, 2013). The amygdala is the part of the brain believed to mediate fear responses The amygdala not only processes stimuli but also controls how the body reacts to the stimulus In order to send information throughout the amygdala, many circuits are involved. Information is initially received from the sensory thalamus and sensory cortices The information is projected to the lateral amygdala (LA). From there, the LA projects within the basolateral complex of the
amygdala (BLA) to the basal amygdala, the basomedial amygdala, and the central nucleus of the amygdala This is possible because the BLA is reciprocally connected to many cortical regions, including the midline and orbital prefrontal cortices, the hippocampus, and sensory association areas (Janak & Tye, 2015).
Several brain imaging techniques have been developed to track activity in the brains of mice and other animals in real time. Most devices require the animal to be stationary, or ‘head fixed,’ during the experiment, preventing testing during locomotion. The ‘mini-mScope’ was created to image a majority of the dorsal cortex of mice during natural behaviors (Rynes et al , 2021). The mini-mScope is a widefield, miniaturized, head-mounted fluorescent microscope that images the brain through a transparent polymer skull. The mice are genetically modified to possess the Thy1-GCaMP6f gene which expresses GCaMP6f, a green fluorescent indicator that detects single-neuron action potentials (024276GP5 5 Strain Details, n d ) Mice are implanted with transparent polymer skulls, a process that requires a procedure that does not harm the brain, unlike many other brain imagining implementations. Since the device weighs only 3.8 grams, it allows the mice to move freely during testing while simultaneously recording their brain activity.
The goal of this project was to develop a system to analyze activity in the amygdala of mice presented with a situation in which they must move toward a perceived threat in order to receive a reward We created an arena with a safe area and an open area that housed both a food pellet as a reward and a semi-realistic robot predator that simulated a risky situation We analyzed the behavior of mice in this system to test whether the mice would overcome their fear in order to obtain the food pellet We found that the food-restricted mice were significantly more likely to approach the predator than the control mice We also discovered that the mice never overcame their fear of the predator, as there was not a significant change in the likelihood of the
mice approaching the predator as trials progressed Preliminary mesoscope data was also successfully collected during these trials By creating a system to provide a semi-realistic predator-prey interaction while simultaneously performing live brain imaging of mice, researchers will be able to see the triggers and activity in the amygdala when confronted with the choice of taking a risk in order to obtain a reward.
Robogator
We created a Robogator using the Lego Mindstorms EV3 kit. We used the instructions on how to build a Robogator supplied with the Lego Mindstorms NXT kit (Robogator, n.d.). Some slight modifications were made, as the Intelligent Brick in the EV3 kit is slightly bulkier than the Intelligent Brick in the NXT kit and the motors are shaped slightly differently. We reduced the size of the wheels that are at the bottom of the Robogator because the wheel that is suggested in the instructions would force the legs of our model to not touch the ground Also, we added additional wheels onto the bottom of the Robogator to assist it in moving. We coded the Robogator to surge forwards 15 inches once its sensors detect an object in the range of 19.5 inches.
We also used the ELEGOO Uno R3 Project Smart Robot Car (RC car) Kit V 4 0 (With Camera) to act as an alternative to the Robogator Because the kit came with set-coded features such as obstacle avoidance, line tracking module, and infrared remote control, we modified the pre-existing code for the obstacle avoidance module The lines of code were edited in Arduino using C++ coding. We edited the code in lines 662-738 in the ApplicationFunctionSet xxx0 cpp file to change the code from having the car avoid an obstacle to having the car move forward 40 cm when an obstacle came into a range of 50 cm
Ava Jaffe and Romy Peterson
We designed and built a 55” x 20” x 12” arena to perform our experiments in (Figure 1) We cut out each side of the arena from 24” x 36” x ¼” sheets of acrylic using a jigsaw. We used a file to soften any ridges or bumps formed when cutting to allow the sheets to be glued Because the base and two of the walls were longer than the available acrylic sheets, we designed a puzzle piece joining that allowed the two sheets to be connected and glued together. We designed the joints using SolidWorks (Dassault Systems) to make our cuts more precise For the walls, we made two triangle shapes that were two inches tall and two inches wide and were connected at the ends Since the walls are 12 inches tall, each triangle started four inches in from the side. For the base, we cut out two triangle shapes that were three inches tall and three inches wide We placed each triangle five inches in from the side leaving a four-inch gap between the two triangles We used a vertical saw t o cut out the pieces and used epoxy resin (Gorilla Glue) to fill in any uneven gaps We then glued the sheets together using Weld-On 4 (SCIGRIP), an acrylic glue. We added eight-inch by eight-inch tall inserts to act as a hiding place for the mice The inserts were placed eight inches in from one end of the arena and left a four-inch gap in the middle for the mice to run through A silicone mat (Infione) was cut out and placed along the floor of the arena to cover any gaps in the puzzle piece joints that may interest the mice

We created a trapdoor out of acrylic that would block the gap between the inserts in order to
confine the mice in the hiding area before each trial started Using a linear actuator paired with Arduino, we created a contraption to lift the trapdoor. We designed a case to hold up the linear actuator and suspend it on the pole above the arena using SolidWorks We combined three codes to allow the linear actuator to be controlled by remote: pushing the button “2” made the actuator extend the arm and pushing the button “1” retracted the arm of the actuator. The circuit was connected to an Arduino Uno with a Dual Motor Driver, an IR sensor, and a power source.
All care and handling of vertebrate animals, specifically transgenic mice, was conducted by trained researchers. The animals used at the Biosensing Biorobotics Lab in the University of Minnesota’s Mechanical Engineering Program were housed and handled according to an approved IACUC procedure Transgenic mice carrying a CaMP6f gene fused to enhanced GFP and driven by a Thy1 promoter were used to enable live cortical imaging in the brain (Rynes et al., 2021). The “Mini-Mscope'' imaging device the researchers used was designed to fit the mouse’s head and body since the original mesoscope was designed for rats. All animal experiments were conducted in accordance with protocols approved by the University of Minnesota’s Institutional Animal Care and Use Committee (IACUC) All restrictions were performed to comply with IACUC guidelines The typical daily amount of food was estimated in accordance with IACUC rules During the time of food restriction, the animal handlers placed the appropriate logging card with the amount of food given and notified the appropriate supervisor, veterinarian, or veterinary technician that they were beginning food restriction For this chronic, >24 hr restriction, mice were weighed at least once weekly, and body condition scores and mouse behavior (e g grooming, fluid consumption, loss of appetite, etc ) were closely monitored for each mouse. C57BL/6J and Thy1-GCaMP6f mice were used in the experiments Both male and
female mice were used, aged 8-30 weeks. Mice were housed in a 14-hour light / 10-hour dark cycle at 20-23°C and 30-70% relative humidity Control mice had ad libitum access to food and water (Rynes et al , 2021) Experimental testing done with the mice was conducted by lab professionals, in order to adhere to IACUC protocols
Initially, trials were conducted with the Robogator, however, the final trials were conducted with the RC car Trained researchers placed the mouse in the safe zone and placed a food pellet in front of the Robogator or the RC car but out of its range of motion We then observed the mouse and recorded its behavior via video camera and its brain activity via mini-mScope Initial testing involved running eight trials in total for three food-restricted mice and three control mice to track their behavior toward the RC car Each trial ended after three minutes or when the mouse obtained the food pellet
Mesoscope data was recorded simultaneously during the initial behavioral trials. Each trial ran for three minutes or until the mouse obtained the food pellet This was repeated three days in total, with 2-3 trials performed per day, to collect eight trials in total per mouse. Videos of mouse behavior were captured in avi format using an overhead camera (ELP USB8MP02G-L75, ELP). Mice were tracked using either Zebtrack46 software in MATLAB or using Deeplabcut47, and each trial was manually verified to ensure tracking accuracy.
We used DeepLabCut (DLC), an artificial intelligence software, to label and track different parts of each mouse in videos of the trials For each trial, the video was uploaded to DLC in .avi form. Once uploaded, 150 random frames were selected from the clip, and we labeled the mice in each frame. The parts of the body labeled included the nose, the meso (in between the nose and the ears), between the ears, the left and right front paws, the shoulders, the left and right hind
paws, the hip bones, and the start of the tail. Once the labeling of the frames was completed, DLC generated a model of the mouse and produced a video of the model-tracked mouse, including the labels of the different body parts If the model was inaccurate, more frames were labeled and another video was produced. In the trials reported here, we specifically assessed the movement of the nose, meso, and ears, as well as ti me spent in the nesting and foraging areas of the arena We analyzed the result in Microsoft Excel using ANOVA with Two-Factor replication.
In conjunction with behavior tracking, we analyzed data collected from the “Mini-Mscope'' imaging device. Cortical regions of interest were selected within each video trial by removing the background and seed pixels within six regions were selected for further analysis. Cortical regions were selected by imposing a post-surgery image onto a map extracted from “Brain Explorer 2” (Liu et al , 2022) Seed pixel correlation maps were generated using Pearson’s correlation coefficient (PCC) to compare the correlation between a desired seed pixel and other pixels in the field of view (FOV) Data from the behavior tracking was used to generate a list of frame numbers where the mouse was either moving or still To calculate PCC during these discontinuous periods of time, a moving window of 1 s with a 0 5 s sliding window was incorporated between small clusters of continuous behavior. The PCC between the seed pixel trace and every other pixel in the desired regions of the cortex was calculated for each window length portion. The mean of all the PCCs was computed and stored as the PCC value for each pixel in the FOV This process was repeated for each trial and mouse to generate representative seed pixel maps for one trial The PCC values between the chosen seed pixels were averaged across all trials in spontaneous free behavior to generate the inter-seed correlational plots
We initially performed trials with non-food-restricted mice challenged with the Robogator However, we found that the mice didn’t approach the food and did not avoid the Robogator and, instead, would approach, touch, and sniff it. We tried adding a roaring sound to the Robogator when the mouse was detected and increasing the speed of lunging, but these did not cause the mice to avoid the robot. We concluded that the Robogator’s response was too slow, due to the fact that the software used for processing in Lego Mindstorms couldn’t immediately transfer over to the robot, meaning the program took longer to run We subsequently replaced the Robogator with an Arduino-based RC Car, since the RC Car could move more quickly. Arduino is also a more advanced system that allows more control over the code and actions of the RC car. We found that the RC Car would scare away the mice and they would less frequently approach the food. However, the mice still wouldn’t eat the food. A protocol was already in place at the lab to safely food-restrict mice for behavioral research. We decided to try these mice to see if they would be more motivated to take the food. We found that food restriction, combined with the use of the RC Car, caused most mice to attempt stealing the food while still running away when the RC Car lunged at them
For the initial behavioral trials, three food-restricted and three non-food-restricted mice were placed in the arena with a food pellet and RC car for three minutes or until they retrieved the food pellet Their behavior was tracked by a camera mounted above the arena The arena is divided into separate zones that are each analyzed (Figure 2) The “safe area” is where the hiding zone is which allows the mice to hide from the robot, the “decision area” is where mice are forced to decide if they want to go for the food, the “explore area” is where the mice move around the arena and get a feel for the surroundings, the “food area” is where the
food pellet lies, and the “attack area” is where the robot lies and attacks the mouse Eight trials were conducted per mouse, however, one of the middle trials was omitted, since none of the mice from either group moved out of the start region

Figure 2. Example of time spent in each area by a mouse (Adapted from image provided by the Kodandaramaiah lab)
There was no significant difference (p>0.05; ANOVA) in the amount of time mice spent in the safe, decision, food, or explore regions over the course of the trials in either the control or food-restricted groups There was also no significant difference between the control and food-restricted groups (p>0.05; ANOVA) in the amount of time mice spent in these regions
The average percent of time spent in the attack zone, the zone where the food pellet lies and the robot attacks, was significantly higher for the food-restricted mice as compared to the control mice (n=21 per treatment group; p<0.0001; ANOVA; Figure 3) There was no significant difference in the average amount of time spent in the Attack zone between trials for the food-restricted mice across the seven trials (p>0.05; ANOVA; Figure 3). The average amount of time spent in the Attack zone varied between the trials but did not significantly correlate with an increasing number of trials in either the food-restricted (r = -0.08; p>0.05; Pearson correlation) or control mice (r = -0 164; p>0.05; Pearson correlation) (Top Tier Bio, 2019).

Figure 3. Average percent of trial time in the attack zone of control (n=3) and food-restricted (n=3) mice
Preliminary Mesoscope Trials
Mesoscope data was collected simultaneously during the behavioral trials where three food-restricted and three non-food-restricted mice were placed in the arena with a food pellet and RC car for three minutes or until they retrieved the food pellet The brain activity of mice was recorded by the “Mini-Mscope'' imaging device (Rynes et al., 2021).
The brain activity of the mice in different areas of the arena was visualized as the change in fluorescence as a percentage, with dark red signifying a 2% increase in fluorescence and dark blue signifying a 2% decrease in fluorescence (Figure 4). There were notable differences in activation patterns between the mice and in different areas of the arena. In the example included here (Figure 4), overall activation levels of the brain appear to be higher when in the attack zone for the control mouse than for the food-restricted mouse. Conversely, overall activation levels appear to be lower in the food zone for the food-restricted mouse. However, these results are preliminary, as a full statistical analysis has not yet been completed

Figure 4. Activation of the brain of control and food-restricted mice while residing in each area of the arena (Adapted from image provided by the Kodandaramaiah lab)
We successfully developed a system to study what happens in the brains of mice when they overcome their fears The arena was able to simulate a situation in which mice were confronted with an opportunity to overcome their fear while we tracked their behavior and collected data on their brain activity We found that there was a significant difference in the amount of time spent risking attack for the food-restricted mice versus the control mice, but no significant difference in the amount of time spent approaching the food as the trials progressed This suggests that the mice never extinguished their fear of the predator, however, they were still willing to take a risk in order to obtain the food pellet Although we hypothesized that the food-restricted mice would be more likely to take risks than the control mice, we were surprised that the mice did not become habituated to the predator. In the preliminary mesoscope data, there appeared to be some differences in brain activity between the food-restricted and controlled mice. However, statistical analysis of this data is still in progress, so no formal conclusions can be made at this time.
Initial behavioral trials only tested three mice per treatment group. This small number may have affected our ability to identify additional significant trends in their behavior In addition, the data from one trial had to be omitted as none
of the mice moved out of the starting area during this trial, although we could not identify a cause for this outlier It is possible that there are additional confounding variables within the testing procedure that still need to be addressed in order to elicit a more standardized response In addition, we noticed that, even when switching to the RC Car, the mice still would explore the robot and find ways to avoid its attacks.
In the future, we would like to incorporate a robot that more closely resembles an actual predator in the wild This could entail using a taxidermied animal skin over the robot so the robot appears more like a predator and adding sounds to the robot This could also include adding chemical cues emitted from a predator onto the robot to trigger the olfactory systems of the mouse We would also like to try testing to see how competition with another mouse would affect how likely the mice are to take a risk and how this would change what areas of their brain are activated during the trial We would be interested to see if the competition would make them more likely to try and obtain the food pellet We would also like to use the same mice for more trials, as well as testing additional mice This way we could see if habituation occurs and the increased data points would reduce the impact of outliers on our data. Finally, mesoscope data analysis is still in progress and will hopefully yield insights into the difference in brain activation between conditions and trials
We found that the mice were more likely to take the risk when it was more necessary for their survival. We also found that, over time, the mice did not become habituated to the predator Our results raise the question of whether humans, like the mice, are ever able to truly eradicate their fears or, rather, must become better at overcoming their fear every time they experience a fearful situation. If this hypothesis is supported by further research, it could deepen our knowledge of how to aid those who seek help with overcoming their fears. This could lead to
Ava Jaffe and Romy Peterson
better treatments for anxiety and other mental disorders that directly enhance or focus on specific areas of the brain that are involved in overcoming fear.
We would like to thank Dr Kati Kragtorp for her support throughout the project We would also like to thank Dr. Suhasa Kodandaramaiah for granting us the opportunity to perform this research Finally, we would like to thank Daniel Surinach and Mathew Rynes for overseeing us and helping us out throughout our research
Research involving non-human vertebrate animals was conducted under the supervision of an experienced researcher and followed state and federal regulatory guidance applicable to the human and ethical conduct of such research.
024276 GP5 5 Strain Details (n d ) Retrieved September 27, 2022, from https://www jax org/strain/024276
Adolphs, R (2013) The Biology of Fear Current Biology, 23(2), R79–R93 https://doi org/10 1016/j cub 2012 11 055
Alfa. (2019, September 13). Servo Motor Control with Remote. Arduino https://create arduino cc/projecthub/Raushancpr/servo-motor-contr ol-with-remote-fd6d95?ref=search&ref id=control%20servo%20m otor&offset=6
Büchel, C (2000) Classical fear conditioning in functional neuroimaging Current Opinion in Neurobiology, 10(2), 219–223 https://doi org/10 1016/S0959-4388(00)00078-7
Chan, G (2015, April 5) Using MDD10A with ARDUINO UNO Cytron Technologies https://tutorial cytron io/2015/04/05/using-mdd10a-arduino-uno/
Choi, J -S , & Kim, J J (2010) Amygdala regulates risk of predation in rats foraging in a dynamic fear environment Proceedings of the National Academy of Sciences, 107(50), 21773–21777 https://doi org/10 1073/pnas 1010079108
Gafford, G M , & Ressler, K J (2016) Mouse models of fear-related disorders: Cell-type-specific manipulations in amygdala Neuroscience, 321, 108–120 https://doi org/10 1016/j neuroscience 2015 06 019
How to use the HG7881 (L9110) Dual Channel Motor Driver Module (n d ) Banana Robotics
Janak, P H , & Tye, K M (2015) From circuits to behaviour in the amygdala. Nature, 517(7534), 284–292. https://doi org/10 1038/nature14188
Lesting, J , Narayanan, R T , Kluge, C , Sangha, S , Seidenbecher, T., & Pape, H.-C. (2011). Patterns of Coupled Theta Activity in Amygdala-Hippocampal-Prefrontal Cortical Circuits during Fear Extinction PLoS ONE, 6(6), e21714 https://doi org/10 1371/journal pone 0021714
Liu, C H , Koire, A , Erdei, C , & Mittal, L (2022) Subjective social status, COVID-19 health worries, and mental health symptoms in perinatal women SSM - Population Health, 18, 101116 https://doi org/10 1016/j ssmph 2022 101116
Ludvig, E A , Madan, C R , Pisklak, J M , & Spetch, M L (2014) Reward context determines risky choice in pigeons and humans Biology Letters, 10(8), 20140451 https://doi org/10 1098/rsbl 2014 0451
Robogator (n d ) Retrieved June 15, 2022, from http://www chrismart byethost15 com/Lego%20Designs/robo%20g ator pdf?i=2
Rynes, M L , Surinach, D A , Linn, S , Laroque, M , Rajendran, V , Dominguez, J , Hadjistamoulou, O , Navabi, Z S , Ghanbari, L , Johnson, G W , Nazari, M , Mohajerani, M H , & Kodandaramaiah, S B (2021) Miniaturized head-mounted microscope for whole-cortex mesoscale imaging in freely behaving mice Nature Methods, 18(4), 417–425 https://doi.org/10.1038/s41592-021-01104-8
Top Tier Bio (Director) (2019, March 12) How To Perform A Pearson Correlation Test In Excel https://toptipbio.com/pearson-correlation-excel/
Sydney McDaniel
Introduction
Birthing and maternal health disparities in society are a wider reflection of the racial health inequities across every domain of healthcare (Matoba & Collins, 2017). When maternal care is affected, all realms have been affected. A significant inequity lies between the mortality rates of White infants and mothers, and Black infants and mothers in the United States. Black babies die at over twice the rate of White babies (Gillespie et al., 2022). Black infant deaths are commonly associated with low birth weight (LBW) or small gestational age (SGA) as a result of preterm birth (PTB). In contrast, White infants typically die from congenital abnormalities (Matoba & Collins, 2017) While these conditions have a direct impact on the mortality risk of infants, an expanding body of research now provides evidence that exposure to racial discrimination in the United States - both interpersonal and environmental - contributes to the heightened risk (Matoba & Collins, 2017)
Black Americans live a unique experience. Studies have found that by being born through the complex racist structure of American society, they are more affected by American healthcare disparities than Foreign-born Black people who migrated later to the United States (Chantarat et al., 2022). This data is thought to reflect how Black Americans are exposed to more racial discrimination over the course of their entire lives. In the face of systemic racism, one of the greatest threats is discrimination in law enforcement Police brutality and its causal unrest are a leading cause of mental and physiological stress in Black bodies (Hardeman et al , 2021) Stress and anxiety force the human body into a fight-or-flight state. In response to

this reaction, the body is internally inflamed with biological markers expressing the inflammatory response (Gillespie et al , 2022) When people live through repeated exposure to racism and its psychological effects, their body remains inflamed Consequently, it causes the body to wear faster, leaving Black people more vulnerable to common diseases such as diabetes, hypertension, and heart disease, and ultimately, a shorter estimated life expectancy For Black mothers and their babies, inflammation leads to a higher possibility of LBW, SGA, and PTB, all of which impact the mortality imbalance (Hardeman et al., 2021).
Previous studies have explicated clear correlations between policing and adverse birth effects in all women, regardless of race or ethnic origin. Furthermore, they have shown a clear negative impact on the risk of PTB and LBW for Black American infants whose mothers are impacted by structural racism and interaction with the police (Chantarat et al , 2022) In a study of data from 2016, Dr. Rachel Hardeman found that US-born Black (US-Black) women in Minneapolis with higher levels of police contact were more likely to experience adverse birth outcomes than White women, or even Foreign-born Black women (Hardeman et al , 2021). However, since this study was conducted, the COVID-19 pandemic and the murder of George Floyd have greatly impacted the Minneapolis community (Healy & Searcey, 2020).
It is necessary to gather more data to further solidify the picture of how pieces of structural racism impact Black maternal health due to the growing gap in the birthing community, as it affects all racial healthcare inequity. I analyzed Sydney McDaniel
2020 data from the Minneapolis Police Department, the Minnesota Department of Health, and the American Community Survey, to investigate the relationships between race, demographics, police interaction, and birthing outcomes for US-born Black, Foreign-born Black and White mothers living in Minneapolis communities
Three sets of data were used in this analysis They were collected from the Minneapolis Police Department (MPD), the Minnesota Department of Health (MDH), and the American Community Survey (ACS), respectively. All health data was de-identified, while the MPD data was publicly available Data from the MDH included birth outcome data on whether infants experienced preterm birth (PTB) or low birth weight (LBW) for births in Minneapolis, as well as the age, marital status, method of payment, and area of residence of the mothers The MPD Use of Force Data came from the publicly-available Use of Force da tabase, a report of the geolocation of police-citizen contacts from 2012-2020 Data from the American Community Survey (ACS) included both census demographic data and socioeconomic information from the years 2010-2014 and 2015-2019.
All data was uploaded to a Norway remote server and analyzed using the STATA program (Statistical Software for Data Science | Stata, n d ) Data was cleaned to remove empty datasets and coded for analysis Percentages or means and standard deviations were calculated for all relevant variables with respect to areas with low, medium, and high police contact Low, medium, and high typologies are the police Use of Force (UOF) 8-year tract averages of police use of force incidents per 1,000 tract residents, broken down into thirds. Low represents less than or equal to 1 5 police UOF incidents per 1,000 tract residents, Medium represents between 1.51 and 12.99 police UOF incidents per 1,000 tract residents, and High represents greater than or equal to 13 police UOF incidents per 1,000 tract residents. A Chi-Square analysis
was performed in STATA to determine significant differences between variables in the dataset
Descriptive statistics and comparison within US-Black participants
The US-born Black individuals were separated into the police UOF tracts - low, medium, and high - based on their geographic census data. Comparisons were made between the tracts The percent of US-born Black individuals affected by PTB was significantly higher for those living in high tracts versus those who were living in low or medium tracts (p<0.0001). The majority of US-born Black mothers were ages 20-24, unmarried, and on Medicaid The individuals living in high police UOF tracts experienced significantly lower birth weights than those living in low police UOF tracts Of those living in high police UOF tracts, a significantly high percentage were also living in majority non-white neighborhoods Level of income was also significantly lower in high police UOF tracts, and the number of reported violent crimes was significantly higher (p<0 0001)
Descriptive statistics and comparison within Foreign-born-Black participants
The Foreign-born Black individuals were separated into police UOF tracts - low, medium, and high - based on their geographic census data. Comparisons were made between the tracts The percent of Foreign-born Black individuals affected by PTB was significantly higher for those living in high tracts versus those who were living in low or medium tracts (p<0.01). The majority of Foreign-born Black mothers were between the ages of 25-29, unmarried, and on Medicaid The individuals living in high tracts experienced significantly lower birth weights than those living in low tracts (p<0 0001) Of those living in high-contact tracts, a significantly low percentage were married. Furthermore, foreign-born Black mothers in high UOF neighborhoods also reported living in majority non-white neighborhoods. The level of income was also
significantly lower in high UOF tracts. The number of reported violent crimes was significantly higher in high UOF tracts (p<0.0001).
Descriptive statistics and comparison within White participants
The White individuals were separated into police UOF tracts - low, medium, and high - based on their geographic census data Comparisons were made between the tracts The percentage of White individuals affected by PTB was significantly higher for those living in high tracts versus those who were living in low or medium tracts (p<0.0001). The individuals living in high tracts experienced significantly lower birth weights than those living in low tracts The majority of White mothers were between the ages of 30-34, were married, and had private insurance Of those living in high contact tracts, a significantly high percentage were living in majority non-white neighborhoods (p<0 0001) The level of income was also significantly lower in high UOF tracts. The number of reported violent crimes was significantly higher in high UOF tracts (p<0 0001)
Birth outcome comparisons between demographic groups
The average incidence of PTB was 6 96% for White individuals (34,933 pregnant people), 8.42% for US-born Black individuals (2,543 pregnant people), and 7 38% for Black individuals born outside the US (6,297 pregnant people). The PTB rates for US-born Black participants in areas of low, medium, and high UOF were 5 53%, 6 94%, and 10 99%, respectively. The rates for White participants were 6 28% 6 77%, and 7 82% The rates for Foreign-born Black participants were 6 24%, 6.59%, and 8.79%. Overall, the average rates of PTB were 8 42% for US-born Black individuals, 6 96% for White, and 7 38% for Foreign-born Black (Figure 1). The PTB rates were significantly different between residents in low, medium and high police UOF areas for White (p<0.0001), US-born Black (p<0.0001) and Foreign-born Black (p<0 01) participants
Sydney McDaniel

Figure 1. Percentage of preterm births across demographic groups residing in areas with low, medium or high police UOF averages Figure by author
The average birth weight values (g) for US-born Black participants living in tracts with low, medium and high UOF averages were 3371 g, 3315 g, and 3153 g, respectively. The averages for White participants were 3414 g, 3362 g, and 3296 g, respectively The averages for Foreign-born Black participants were 3381 g, 3331 g, and 3238 g, respectively (Figure 2) The average birth weights were significantly different between residents in low, medium and high police UOF areas for White (p<0 0001), US-born Black (p<0 0001) and Foreign-born Black (p<0.001) participants.

Figure 2. Average birth weights (± s.d.) across demographic groups residing in areas with low, medium or high police UOF averages Figure by author
Proportion of UOF Residency between demographic groups
The percentage of US-born Black individuals living in low, medium, and high UOF police neighborhood tracts was 25%, 30%, and 45%, respectively The percentage of White
participants was 32%, 34%, and 34%. The percentage of Foreign-born Black participants was 26%, 34%, and 40% (Figure 3) The percentage of White, Foreign-born Black and US-born Black groups that lived in low, medium or high police UOF areas was significantly different across all groups (p<0.0001). The US-born and Foreign-born Black participants were both significantly less likely to live in low-contact neighborhoods and were significantly more likely to be in high police-contact neighborhoods as compared to White participants (p<0.0001).

Figure 3. Percentage of each demographic group residing in areas with low, medium or high police UOF averages Figure by author
In data presented here from Minneapolis, MN in 2020, residence in a high police UOF neighborhood was significantly associated with PTB for both White and US-born Black individuals, but not Foreign-born Black individuals. Residence in high police UOF areas was also significantly associated with lower birth weight for all three racial groups Income level, majority non-white tracts, and number of reported violent crimes also shared significant associations with police UOF for all three racial groups. Importantly, the percentage of Foreign-born Black and US-born Black individuals residing in medium or high police UOF tracts was significantly higher than that of White individuals
When considering the results from 2020, it is important to also consider the 2016 study by Hardeman et al. (Hardeman et al., 2021). In this
study, it was reported that police contact was associated with preterm birth for both Black and White pregnant people, as shown in the 2020 study. The 2016 PTB rates were 6.7% for white mothers, 14% for US-born Black mothers, and 5 7% for Foreign-born Black mothers In the 2020 data, the rates were 6.96%, 8.42%, and 7 38% respectively The rates appear to increase for white and Foreign-born black mothers, but appear to decrease by nearly 50% for US-born Black mothers This decrease may be the signs of positive effects of policy reform or other clinical improvements, but the reason for the decrease in US-born Black rates remains largely unknown It too is important to include that there was a much smaller population of mothers (n=1059) in the 2016 study, in which only 121 were US-born Black individuals This number is much smaller than the 2,543 US-born Black mothers included in the data from 2020, so the difference could represent variability due to small sample size. The 2016 study also showed that in areas with high police contact vs low police contact, the odds of preterm birth were 90% higher for White individuals (odds ratio [OR], 1 9; 95% CI, 1 9-2 0), 100% higher for US-born Black individuals (OR, 2 0; 95% CI, 1.8-2.2), but only 10% higher for Black individuals born outside the US (OR, 1 1; 95% CI, 1 0-1 2; Hardeman et al , 2021) In the 2020 data, US-born and Foreign-born Black participants were both significantly less likely to live in low-contact neighborhoods, and were significantly more likely to be in high police-contact neighborhoods as compared to White participants The data appear to illustrate some changes in trends between the two studies, but further analysis and additional studies are needed to determine whether these are significant differences that point to real shifts in PTB risks or if these changes are representative of normal variations
The data presented here demonstrates a correlation between high levels of policing and negative birth outcomes and indicates that black mothers, and their babies, are disproportionately exposed to this risk factor. Participants in all three groups, US-born Black, White, and
Foreign-born Black, living in high policing areas were also more likely to reside in majority non-white, low income communities, with higher crime rates. However, only for the US-born Black population were the mother's age and the percentage married not significantly lower as police UOF increases, so these factors do not seem to be contributing to the negative birth outcomes for that population Importantly, the proportion of each racial group residing in these non-white, low-income communities was significantly different The US-born Black participants had a higher proportion of individuals living in these high police UOF, high crime neighborhoods, where they are more likely to be exposed to the associations with the adverse birth outcomes as compared to both Foreign-born Black participants and White participants. Foreign-born Black participants had a higher proportion of individuals living in these high police UOFs as compared to White participants. Therefore, while residence in a high police UOF area is impactful regardless of race, it has an outsized impact on the US-born Black mothers in comparison to Foreign-born Black or White mothers, because they are the most likely to live in high police UOF areas This indicates a connection between systemic racism, police contact and detrimental birth outcomes
Three limitations to this study are worth noting Given the racial demographics of the Minneapolis community, the number of US-born Black participants was much smaller than the White and Foreign-born Black samples, which may affect levels of significance. Higher levels of policing were also consistently linked to lower income levels and higher crime rates between the groups. These are likely to be contributing to the increase in negative birth outcomes, and the analysis method used did not allow determination of the relative contributions of these factors Moreover, it should be acknowledged explicitly that policing is not necessarily the sole cause of adverse birth outcomes, but may be one of many pieces of a racially complex system having effects on the health of future generations.
Future analysis could look closer at the relationships between factors of low-income, crime rates, and policing with respect to their contributions to negative birth outcomes Future research should also look at the impact of policing on birth outcomes today, years after all of the discourse and efforts to improve policing amidst the national restoration of policies. It would be important to see whether the changes taking place are also being represented in the improvement of maternal and infant health. It is also necessary to broaden the study to include more minority female groups Although some of Minneapolis’ most prominent ethnic groups are White and Black, there are also Native and Latina women who face similar staggering disparities in maternal healthcare that Black mothers do On a grand scale, it would be advantageous to see whether or not the effects are the same, worse, or better, in big cities across the various regions of the country
With the growing atmosphere of racial health inequity awareness, it is vital that we take the time to consider what factors are at play beyond the clinical setting. My research brings us a step closer to closing the maternal and infant mortality gap by identifying that areas with intensive policing have clear associations with the health of Black and White babies alike. We see most evidently that the experience of structural racism in the country takes the biggest toll on the health of US-born Black mothers and their children However, their expressions of discomfort and affliction will not be realized without scientific data that demonstrates this to the larger society as a whole Continued scientific research adds weight to the connection between the social and clinical lived experiences of people of color The country’s state of racial development manifests in the health of its mothers and children. All aspects of health inequity must be studied in relation to the social world rather than the purely biological one. It is in these studies that we uncover the real cause behind health issues The studies of maternal
and infant mortality, and health inequity beyond, are a critical part of destabilizing structural racism everywhere
This study and its findings would not have been possible without the support and guidance of Dr Rachel Hardeman, Associate Professor of Division of Health Policy and Management at the University of Minnesota, Dr Anna Hing, Research Associate at the Center for Antiracism Research for Health Equity, and Chris Robertson, Ph D student in Sociology at the University of Minnesota I also would like to thank my professor, Dr. Kati Kragtorp, for her support of my science research endeavors at Breck A final thank you to all participants at the Minnesota State Science Fair.
Chantarat, T , Riper, D , & Hardeman, R (2022) Multidimensional structural racism predicts birth outcomes for Black and White Minnesotans Health Services Research, 57 https://doi org/10 1111/1475-6773 13976
Gillespie, S L , Christian, L M , Mackos, A R , Nolan, T S , Gondwe, K W , Anderson, C M , Hall, M W , Williams, K P , & Slavich, G M (2022) Lifetime stressor exposure, systemic inflammation during pregnancy, and preterm birth among Black American women Brain, Behavior, and Immunity, 101, 266–274 https://doi.org/10.1016/j.bbi.2022.01.008
Hardeman, R R , Chantarat, T , Smith, M L , Karbeah, J , Van Riper, D C , & Mendez, D D (2021) Association of Residence in High–Police Contact Neighborhoods With Preterm Birth Among Black and White Individuals in Minneapolis JAMA Network Open, 4(12), e2130290 https://doi org/10 1001/jamanetworkopen 2021 30290
Healy, J , & Searcey, D (2020, May 31) Two Crises Convulse a Nation: A Pandemic and Police Violence The New York Times https://www nytimes com/2020/05/31/us/george-floyd-protests-cor onavirus html
Matoba, N , & Collins, J W (2017) Racial disparity in infant mortality Seminars in Perinatology, 41(6), 354–359 https://doi org/10 1053/j semperi 2017 07 003
Statistical software for data science | Stata (n d ) Retrieved September 20, 2022, from https://www stata com/
Ivy Miller and Corinne Moran
Is transient expression of DUX4 sufficient to cause muscular dystrophy?
Ivy Miller and Corinne Moran
Introduction
Facioscapulohumeral muscular dystrophy (FSHD) is a genetic, progressive myopathy and the second most common muscular dystrophy. Progression of the disease primarily begins with the weakening and atrophy of facial, shoulder, and upper arm skeletal muscles. However, advancement may affect other parts of the body, causing respiratory and cardiac issues (Schätzl et al., 2021). The disease typically begins presenting in the second decade of a patient's life, though some cases see symptom onset in infancy. Those afflicted with the disease from an early age typically develop a more severe form compared to other patients FSHD has a highly complex pathology, combining mechanics of both genetics and epigenetics. Thus, severity differs from patient to patient, though it does not seem to affect life expectancy (Himeda & Jones, 2019).
There are two main forms of FSHD caused by two different genetic mechanisms: FSHD1 and FSHD2. FSHD1 is the more common of the two, affecting 95% of all FSHD patients, and is caused by a contraction of CpG repeats on the D4Z4 array. This array typically consists of 11-100 repeat units but is contracted to 1-10 repeat units in FSHD1 patients FSHD2 affects about 5% of all patients and is most commonly caused by a mutation in the gene SMCHD1, leading to another contraction of repeats (Himeda & Jones, 2019; Le Gall et al., 2020). Despite these differences, both mechanisms lead to the derepression of the double homeobox protein 4 gene (DUX4). Aberrant expression of DUX4 in muscle cells is widely believed to be the primary cause of the FSHD phenotype (Bosnakovski et al., 2008).

Normally only expressed during the cleavage stage in embryonic development, as well as the testis and thymus, DUX4 is epigenetically repressed by the D4Z4 repeat (Yoshihara et al., 2022). When that repeat is contracted, the gene is no longer repressed and initiates this same program in muscle cells (myoblasts). The DUX4 gene codes for both a short form DUX4 (DUX4-s), which does not activate DUX4 target genes, and a full-length DUX4 (DUX4-fl), which activates DUX4 target genes (Bosnakovski et al , 2020) This is because the C-terminus, which is not present in DUX4-s, is the transcriptional activator domain of the gene (Choi et al , 2016) The target genes that DUX4-fl activates are assoc iated with cell death, oxidative stress, muscle generation and growth (myogenesis), epigenetic regulation, and multiple other skeletal muscle pathways (Bosnakovski et al., 2008). Main DUX4 target genes include MBD3L2, DUXA, and TRIM43, which are transcription factors regulating gene expression. Since DUX4 is only expressed transiently and at very low levels, the protein itself is almost undetectable in the muscle cells of FSHD patients. Consequently, researchers routinely use the activation of DUX4 target genes to detect the expression of DUX4 itself (Lim et al., 2020).
Most animal models of FSHD are in mice, though xenograft, Drosophila, and zebrafish models have been developed as well. However, animal models have proved more difficult to develop than cell models because of the cytotoxic nature of DUX4 (Le Gall et al., 2020). As most of these models are used to explore future therapeutic treatments, they are necessary for FSHD research. However, none of these models faithfully recapitulate the DUX4 promoter, DUX4 mRNA, and DUX4 protein, or
fully represent disease progression. As DUX4 is a primate-specific gene, expression in non-primate organisms causes cytotoxicity and death. In recent years, researchers have mitigated this issue by creating inducible animal models to control the level and duration of DUX4 expression such that the animal survives the testing period (Le Gall et al., 2020) However, these inducible animal models have proved unreliable. The mouse model iDUX4 created a leaky expression of DUX4, meaning the gene activated not only in muscle cells but uncontrollably in other parts of the mouse as well (Dandapat et al., 2014). To fix this leaky expression, this group turned to the iDUX4pA-HSA mouse model, which eliminated the leaky expression, but raised another issue, as the majority of muscle cells were not positive for DUX4 expression (Bosnakovski et al., 2017).
Though animal models are useful, cell models have the advantage of helping researchers study how DUX4 works on the cellular level with greater precision. This creates a better platform to work toward recapitulating DUX4 expression levels in different human types of myoblasts and fibroblasts. The Kyba lab developed an iDUX4 cell model in which DUX4 is induced by doxycycline, an antibiotic that binds to the gene promoter. Previous experiments used the cell line C2C12, a murine cell line, in order to induce DUX4 expression and follow the disease. The issue with this approach is that DUX4 is not typically induced in mice, so some interactions of DUX4 in human cells are not present in murine cells, and thus this is not a perfect recapitulation of the human disease (Bosnakovski et al., 2008). These studies have used this inducible cell line approach to research DUX4’s expression platform, signaling pathways, and transcriptional activity. A common setback is that after cells are pulse induced for DUX4 expression, they only survive for about 48 hours, because of the gene’s cytotoxicity (Bosnakovski et al., 2019).
We developed a transient cell assay of DUX4 in vitro, using the human myoblast cell line LHCN #3 iDUX4, to investigate the long-term
expression of DUX4 target genes while attempting to avoid cytotoxicity We found that a 30-minute exposure to DUX4 was sufficient to continually activate target genes in the human myoblast cell line LHCN #3 for at least four days This research represents an important step toward clarifying the mechanism behind FSHD and eventually developing effective FSHD therapies
Immortalized human myoblast LHCN #3 iDUX4 cell lines were cultured in myogenic proliferation media [F10 (HyClone) supplemented with 20% fetal bovine serum (FBS; PeakSerum, Ps-FB3, lot 293Q16), 1× 2mercaptoethanol (Gibco), 10 9 M dexamethasone (Sigma-Aldrich), basic fibroblast growth factor (10 ng/ml; PeproTech), GlutaMAX (Gibco), and penicillin/streptomycin (Gibco)], at 37°C in a 5% CO2 atmosphere (Bosnakovski et al, 2016)
The immortalized human myoblast LHCN #3 iDUX4 was developed from an immortalized LHCN-M2 cell line obtained from V Mouly (Toral-Ojeda et al., 2018), and transduced with a single copy of DUX4 downstream of a second-generation tet response element, as described (Choi et al., 2016).
Cells were plated in T-75 flasks with the media being changed every 3 days until they were confluent enough to plate. Once the cells were confluent, they were plated in 12, 24, 48, or 96 well plates
After reaching confluence, DUX4 expression was induced in the LHCN iDUX4 cell line by adding a combination of myogenic media and 50 ng/ml of doxycycline (Sigma Aldrich). A negative control was set up with no doxycycline pulse and then incubated until data collection while a positive control was set up with a doxycycline pulse and incubation until data collection. The experimental group was pulsed
with 50 ng/mL doxycycline for 30 minutes in the incubator for the pulse After 30 minutes, the doxycycline from the experimental group was replaced with just myogenic media and the positive control continued with the 50 ng/mL doxycycline
RNA extraction
RNA was extracted directly from the plate at 24 hours, 48 hours, 4 days, 7 days, 10 days, and 14 days. Plates of cells were prepared for RNA extraction by aspirating the media and treated with 450 ng/µl lysis buffer and 450 ng/µL ethanol. The lysate was then transferred to filter tubes and RNA was extracted using the Quick RNA mini-prep kit (Zymo Research), according to the manufacturer's instructions.
cDNA synthesis
cDNA was synthesized from the extracted RNA using the Verso kit (Thermo Fisher Scientific) with 4 µL of 5x buffer, 2 µL of dNTP, 1 µL of Oligo, 0 5 µL of RT enhancer, and 0 5 µL of RT enzyme per same, and 12 µL of water and RNA. The resulting solution was placed in a thermocycler at a cycle of 42°C for 1 hour, and 95°C for 2 minutes, then held at 4°C.
qPCR
The c DNA was prepared for qPCR using the Terra qPCR direct TB Green Premix (Takara), and gene expression was measured with commercially available probes: ZSCAN4, Hs00537549 m1; MBD3L2, HS00544743 m1; CDK1A, Hs00355782 m1; B2M, Hs99999907 m1 (Applied Biosystems) Gene expression levels were normalized to B2M and analyzed with 7500 System Software (Applied Biosystems)
Activation of DUX4 expression
In a 12-well plate, there were three wells per treatment group of LHCN iDUX4 cells continuously treated with 50 ng/mL doxycycline, three wells pulsed with 50 ng/mL doxycycline for 30 minutes, and another three
Ivy Miller and Corinne Moran
wells left untreated as a negative control. Previous, unpublished work has established that 50 ng/mL is sufficient to activate DUX4 expression. After 48 hours, treatment groups were observed to have varying levels of confluence and cell death, as seen by the amount of dead cells floating in the medium. The untreated cells remained confluent, the cells treated with a 30-minute doxycycline pulse were less confluent and saw some cell death, and the cells continuously treated with doxycycline saw mass cell death (Figure 1)

Figure 1. Light microscopy of (from top to bottom) a negative control with no doxycycline added, the experimental group with a 30-minute doxycycline treatment, and the positive control with continuous doxycycline treatment after 48 hours (Photo by authors)
MBD3L2
Levels of MBD3L2 mRNA were assessed in cells collected at six time points of 24 hours, 48 hours, 4 days, 10 days, and 14 days after the doxycycline pulse Levels of MBD3L2 mRNA
were significantly higher in treated cells as compared to untreated cells at the 24-hour (p<0 001), 48-hour (p<0 0001), and 4-day (p<0.05) time points, (Figure 2A). In the treated cells, MBD3L2 expression levels significantly decreased from 24 to 48 hours (p<0 01), from 48 hours to 4 days (p<0.0001), and from 4 days to 7 days (p<0.05). Levels of MBD3L2 mRNA were not significantly different between treated and untreated cells at 7 days, 10 days, and 14 days after DUX4 activation (Figure 2B) In addition, there was a significant decrease in untreated cells from 24 hours to 48 hours (p<0.01) and 48 hours to 4 days (p<0.0001) (Figure 2).

Figure 2. Levels of DUX4 target gene MBD3L2 mRNA with (blue) and without (orange) a doxycycline pulse. (A) Cells collected at 24 hours, 48 hours, 4 days, 7 days, 10 days, and 14 days. (B) Detail of cells collected 4 days, 7 days, 10 days, and 14 days.
Levels of DUXA mRNA were assessed in cells collected at six time points of 24 hours, 48 hours, 4 days, 10 days, and 14 days after the doxycycline pulse. Levels of DUXA mRNA were significantly higher in treated cells as compared to untreated cells at the 24-hour
(p<0.001), 48-hour (p<0.0001), and 4-day (p<0 05) time points (Figure 3A) In the treated cells, DUXA expression levels significantly decreased from 24 to 48 hours (p<0.001), and 48 hours to 4 days (p<0.0001). Levels at 7 days were not significantly different and neither were they at 14 days between treated and untreated groups, but there was a significant difference (p<0 05) in DUXA 10 days after DUX4 activation. At this point, the levels of untreated cells were actually higher than those of the treated cells, unlike the prior time points (Figure 3B). In addition, there was a significant decrease in untreated cells from 24 hours to 48 hours (p<0 05), 48 hours to 4 days (p<0 01), and 10 days to 14 days (p<0.05) (Figure 3).

Figure 3. Levels of DUX4 target gene DUXA mRNA with (blue) and without (orange) a doxycycline pulse (A) Cells collected at 24 hours, 48 hours, 4 days, 7 days, 10 days, and 14 days (B) Detail of cells collected 4 days, 7 days, 10 days, and 14 days.
Levels of TRIM43 mRNA were assessed in cells collected at six time points of 24 hours, 48 hours, 4 days, 10 days, and 14 days after the doxycycline pulse. Levels of TRIM43 mRNA
were significantly higher in treated cells as compared to untreated cells at the 24-hour (p<0 01), 48-hour (p<0 0001), and 4-day (p<0.01) time points (Figure 4A). In the treated cells, TRIM43 expression levels significantly decreased from 24 to 48 hours (p<0 01), 48 hours to 4 days (p<0.0001), and 4 days to 7 days (p<0.001). Levels at 7 days, 10 days, and 14 days between treated and untreated groups were not significantly different (Figure 4B). In addition, there was a significant decrease in untreated cells from 24 hours to 48 hours (p<0.01) and 48 hours to 4 days (p<0.05) (Figure 4).

Figure 4. Levels of DUX4 target gene TRIM43 mRNA with (blue) and without (orange) a doxycycline pulse. (A) Cells collected at 24 hours, 48 hours, 4 days, 7 days, 10 days, and 14 days. (B) Detail of cells collected 4 days, 7 days, 10 days, and 14 days.
We originally hypothesized that a 30-minute activation of DUX4 expression in human myoblast cells would be sufficient to sustain a heightened level of target gene expression over a 14-day period. We found that there was a significant increase in the expression of three
Ivy Miller and Corinne Moran
DUX4 target genes after 30 minutes of DUX4 expression, however, these increased expression levels only consistently remained above background expression levels for four days.
Although DUX4-induced cells’ target genes were expressed at significantly higher levels than control cells 24 hours post pulse induction, expression levels decreased after 48 hours and 4 days This sharp decline in expression levels may be attributable to the inability of doxycycline-induced expression to effectively activate DUX4 in every cell and the cytotoxic effects of DUX4 expression. Cells not expressing DUX4 would continue to proliferate while cells expressing DUX4 died This difference in lifespan likely increased the ratio of uninduced cells to DUX4-induced cells as the experiment progressed Though the exact percentage of effectively induced cells was not known for this experiment, even a small fraction of uninduced cells would have skewed results The amount of doxycycline used and duration of induction was based on prior, unpublished observations and experiments, chosen with the aim of accurately reflecting disease progression. It is possible that DUX4 activation levels were either too high, killing the majority of afflicted cells prior to the conclusion of the 14-day period, or too low, such that cells were ineffectively induced for DUX4 expression There was also a significant decrease in the levels of the untreated cells over the two-week period much like in the treated cells which can be attributed to leaky expression in the cell line. The leaky expression of DUX4 even in cells it was not induced in could have caused the same ratio issue as cells that were treated as those expressed with leaky DUX4 would die as the days progressed, decreasing the levels of untreated cells. It is also worth noting a limitation of this cell model is its inability to account for DUX4 interactions with other cell types and inference in non-myogenic processes.
In hopes of mitigating these limitations and creating a more faithful replication of FSHD in the body, we look to determine a more effective level of DUX4 activation for prolonged target gene expression using the LHCN #3 cell line. This would allow for more accurate continued experimentation using the LHCN #3 cell line to better understand the role of DUX4 expression in FSHD pathology The next steps include using flow cytometry, rt-qPCR, or immunohistochemistry to determine the percentage of cells effectively induced at various doxycycline amounts and durations of induction By observing the number of cells effectively induced for DUX4 and cell death in between data collection time points, we could investigate the large drop between the 24-hour and 48-hour time points of this experiment Continued research of FSHD pathology using in vitro cell models is crucial for future in vivo studies and the eventual development of FSHD therapies
We thank Dr. Kati Kragtorp for her guidance in research and academic writing, as well as our peers, whose feedback has been invaluable This research would not have been possible without the generous support of Dr. Michael Kyba, a professor at the University of Minnesota Department of Pediatrics, who opened the doors to his lab and allowed us the opportunity to conduct this research We would also like to give our appreciation to Dr. Darko Bosnakovski, an assistant professor at the University of Minnesota Department of Pediatrics, who advised us and taught us indispensable skills. Our work would not have been possible without the contributions of the Kyba lab as a whole and the resources of the Cancer and Cardiovascular Research Building.
Bosnakovski, D , Chan, S S K , Recht, O O , Hartweck, L. M , Gustafson, C J , Athman, L. L., Lowe, D A , & Kyba, M (2017) Muscle pathology from stochastic low level DUX4 expression in an FSHD mouse model Nature Communications, 8(1), 550 https://doi org/10 1038/s41467-017-00730-1
Bosnakovski, D , da Silva, M T , Sunny, S T , Ener, E. T , Toso, E A., Yuan, C., Cui, Z., Walters, M. A., Jadhav, A., & Kyba, M. (2019) A novel P300 inhibitor reverses DUX4-mediated global histone H3 hyperacetylation, target gene expression, and cell death Science Advances, 5(9), eaaw7781 https://doi org/10 1126/sciadv aaw7781
Bosnakovski, D , Shams, A S , Yuan, C , Silva, M T da, Ener, E T , Baumann, C W , Lindsay, A J , Verma, M , Asakura, A , Lowe, D. A., & Kyba, M. (2020). Transcriptional and cytopathological hallmarks of FSHD in chronic DUX4-expressing mice The Journal of Clinical Investigation, 130(5), 2465–2477 https://doi org/10 1172/JCI133303
Bosnakovski, D , Xu, Z., Ji Gang, E., Galindo, C L., Liu, M , Simsek, T , Garner, H R , Agha-Mohammadi, S , Tassin, A , Coppée, F , Belayew, A , Perlingeiro, R R , & Kyba, M (2008) An isogenetic myoblast expression screen identifies DUX4-mediated FSHD-associated molecular pathologies. The EMBO Journal, 27(20), 2766–2779 https://doi org/10 1038/emboj 2008 201
Choi, S H , Gearhart, M D , Cui, Z., Bosnakovski, D , Kim, M , Schennum, N , & Kyba, M (2016) DUX4 recruits p300/CBP through its C-terminus and induces global H3K27 acetylation changes Nucleic Acids Research, 44(11), 5161–5173 https://doi.org/10.1093/nar/gkw141
Dandapat, A , Bosnakovski, D , Hartweck, L. M , Arpke, R W , Baltgalvis, K A , Vang, D , Baik, J , Darabi, R , Perlingeiro, R C R , Hamra, F K , Gupta, K , Lowe, D A , & Kyba, M (2014) Dominant Lethal Pathologies in Male Mice Engineered to Contain an X-Linked DUX4 Transgene Cell Reports, 8(5), 1484–1496 https://doi org/10 1016/j celrep 2014 07 056
Himeda, C. L., & Jones, P. L. (2019). The Genetics and Epigenetics of Facioscapulohumeral Muscular Dystrophy Annual Review of Genomics and Human Genetics, 20(1), 265–291 https://doi org/10 1146/annurev-genom-083118-014933
Le Gall, L., Sidlauskaite, E., Mariot, V , & Dumonceaux, J (2020) Therapeutic Strategies Targeting DUX4 in FSHD Journal of Clinical Medicine, 9(9), 2886 https://doi org/10 3390/jcm9092886
Lim, K R Q , Nguyen, Q , & Yokota, T (2020) DUX4 Signalling in the Pathogenesis of Facioscapulohumeral Muscular Dystrophy International Journal of Molecular Sciences, 21(3), 729 https://doi org/10 3390/ijms21030729
Schätzl, T , Kaiser, L., & Deigner, H -P (2021) Facioscapulohumeral muscular dystrophy: Genetics, gene activation and downstream signalling with regard to recent therapeutic approaches: an update. Orphanet Journal of Rare Diseases, 16(1), 129 https://doi org/10 1186/s13023-021-01760-1
Toral-Ojeda, I , Aldanondo, G , Lasa-Elgarresta, J , Lasa-Fernandez, H , Vesga-Castro, C , Mouly, V , Munain, A L de, & Vallejo-Illarramendi, A (2018) A Novel Functional In Vitro Model that Recapitulates Human Muscle Disorders In K Sakuma (Ed ), Muscle Cell and Tissue Current Status of Research Field InTech. https://doi.org/10.5772/intechopen.75903
Yoshihara, M , Kirjanov, I , Nykänen, S , Sokka, J , Weltner, J , Lundin, K , Gawriyski, L., Jouhilahti, E.-M , Varjosalo, M , Tervaniemi, M H , Otonkoski, T , Trokovic, R , Katayama, S , Vuoristo, S , & Kere, J (2022) Transient DUX4 expression in human embryonic stem cells induces blastomere-like expression program that is marked by SLC34A2 Stem Cell Reports, 17(7), 1743–1756 https://doi org/10 1016/j stemcr 2022 06 002
Sarah Peterson
Sarah Peterson
Introduction
Plants have been defending themselves against insect herbivory for millions of years (Fürstenberg-Hägg et al., 2013). As a result, plants have developed diverse and complex defense systems Plants evolved to be able to distinguish between insect herbivory and mechanical damage, allowing them to not waste defense resources (Fürstenberg-Hägg et al , 2013). Insect herbivory initiates signal transduction pathways in plants, leading to the creation of defense compounds such as alkaloids, benzoxazinoids, cyanogenic glucosides, terpenoids, and glucosinolates (Fürstenberg-Hägg et al , 2013) These compounds, known as secondary metabolites, are often sent to both damaged and undamaged leaves, and they can repel the feeding insect, attract predators of the insect, or even, in the case of latex and resins, trap the insect (Fürstenberg-Hägg et al , 2013) However, defense compounds cost the plant valuable resources and energy. Thus, in order to defend themselves, plants require sufficient nutrients to create defense compounds and enough energy to create them (Fürstenberg-Hägg et al., 2013).
Because secondary metabolites require significant resources and energy, it seems logical that plants may be better able to produce them if they have increased access to nutrients However, previous studies examining the impact of fertilizer on insect herbivory have yielded conflicting results (Zaffaroni et al , 2020) One study, using wheat, found that the level of soil amendment had no effect on aphid densities (Archer et al , 1995) Another study found the highest number of aphids on chrysanthemum plants with an average level of fertilization (Zaffaroni et al , 2020) A study examining the

impact of soil nutrients on the level of alkaloids found that increased nutrients led to increased alkaloids in cultivated tobacco leaf tissue (Adler et al., 2006). This suggests that the impact of fertilization on insect herbivory may depend on the species of plant
Urban agriculture is quickly increasing as cities and communities try to recycle nutrients with practices like composting; however, little is known about the impact of soil amendments on insect herbivory in urban agriculture (Shrestha et al , 2020) The experimental urban garden at the University of St. Thomas was created to study the impact of different fertilizers on nutrient leachate It consists of 32 garden plots and six different soil treatments, two with different application rates. Each plot has one soil amendment and four types of plants (Shrestha et al., 2020). Current research in the garden primarily examines the fate of nutrients in urban agriculture (Shrestha et al , 2020) However, with the use of different soil amendments and plants commonly used in urban agriculture, the garden is the perfect place to investigate the impact of soil amendments on insect herbivory in urban gardens. If soil amendments can help mitigate pest damage, they could help control insect herbivory and minimize the use of pesticides.
Every week for six weeks, I randomly selected two bean leaves and two pepper leaves from each plot. The leaves were imaged and analyzed using an app called LeafByte (GetmanPickering et al., 2020) to measure levels of insect damage. Chlorophyll levels in sample leaves were collected weekly in all plots by other researchers, and were used as an indication of the level of available nitrogen (Ata-Ul-Karim et al , 2016) Contrary to my initial hypothesis, increased chlorophyll corresponded with
increased insect damage for both the beans and the peppers
The experimental urban garden used in this research is located at the University of St Thomas, in St. Paul, Minnesota, and consists of 32 raised plots. This garden is part of an ongoing research study examining nutrient recycling and soil leachate (Shrestha et al., 2020; Small et al., 2019). There are six soil amendments: high and low levels of municipal compost, high and low levels of manure, synthetic fertilizer, and no additives. The high level of manure/municipal compost was applied based on calculat d nitrogen demand in the plots. The low level manure/municipal compost is based calculated phosphorus demand; each plot with low level amendment also received synthe nitrogen to meet calculated nitrogen deman Every plot has one soil amendment and fo types of plants: bell peppers, bush beans, carro and collard greens. There are five plots with high level of manure compost, five with a lo level of manure compost, five with a high lev of municipal compost, five with a low level with municipal compost, six with synthe fertilizer, and six with no fertilizer (Shrestha al., 2020).
The application of manure and municip compost fertilizer was done by train researchers and based on estimated phosphor or nitrogen demand Plots with a high level either amendment received their manure compost based on estimated plant nitrog demand Similarly, plots with a low level manure or compost received their amendme based on phosphorus demand. Plots th received their amendment based on phosphor demand received less fertilizer because manu and municipal compost have higher levels phosphorus than nitrogen Thus, when soil amendments were applied based on plant nitrogen demand, more fertilizer was added than when they were applied based on plant phosphorus demand (Shrestha et al , 2020)
Each plot received sufficient or excess nutrients via the soil amendment and, for the plots with compost applied based on phosphorus demand, added inorganic nitrogen (Shrestha et al., 2020). The most mass of compost was applied for the high application of manure compost (Shrestha et al., 2020; Small et al., 2019).
Imaging ‘ scanner ’
I created a ‘scanner’ to study the size of leaves and the amount of herbivory on them. Four dots were added to a 8 x 11 inch piece of white printer paper The dots formed a square, each being 10 cm apart or 15 cm apart to form a square For week 1, the paper with a 10 x 10 cm square was used, but as the plants grew it was no longer large enough so a 15 x 15 cm square was

Using an iPhone and this scanner, I took photos of randomly selected leaves First, the leaf that was imaged was located using the randomization
Sarah Peterson
procedure described below. Using a dry erase marker, the plot number/letter, plant number, and branch number were written on the corner of the scanner. Holding the piece of plastic so the dotted box faced up, the leaf was placed between the upper piece of plastic and the piece of paper so the leaf was inside the dotted box. Then, a picture was taken If there was a lot of glare or shadows, pictures were taken from several different angles so the leaf could be analyzed.
I went to the garden twice a week for six weeks to collect data. I sampled half the garden each time, so that, over the course of the week, the entire garden was sampled once Each week, two plants of each species (peppers and beans) were sampled per plot. A single leaf from each sampled plant was photographed in every garden plot, for a total of 10 or 12 plants of each species sampled per treatment group each week.
The plants were chosen in a systematic order to ensure that each plant was sampled an equal number of times. The plants were numbered in rows from left to right, when the observer was facing east.
The peppers were sampled in the pairs: plants 1 and 5, plants 2 and 6, and plants 3 and 4 The plants were sampled in a cycle: 1 and 5 were sampled the first week, then 2 and 6 the second, and 3 and 4 the third As six weeks of data were collected, the cycle was repeated once
The beans were also sampled in pairs: plants 1 and 7, plants 2 and 8, plants 3 and 9, plants 4 and 10, plants 5 and 11, and plants 6 and 12 This cycle was only completed once, as there were 6 pairs of bean plants In both species, the pair numbers were chosen to ensure the sampled plants were spread out in the plot to control for random factors such as access to sunlight or variations in watering
For each data collection, one leaf per preselected plant was sampled. Leaves were chosen at random For each pepper plant sampled, a random number generator was used to indicate the stem to sample. Stems were numbered from
the ground up, with one being at the ground. As each stem only had one leaf, the stem number determined the leaf Before using the random number generator, the number of stems were counted and entered as parameters This ensured that the parameters in the number generator matched each plant.
For the beans being sampled, the random number generator indicated the branch to be sampled. The lowest branch off of the main stem was branch 1, the second was branch 2, etc. Each branch could have multiple groups of leaves. As such, if the branch chosen by the random number generator had multiple groups of leaves, the group of leaves was decided by the measurer at random by choosing the branch to follow before examining the leaves it led to. The bean leaves were in groups of three; only the middle leaf was sampled.
In order to be imaged, a leaf had to be at least 2 inches long Leaves smaller than two inches long were not counted as stems.
After data was collected, I analyzed the leaves using LeafByte (GetmanPickering et al , 2020) Before analysis, I titled the data collection with the week and changed the scale, the size of the box, to the correct value This was almost always 15.0 cm, but 10.0 cm for part of week 1. For each leaf, I selected the picture to be analyzed by using the ‘choose from gallery’ option. I adjusted the brightness so the background was white and the leaf was fully green (not white) The ‘exclude area’ button was used to exclude areas around the leaf that Leafbyte detected as herbivory, but were actually not Non-herbivory tears or holes in the middle of the leaf were not excluded, as this changed the total area of the leaf In the case of a hole or tear that was not from herbivory, the herbivory of the leaf was manually changed to zero after the Leafbyte analysis This was to maintain the correct leaf area
If there was outer damage on the leaf, the damage was drawn in using the ‘draw’ tool Outer damage was always drawn conservatively,
as to not overestimate the damage. If the tip of a leaf was gone from herbivory, only the parts that would clearly have been part of the leaf were drawn in; I did not attempt to draw the tip. In a similar conservative fashion, whenever it was unclear if damage was mechanical or from insects, the damage was not counted as herbivory
Sometimes LeafByte was unable to analyze a leaf due to shadows, glare, leaf miner damage, partial damage, or the piece of paper in the scanner being wet or dirty. Leaf miners are larvae of bugs that eat the inside of a leaf, creating light green or white lines on the leaf (Leafminers in Home Gardens, n.d.). Leafbyte is unable to detect these lines Partial damage refers to a bug eating one side of the leaf, but not eating all the way through. Like leaf miner damage, this leads to a discoloration An example of a bug that was observed in the garden that can cause partial damage is flea beetles
LeafByte is able to detect insect damage because it usually appears as white holes against the dark background of the leaf. However, when holes created by insects were in shadow or when there was excessive glare against the scanner, LeafByte could not detect the damage. Similarly, partial damage and leaf miner damage were not detected because they do not appear as white like holes do.
In all these cases, Adobe Photoshop (Adobe) was used to edit the images The leaf, scaling box, and identification were selected. Then, the rest of the photo, including any damage that was previously undetected by LeafByte, was manually changed to white. This removed detrimental shadows, mud, and glare It also made any insect damage white This allowed LeafByte to detect the damage, as it discerns herbivory as white spots Then, the edited images were analyzed as described above with LeafByte.
Once a week, I conducted a survey of insects found on plants in the garden I n all plots and in all sections of each plot, I inspected the leaves and soil for insects. Insect observations started 8-9 a m and ended around 10-11 a m Leaves were turned over to see if any insects were under them. Any insects observed were recorded in a notebook labeled with the plot, subplot, and a description of the insect When possible, images were taken of the insects. The bugs were identified using iNaturalist (INaturalist, n d )
Three times a week, chlorophyll readings were recorded by other researchers in the garden. Three leaves per subplot were randomly selected each recording day and their chlorophyll content was measured using a chlorophyll meter (AtLEAF Plant Meters and Software, n d ) To measure the chlorophyll, leaves were put into the slit in the atLeaf Chlorophyll Meter. Then, the green button was pressed and the number that appeared was recorded. I occasionally helped collect chlorophyll data. These researchers shared their data with me, which I compared with my insect damage data.
A Kruskall Wallace one-way ANOVA in MATLAB (Cardillo, 2009) was used to compare herbivory levels between amendment types. A Spearman correlation analysis in MATLAB (Leontitsis, 2022) was used to analyze the relationship between chlorophyll levels and herbivory
In an experimental garden comprised of 32 plots, two bean leaves and two pepper leaves were randomly selected from each plot weekly for six weeks. These leaves were imaged and the percent damage of the leaves was determined Chlorophyll readings on representative leaves in each plot were collected three times a week.
Sarah Peterson
Leaves of pepper plants grown in synthetic fertilizer had the lowest average percent damage at 0 58% The pepper leaves grown in municipal compost, applied to meet the nitrogen demand of the plants (MunN), had an average percent damage of 0 61% Pepper leaves grown in no fertilizer had an average of 0.92% damage. When grown in manure compost, applied to meet nitrogen demand (ManN), the pepper leaves had an average of 0.99% damage. Pepper leaves grown in manure compost, applied to meet phosphorus demand and with added synthetic nitrogen to meet nitrogen demand (ManP), had an average of 1 38% damage to their leaves Finally, pepper leaves grown in municipal compost, applied based on phosphorus demand and added synthetic nitrogen (MunP), had the highest average at 1.41% damage to their leaves (Figure 2). The differences in leaf damage observed between the different amendment types were not statistically significant (Kruskall Wallace; p=0.17).

Figure 2. Average percent damage for peppers in each amendment type: Synthetic fertilizer (n = 69), MunN (n = 59), None (n = 72), ManN (n = 60), ManP (n = 60), MunP (n = 59)
The average amount of chlorophyll in pepper leaves for each fertilizer type was determined using data collected by other researchers, although I did help with some of this data collection I selected the data that corresponded with the time prior to and during the weeks I collected insect damage data Data from atLeaf meters is provided as relative chlorophyll units (CHL; AtLEAF Plant Meters and Software, n.d.) The leaves grown in no fertilizer had an average
chlorophyll level of 57.13 CHL. Leaves grown in ManN had an average chlorophyll level of 57 34 CHL For leaves that were grown in MunN, the average chlorophyll level was 61.39 CHL Leaves grown in ManP had an average chlorophyll level of 63 27 CHL For leaves grown in synthetic fertilizer, the average chlorophyll l evel was 63 34 CHL, and for leaves grown in MunP, the average chlorophyll level was 65.75 CHL (Figure 3). Chlorophyll levels positively correlated with herbivory levels (Spearman correlation: r = 0 1679; p < 0 01)

Figure 3. Average chlorophyll data (± SEM) for each amendment type, peppers. Synthetic fertilizer (n = 306), MunN (n = 255), None (n = 306), ManN (n = 255), ManP (n = 255), MunP (n = 255)
Beans
For the bean plants, leaves grown in no fertilizer had the least damage, with an average of 0.06% damage Leaves grown in synthetic fertilizer had an average of 0.15% damage. Leaves grown in ManP had an average damage of 0.57%. For leaves grown in MunP, there was an average 0.47% damage. Leaves that were grown in MunN had an average damage of 0.52%. Bean plants grown in ManN had an average of 0 58% damage to their leaves (Figure 4). The differences in leaf damage observed between the different amendment types were not statistically significant (Kruskall Wallis; p=0.077).

Figure 4. Averages damage per treatment group, beans: None (n=57), Synthetic (n = 63), ManP (n= 45), MunP (n = 45), MunN ( n = 54), ManN (n = 53)
The chlorophyll data for the beans was mostly collected by other researchers who gave me access to their data, although I assisted in some of this data collection. Bean plants grown in no fertilizer had the least amount of chlorophyll, with an average of 46.58 CHL. Beans grown in synthetic fertilizer had an average chlorophyll level of 48 51 CHL For beans grown in ManN, the average chlorophyll level was 49.53 CHL. Beans grown in ManP had an average chlorophyll level of 50 42 CHL, and those grown in MunN had an average chlorophyll level of 52.43 CHL. Bean leaves grown in MunP had an average chlorophyll level of 53 02 CHL (Figure 5). Chlorophyll levels positively correlated with herbivory levels (Spearman correlation: r = 0 2250; and a p < 0 0001)

Figure 5. Average chlorophyll data (± SEM) for each amendment type, beans. None (n = 306), Synthetic (n = 306), ManP (n = 255), MunP (n = 255), MunN (n = 255), ManN (n = 255)
Every week except week 5, insects were observed in the garden The insects were identified and it was determined whether or not they could be eating the bean and/or pepper leaves The most commonly observed insects were whiteflies, which were observed every week. Next, the Japanese beetle, short horned grasshopper, and leafhopper were observed four out of the five observation weeks Eighteen distinct types of herbivorous insects were observed They likely represent a higher total number of different species, since some, such as leafhoppers and caterpillars, could not be identified at the species level Furthermore, the flea beetle, bean leaf beetle, and grasshopper were observed actively eating bean and/or pepper leaves
A Kruskall Wallace one-way ANOVA test did not find a significant overall difference between the amount of leaf damage compared to fertilizer type This lack of overall significance between fertilizer types may have been due to variability between different plots treated with the same type of fertilizer However, there was a significant, positive correlation between the average percent of insect damage and the average amount of chlorophyll per plot for both beans and peppers. Interestingly, which amendment types produced the highest and lowest levels of chlorophyll was different between the two types of plants. In both the peppers and the beans, the plants grown in no fertilizer had the lowest average level of chlorophyll, indicating the lowest level of nitrogen Similarly, peppers and beans grown in MunP, had the highest average chlorophyll levels. However, bean plants grown in synthetic fertilizer had the second lowest levels of chlorophyll, and peppers grown in synthetic fertilizer had the second highest levels of chlorophyll For peppers, plants grown in ManN had the second lowest amount of chlorophyll In beans, plants grown in ManN fertilizer had the third lowest levels of nitrogen Beans grown in ManP had the third highest level of chlorophyll levels, which was the same as the peppers.
Sarah Peterson
Peppers grown in MunN had the third lowest levels of chlorophyll, but beans grown in MunN had the second highest level of chlorophyll All plots, except the no fertilizer plots, received what was calculated to be sufficient nitrogen for the plants, either via the soil amendment or added synthetic nitrogen (Shrestha et al., 2020). However, both the peppers and the beans had different levels of chlorophyll, depending on the type of fertilizer.
Plants need nitrogen to produce ch lorophyll; thus, chlorophyll is used as an indicator of the nitrogen available to the plants (Ata-Ul-Karim et al., 2016). If the plants have insufficient nitrogen, their leaves will have less chlorophyll The results indicate that, as the chlorophyll levels increased in beans and in peppers, the amount of insect damage increased Plants that had more nitrogen, and were thus healthier, received more insect damage than plants with less nitrogen
Surprisingly, this study indicates that fertilizers with more nutrients did not help the beans and peppers defend themselves against insects, because plants grown in high-nutrient soil amendments actually had the most damage. Instead, it appears that the insects preferentially ate the plants with higher levels of chlorophyll. While imaging the plants over the course of six weeks, I observed that plants grown in no fertilizer and synthetic fertilizer appeared smaller and not as healthy as the plants grown in manure and municipal fertilizer Plants grown in no fertilizer and synthetic fertilizer had brittle, yellow, and brown leaves. Furthermore, as the summer progressed, many of these plants’ leaves fell off. It is possible that the high nutrient fertilizers did help the beans and peppers by allowing them to remain healthy and withstand the heavier insect damage.
The overall damage observed in the garden was low, with neither the beans nor the peppers having above an average of 1 5% herbivory in any of the treatments. This was not due to a lack of insects, as 18 different types of herbivorous insects were observed, some of which were seen actively eating the plants.
The main limitation in this study was uncertainty in the calculation of insect damage Many leaves had mechanical damage (rips, tears, etc) Furthermore, damage on the edge of a leaf required that the edge of the leaf be drawn in by hand Especially when the tip of a leaf was missing, it was difficult to draw in where the leaf ‘would’ be Thus, much care was taken to not overestimate damage done to leaves This may have resulted in underestimating the amount of insect damage to certain leaves, which could have skewed the results
There were also non-insect herbivores, such as rabbits, observed in the garden. Therefore, some of the observed damage, especially on the edges of leaves, could have been from animals that were not insects. This is somewhat unlikely, as rabbits rarely eat pepper leaves and their damage is different from insect damage, but is worth noting (How Does One Identify Rabbit Damage, and What Do They Eat? – Wildlife Damage Management, n.d.). Furthermore, much of the damage observed on both the beans and peppers was holes or small damage on the edge of leaves, which would not be from rabbits.
On insect observation days, plots were examined for insects in numerical order Insect observations star ted 8-9 a.m. and ended around 10-11 a.m. This time span likely impacted the insects I observed because I always looked for insects at the same time of day. Thus, it is unlikely I observed insects that are more active at dusk or at night Insects were identified using photos and iNaturalist. However, some insects moved before they could be photographed, and not all the insects I did photograph were able to be identified. Some insects could be identified generally, but the specific species was not able to be determined Furthermore, Leafminer damage was observed but I was unable to observe them directly because they are small and reside inside the leaf (Leafminers in Home Gardens, n d )
Chlorophyll was used in this study as a measure of nitrogen availability, which can contribute to a
plant’s ability to create secondary metabolites; however, levels of secondary metabolites were not directly measured To more accurately determine whether the soil amendments impacted the plant defenses, future research could measure the secondary metabolites in the bean and pepper leaves. This would better indicate the level at which the plants were attempting to defend themselves against insects
The scope of this study did not include a determination of which in sects caused the leaf damage Some damage, such as leaf miner and Japanese beetle damage, was easy to identify. However, much of the damage could have resulted from many of the insects observed in the garden. It would be interesting to examine the fertilizers’ effect on herbivory by different species of insects, such as native versus invasive species.
Plants and insects have very complex relationships that have evolved over millions of years. The results presented here are consistent with prior research indicating that the impact of soil amendments on plant defenses is dependent on the species of plant. Thus, future research can focus on different types of plants, determining the best type of fertilizer for each As urban agriculture continues to expand, it is important to find better ways to protect and enhance the growth of plants while reducing negative impacts on the environment, including those from pesticides or excess nutrients from fertilizers, helping keep both our ecosystems and our food systems healthy.
I would like to thank Dr. Gaston Small for his mentorship and constant support throughout my project. I would also like to express my gratitude to the other members of the garden team for rearranging their schedules and always being supportive of my work. Lastly, I would like to thank Dr. Kati Kragtorp for her guidance in creating my project and paper
Adler, L S , Wink, M , Distl, M , & Lentz, A J (2006) Leaf herbivory and nutrients increase nectar alkaloids Ecology Letters, 9(8), 960–967 https://doi org/10 1111/j 1461-0248 2006 00944 x
Archer, T L , Bynum, E D , Onken, A B , & Wendt, C W (1995) Influence of water and nitrogen fertilizer on biology of the Russian wheat aphid (Homoptera: Aphididae) on wheat Crop Protection, 14(2), 165–169. https://doi.org/10.1016/0261-2194(95)92872-K
Ata-Ul-Karim, S T , Cao, Q , Zhu, Y , Tang, L , Rehmani, M I A , & Cao, W (2016) Non-destructive Assessment of Plant Nitrogen Parameters Using Leaf Chlorophyll Measurements in Rice Frontiers in Plant Science, 7 https://www frontiersin org/articles/10 3389/fpls 2016 01829
AtLEAF plant meters and software (n d ) Retrieved December 30, 2022, from https://www.atleaf.com/Selling
Cardillo, G (2009) KWTEST: Kruskal-Wallis non parametric test for ANalysis Of VAriance MATLAB Central File Exchange http://www mathworks com/matlabcentral/fileexchange/25860
Fürstenberg-Hägg, J , Zagrobelny, M , & Bak, S (2013) Plant Defense against Insect Herbivores International Journal of Molecular Sciences, 14(5), 10242–10297. https://doi org/10 3390/ijms140510242
GetmanPickering, Z L , Campbell, A , Aflitto, N , Grele, A , Davis, J K , & Ugine, T A (2020) LeafByte: A mobile application that measures leaf area and herbivory quickly and accurately Methods in Ecology and Evolution, 11(2), 215–221 https://doi org/10 1111/2041-210X 13340
How does one identify rabbit damage, and what do they eat? –Wildlife Damage Management (n d ) Retrieved January 19, 2023, from https://wildlife-damage-management extension org/how-does-one-i dentify-rabbit-damage-and-what-do-they-eat/
INaturalist (n d ) INaturalist Retrieved July 6, 2022, from https://www inaturalist org/
Leafminers in home gardens (n d ) Retrieved December 20, 2022, from https://extension umn edu/yard-and-garden-insects/leafminers
Leontitsis, A (2022) Spearman Rank Correlation MATLAB Central File Exchange https://www mathworks com/matlabcentral/fileexchange/4374-spea rman-rank-correlation
Shrestha, P., Small, G. E., & Kay, A. (2020). Quantifying nutrient recovery efficiency and loss from compost-based urban agriculture PLoS ONE, 15(4), e0230996 https://doi org/10 1371/journal pone 0230996
Small, G E , Osborne, S , Shrestha, P , & Kay, A (2019) Measuring the Fate of Compost-Derived Phosphorus in Native Soil below Urban Gardens International Journal of Environmental Research and Public Health, 16(20), 3998. https://doi org/10 3390/ijerph16203998
Zaffaroni, M , Cunniffe, N J , & Bevacqua, D (2020) An ecophysiological model of plant–pest interactions: The role of nutrient and water availability Journal of the Royal Society Interface, 17(172), 20200356 https://doi org/10 1098/rsif 2020 0356
Trisha Samba and Amira Sinclair
Introduction
Approximately 14.4% of children live in households with incomes below the federal poverty threshold and many lack athletic opportunities because of it (Child Poverty in the United States | Econofact, 2021) According to data released by Aspen Institute’s Sports and Society program, household wealth is the primary driver for kids’ athletic participation Children ages 6 through 12 whose families' income is less than $25,000 are nearly three times more likely to not play a sport during the year compared to their peers, whose families’ income is greater than $100,000 (7 Charts That Show Why We Need to Fix Youth Sports, 2017) Often, it is difficult for low-income children to receive proper training and coaching due to this gap in wealth Thus, the income disparity in youth athletics affects health and success, stretching far into adulthood. This data shows the importance of encouraging youth athletics across all income levels. Having accessible sports training will enable many more children to become athletes, and pursue a healthier lifestyle.
In most sports, correct form is necessary to achieve optimal performance Despite being the fourth most popular sport in the United States, few studies have analyzed swimming exercise form (Health Benefits of Swimming | Healthy Swimming | Healthy Water | CDC, 2022) Swimming pools and coaches are often difficult to access especially for low-income families It would be useful for swimmers to have an inexpensive tool that could help them analyze their form to improve their swimming, thus providing support for swimmers with limited access to coaches.

Underwater undulatory swimming (UUS), with the exception of the dive, achieves the highest velocities, making it one of the most important factors in a swimmer’s racing performance (Cossor & Mason, 2001) During UUS, swimmers glide and then propel themselves forward through a series of lower-body and chest movements after diving off of the starting platforms, or blocks UUS is a technique in which the arms are outstretched and held together over the head, adopting a streamlined body position, while performing body undulations (Arellano et al., 2002). Swimming underwater results in a higher potential swimming velocity than surface swimming, since as depth increases, the wave drag, which represents 50-60% of the total passive drag force, decreases noticeably (Wilson, 2018)
The use of a full-body motion-tracking sensor system would greatly benefit those who lack resources for proper exercise training Specifically, the design of an inexpensive sensor suit to train swimmers in undulation form would help mitigate the income disparity in athletes, while providing athletes with efficient and proper training. Rapid development in sensor technology, such as motion capture systems or wearable devices, has advanced the field of human activity recognition. Motion capture technology plays an essential role in action recognition, motor function assessment, and dexterous human-robot interaction for rehabilitation robots and intelligent prosthetics Although many previous studies focus on human body movement sensing (Gayathri et al., 2018; “Measure 3D Body Movement Using Inertial Measurement Units (IMUs).,” n.d.; MVN Analyze, n.d.; Xenoma - Smart Apparel Company, n d ), there are few studies that involve a low-cost, full-body motion capture
system. From complex visual software that may depend on the environment (Rotella et al , 2012; SlimeVR 101, n d ) to $20,000 expenses (Caserman et al., 2021), an accessible full-body sensor suit is difficult to come across An inexpensive sensor system to track a user’s body would provide greater access to sports training.
We designed a sensor system using Inertial Measurement Units and flex sensors to track the user’s body when performing a swimming drill. The sensors tracked the user’s body movements, including joint bending and limb position These sensors were then connected to a humanoid bi-pedal robot to externally validate sensor accuracy The system can be developed to include haptic buzzers and provide an athlete with feedback. This system may allow swimmers to more easily afford out-of-water training.
Flex Sensors
First, a 4 5” long flex sensor (Adafruit) was used to measure the deflection of the user’s joints. The flex sensors were tested for functionality and accuracy To do this, a circuit was created by connecting a Raspberry Pi (RP) PICO (Adafruit) to a 10K ohm resistor through a breadboard, which was then connected to the flex sensor The RP PICO’s voltage was tested using a multimeter to test ground resistance on the breadboard An approximate value of 3 3V was recorded, affirming that the RP PICO was powered, and the circuitry functioned efficiently Next, the resistance was tested using a multimeter while bending the flex sensor. The flex sensor acts as a variable resistor Thus, to test the range of values of the flex sensor and how accurate the readings were, we bent the sensor and recorded the output voltage
Without bending the sensor, the voltage was 1.454V. While bending it at an approximately 90˚ angle, the voltage was 1.514V, meaning the flex sensor worked as expected: as it was bent, the voltage increased accordingly. This validated
that the flex sensor was sensitive enough to accurately measure body joint flexion
Next, the flex sensor was secured to the inner part of one of the student researcher’s arms using masking tape to test how attachment to a limb would affect the data collection (Figure 1)

Figure 1. Flex Sensor Circuit with Multimeter. Experimental set-up with a sensor attached to the student researcher's elbow Figure by authors
The ends of the sensor were secured from the middle of the sensor to the inner elbow and were also secured on either side However, as the elbow bent, the sensor buckled upwards Thus, the tape was removed from one of the ends to allow the sensor to slide along the arm instead of buckling upwards to provide more accurate readings. When the arm was not bent, the voltage was 1 434V When the arm was bent to a 90˚ angle, the voltage was 1 576V
The sensor was then moved to be similarly taped to the outside of the elbow While the arm was flat, the voltage was 1 429V While the arm was bent to a 90˚ angle, the voltage was 1.130V.
It was determined that the flex sensor had a greater range of values on the inside of the arm, making it the final orientation for optimal sensitivity when measuring body joint position. Thus, preliminary tests for the flex sensor were recorded with the sensor taped to the inside of the elbow. Pictures of the elbow were taken at six different approximate angles (0˚ , 25˚ , 50˚ , 80˚ , 90˚ , and 130˚), for five trials each, to digitally calculate the exact angle later on. The
pictures were taken using an iPhone that was secured in one spot throughout all trials The same trials were completed with the flex sensor flipped so that the side that was facing upwards was placed face down against the arm instead This was done to test the range of values All values were recorded.
ImageJ was used to determine the exact angle of the arm for each trial (Rasband, 1997) Each HEIC image was converted to JPG and then labeled with a trial number and approximated angle Then, the image was selected in the ImageJ application (Figure 2). Using the angle tool, a point was placed at the leftmost end of the flex sensor, the vertex point of the sensor, and the rightmost end of the sensor.

by authors.
The angle generated was the outside angle, thus the value was subtracted from 180˚ . The sensor's voltage, the approximated arm angle, and the actual angle were recorded This circuit was then soldered. The resistor was not included in the final circuit.
Two JY901 9-axis IMU (Adafruit) were used in the final system to understand the position of a limb in relation to the center of one’s body One IMU was used at the “trunk” or center of the torso, and the other was used on a limb to measure relative limb position
Trisha Samba and Amira Sinclair
First, both IMUs were calibrated. To calibrate the IMUs, the WT901 manual was downloaded from GitHub onto a computer An Arduino UNO was used as a bridge between the circuit and the computer To set up the circuit, the TX pin on the IMU was connected to the TX pin on the UNO. The same was done with the RX Pin. The VCC pin on the IMU was connected to the 5V pin, and the ground pin was connected to the corresponding ground pin (Figure 3).

Figure 3. IMU-Uno Connection. Wiring between JY901 IMU and Arduino Uno board. Figure by authors
Using an adapter, the Arduino UNO was connected to the PC Next, the Serial Driver folder was downloaded and installed from the WT901 Manual The device manager on the PC was used to check the connection The MiniIMU application within the Serial Driver folder contained the system to calibrate the IMU For a secure connection, the header pins were soldered to the IMU before calibration. During calibration, the address of the second IMU was changed to the 0x51 channel so that we could differentiate between the two IMUs. The IMUs were then spun in each direction slowly and reset to zero in X, Y, and Z for thorough calibration. Before testing, we edited a sample IMU code to test one of the IMUs The code is detailed in the “Programming” section
Our preliminary test with the IMU was conducted to understand if the Quaternion to
Euler conversion calculations that we programmed were done accurately This was done by connecting a single IMU to the RP PICO, which was then connected to our laptop to show the Quaternion and Euler angles The IMU was placed on graph paper and turned to 45˚ from vertical and 90˚ from vertical. The corresponding Quaternion and Euler angles were recorded The Quaternion angles were then put into a Quaternion to Euler converter to check that the calculations we programmed in the code were correct The final IMU circuit was soldered.
The initial values captured by the flex sensor were recorded. The flex sensor produced angle measurements from the amount of voltage flow impeded by sensor deflection. To confirm the accuracy of these readings, the angle values produced as the sensor was bent were compared with the relative voltage readings to confirm a strong correlation. The data for the relative voltage and angle values measured from the flex sensor within a 130˚ deflection cycle had a trendline equation of (1.71E^-03)x + 1.35 (Figure 4) Although there was a strong possibility of correlation between the voltage and the angle values of the flex sensor, there was also high variability in the measured angle values for similar voltage values. This suggests that although the sensor was accurate, it had relatively low precision

The inner elbow angle was measured as the flex sensor produced respective voltages (Tables 1 and 2), produced by two distinct face orientations of the flex sensor. When the sensor was faced right-side-up, it had a range of 0 3 volts (V; Table 1) When flipped, it had a value range of 0.15V. The right-side-up orientation had twice the range of the flipped orientation The flex sensor angles measured in the right-side-up trials were highly variable, with a range of 24 15˚ for a measured elbow angle at 130˚ (Table 1) The flex sensor angles measured in the flipped trials were more variable, with a range of 136 42˚ for a measured elbow angle at 78˚ (Table 2) The dramatically higher range of variability of angle measurements when the flex sensor is flipped compared to the right-side-up suggests a connectivity issue within the flex sensor when it is flipped. This indicated that the right-side-up orientation would be more effective for human motion capture Additionally, the wider range of the right-side-up orientation made it more accurate when given a set of fluctuating angles
The flipped orientation produced a wider domain of average angle values within the 130˚ rotation. In the right-side-up orientation, the flex sensor voltage plateaued at approximately 90˚ (Figure 5). The flipped orientation continued decreasing until the full 130˚ cycle was complete (Figure 6) The flipped orientation provided a more linear trend of average relative voltage and angle values (Figure 6) than the right-side-up orientation, which decreased exponentially just before 50˚ (Figure 5). However, due to the relatively low precision of the flex sensor, the greater range of the right-side-up orientation values allowed for the least-disrupted trend of angle values and more precise control of the robot. Thus, it was determined that the sensor system would be interfaced with the flex sensors right-side-up and would be effectively utilized within a range of 90˚ .
Table 1. Right-side-up Flex Sensor Trials
Table 2. Flipped Flex Sensor Data

Figure 5. Line Graph of Right-side-up Flex Sensor Trials Averages.

Figure 6. Flipped Flex Sensor Data Averages.
The IMU data was collected in three trials per robot angle and averaged (Figures 7-9) Each joint was rotated along either the X-axis or Z-axis. The charts compared the Euler angle output by the IMU to the physical angle of the robot limb measured by the internal servo encoders.

Figure 7. IMU Euler Angle Output vs. Robot Angle for Thigh - X-axis Movement with Line of Best Fit.
For the thigh joint, the Y and Z axes were expected to be constant as the limb was only rotated along the X axis For the hip joint, the X and Y axes were expected to be constant.

Figure 8. IMU Euler Angle Output vs Robot Angle for Hip - Z-axis Movement with Line of Best Fit
For the shin joint, the Y and Z axes were expected to be constant as well. A more linear data trend indicated a stronger correlation between the IMU and internally measured values.

Figure 9. IMU Euler Angle Output vs Robot Angle for Shin - X-axis Movement with Line of Best Fit.
It showed that the sensor was accurate in measuring the actual position of the robot The thigh (Figure 7), hip (Figure 8), and shin (Figure 9) trials all had a strong positive correlation between Euler and robot angles in the X, Y, and X directions respectively. When the robot angle was at -110˚ , the IMU indicated an Euler angle of -110 14˚ When the robot angle was 25˚ , the IMU indicated an Euler angle of -27.69˚ .
The data captured by IMU during continuous movement of the thigh compared to the actual
robot angle measured by the robot’s encoder is shown (Figure 10) There was a positive linear relationship between the IMU Euler Angle with the internally measured robot angle during the period of continuous angle movement Thus, the IMUs could be concluded to have high proportional accuracy. Given that the angles are proportional, the IMU could be utilized to capture human motion for accurate robot teleoperation.

Fit
The flex sensor and IMU validity trials demonstrated the accuracy of the sensors and determined the ranges of accurate angle measurement. The flex sensor orientation trials determined that the right-side-up position of the flex sensor produced the most accurate results; however, it was found that the data produced by the flex sensor had low precision with the high and low extreme value ranges
A number of conclusions can be drawn from this work. Despite variation in single measurement accuracy, when averaged, the flex sensor was accurate within a range of 1.28 to 1.56 volts. When the angle values that the IMU measured were compared to the actual angle of the robot limbs, there was a positive correlation between the sensor and the physical values. This demonstrates that the IMUs accurately captured the joint positions, indicating that both flex sensors and IMUs could be effective alternatives to expensive high-resolution motion sensors for the teleoperation of the bi-pedal robot.
Although the relative imprecision of the flex sensors did not impede their accuracy in capturing human motion values that could be replicated by the bi-pedal robot, it might pose an issue for haptic feedback calibration To determine the correct form of the undulation form, the system must be calibrated by wearing the sensors as the athlete performs the correct form and the values are captured Those values will then be used to set the ranges for the proper undulation form and to program the vibration motors for haptic form correction Additionally, the relative imprecision of the ground values collected for vibrations, and the values collected by the training wearer as they train their form, could be compounded making the feedback less accurate A possible solution would be to interface more flex sensors into each joint of the system. Although the flex sensor varied greatly within a set stagnant angle value, when the fluctuating values were averaged, the angle produced was consistently accurate. Adding 1-2 more flex sensors ($20 per sensor) would allow the values to be averaged and improve precision while maintaining a low-cost system.
The sensor system detailed in this paper was designed to facilitate the integration of vibration motors to provide force feedback for sports training The next step will be to interface vibration motors into the system. The motors will be programmed and mapped with set value angle ranges of the correct form to give a vibration response when the set values are exceeded. This range can be set by an experienced athlete wearing the suit and recording the values produced when they execute the undulation drill. The vibration motors can then be programmed to provide feedback based on those values for any user. The system can be applied to a wide range of sports skills This system has additional applications in manual job training and physical therapy. Because the sensors are inexpensive and accessible, and their system is easily adaptable for different tasks, future iterations of the system
can be simplified into a kit for those without much previous electronics experience to construct their own version of the training system to bring personalized sports training into the hands of those who don’t have access to formal coaching
Inertial and deflection motion capture and imitation systems require high-precision sensors to capture accurate movement replication Recent advances in technology have achieved expensive haptic systems which incorporate vibration feedback into motion capture systems In order to provide a tool for accessible sports training feedback the technology must be simplified while preserving the motion-tracking resolution. The conducted study presents the successful conclusions of the first phase in developing a full-body sensor system that has been constructed with affordable and accessible components In the second phase, the sensor system will be interfaced with haptic vibration motors. With this design, our system can be applied to help all athletes better afford training and make sports involvement more accessible
This paper and the research behind it would not have been possible without the exceptional support of our mentor, Dr. Perry Y. Li. We would like to thank him for giving us the opportunity to explore the field of engineering and for his continued support and guidance during our research. Furthermore, we would like to thank Dr Kati Kragtorp for providing us with this amazing opportunity and continuing to support us. Finally, we would like to thank our classmates, friends, and family Without their help, we would not have been as successful in pursuing our research, and we cannot thank them enough
7 Charts that Show Why We Need to Fix Youth Sports (2017, September 5) The Aspen Institute https://www aspeninstitute org/blog-posts/7-charts-show-fix-youthsports/
Arellano, R , Pardillo, S , Gavilán, A , & Granada, H U D (2002) Underwater undulatory swimming: Kinematic characteristics, vortex generation and application during the start, turn and swimming strokes. Proceedings of the XXth International Symposium on Biomechanics in Sports, Universidad De https://www researchgate net/publication/255651782 Underwater undulatory swimming Kinematic characteristics vortex generati on and application during the start turn and swimming strokes
Caserman, P , Krug, C , & Göbel, S (2021) Recognizing Full-Body Exercise Execution Errors Using the Teslasuit Sensors (Basel, Switzerland), 21(24), 8389. https://doi org/10 3390/s21248389
Child Poverty in the United States | Econofact (2021, February 5) https://econofact org/child-poverty-in-the-u-s
Cossor, J , & Mason, B (2001) Swim Start Performances At The Sydney 2000 Olympic Games ISBS - Conference Proceedings Archive https://ojs ub uni-konstanz de/cpa/article/view/3870
Gayathri, S , Mythreyee, V , Selvi, C , & Prabhu, V (2018) Human Body Motion Control for Humanoids and Bipedal Robots International Journal of Pure and Applied Mathematics, 119(No 15), 705–713
Health Benefits of Swimming | Healthy Swimming | Healthy Water | CDC (2022, February 18) https://www.cdc.gov/healthywater/swimming/swimmers/health be nefits water exercise html
Measure 3D body movement using inertial measurement units (IMUs) (n d ) Noraxon USA Retrieved June 28, 2022, from https://www noraxon com/our-products/3d-motion-capture-imu/
MVN Analyze (n d ) Retrieved June 28, 2022, from https://www xsens com/products/mvn-analyze
Rasband, W S (1997, 2018) ImageJ U S National Institutes of Health, Bethesda, Maryland, USA, https://imagej nih gov/ij/ Rotella, M F , Guerin, K , He, X , & Okamura, A M (2012) HAPI Bands: A haptic augmented posture interface 2012 IEEE Haptics Symposium (HAPTICS), 163–170 https://doi org/10 1109/HAPTIC 2012 6183785
SlimeVR 101 (n d ) SlimeVR Docs Retrieved June 28, 2022, from https://docs slimevr dev/
Wilson, B (2018) Technology For Within Stroke Analysis In Swimming ISBS Proceedings Archive, 36(1), 1024
Xenoma Smart Apparel Company - (n d ) Xenoma - Smart Apparel Company - Retrieved June 28, 2022, from https://xenoma.com/
Kendall White
Introduction
Glioblastoma multiforme (GBM) is the most common type of primary malignant brain tumor in adults (Glioblastoma Multiforme, n.d.). Unfortunately, it also carries an exceptionally poor prognosis, with a 5 year survival rate of 5.5% (Ostrom et al., 2017). The nature of the disease is extremely complex, which prevents many advanced treatments from finding success Complicating factors include the unique tumor and immune microenvironment and blood-brain barrier (Tan et al , 2020) As surgery and chemotherapy do little to cure GBM, scientists have turned to immunotherapy as an avenue for potential new treatments
The capacity of the immune system, especially T-cells, to combat cancer is well established (Waldman et al , 2020) However, cancerous cells can exploit various pathways and functions of the immune system to continue growing unchecked One of these functions utilized by cancerous cells to evade detection by the immune system is immune checkpoints. The purpose of immune checkpoints is to prevent T-cells from attacking normal and healthy human cells. However, cancerous cells can use these immune checkpoints to prevent being detected and killed by the immune system, leading to unchecked tumor growth and metastasis (Immune Checkpoint Inhibitors, 2022) Targeting these pathways to turn the immune system back ‘on’ has led to success with various forms of difficult-to-treat cancer, including melanoma, triple-negative breast cancer, and small-cell lung cancer (Waldman et al , 2020)
A checkpoint thought to be involved in GBM proliferation is CD200 (Xiong et al., 2020). A novel treatment currently in a phase 1 clinical

trial uses a peptide designed to activate this pathway, hopefully allowing the immune system to recognize and destroy glioblastoma cells The peptide (hP1A8) is being delivered in combination with imiquimod and an allogenic GBM6-AD vaccine to treat recurrent glioblastoma in adults (OX2 Therapeutics, 2021)
To give patients the best treatment possible, it’s necessary to know whether or not this drug is working for them. If the treatment is working, the levels of the patient’s IgG antibodies specific to the tumor should be high, indicating that the immune system is being activated to fight the cancer An enzyme-linked immunoassay (ELISA) test can be used to determine antibody levels. ELISAs involve using antigen-antibody binding to determine the concentration of a selected target antibody. To begin the ELISA process, plates are first coated with antigen, then incubated in a primary antibody solution Then, they are incubated in a secondary antibody solution, where the secondary antibody is nonhuman and recognizes the primary antibody, and is attached to an enzyme that will elicit a change in color or fluorescence when a substrate is added The change in color should be proportional to the amount of the primary antibody present (Hornbeck et al., 1991). However, for this to be the case, the ELISA must first be optimized. This involves ensuring that the primary antibody is strongly binding to the antigen, without non-specifically binding to other components of the assay. Specificity of binding with the secondary antibody must also be achieved To do this, the correct level and type of ions must be identified to maximize specific binding between the relevant proteins (Factors Affecting Signal Generation in ELISA, n.d.). If the ELISA is fully optimized, a standard
curve should show sensitivity, range, and linearity Wells known to have higher levels of primary antibody should have high return, and wells with lower levels of primary antibodies should have low return Further, the gradient should be much more strongly established in tests run with patient sera as the primary antibody versus the control, normal human sera The primary antibody should also not display nonspecific binding to antigen of another type.
In the ELISA described here, the antigen used was from an immortalized GBM cell line The primary antibody was deidentified patient sera from a phase I clinical trial for the novel treatment described above (Figure 1) Three sample diluent compositions were tested, at dilutions ranging from 1:1000 to 1:32000, to find the optimal diluent A solution containing 2mM EDTA, 0.02% NaN3, and 2.5% BSA successfully produced a concentrationdependent signal Unexpectedly, there was a slight decrease in patient sera signal as compared to control, but no difference between patient and control sera in a negative control using antigen from a breast cancer cell line. Additional work is required to determine whether further optimization will resolve this or if the treatment is not working as expected.

Figure 1. Diagram of ELISA mechanics. (Figure by author)
Materials and Methods
Antigen coating
Each well in the ELISA plates was coated with 100µL of a buffer solution This solution consisted of a 15 µg antigen/mL bicarbonate buffer (Bioworld). The antigen was a lysate from
GBM6-AD, an immortalized glioblastoma cell line The plates were then incubated overnight at 4°C After incubation, the plates were washed three times with a wash buffer, comprised of 1x PBS and 0 1% Tween 20 (Sigma Aldrich)
Blocking
After washing, the plates were filled with 250µL of blocking buffer, then incubated overnight at 4°C The block buffer was 1x PBS, 2 5% bovine seru m albumin (BSA; Calbiochem), 5% sucrose (Sigma Aldrich), and 0 02% NaN3 (Sigma Aldrich) The following day, the plates were tapped off and allowed to dry overnight in a fume hood The plates were then returned to their pouches with a desiccant pouch and stored for up to two weeks at 4°C.
Deidentified patient sera from an ongoing phase I clinical trial and commercially-sourced normal human sera (Fisher Scientific) were separately diluted into a sample diluent buffer The composition of sample diluent varied (see Optimization), and concentrations of sera began at 1:1000 and became further diluted by a factor of two for each subsequent well, down to a 1:32,000 dilution. There was also a well consisting of just sample diluent buffer with no added sera.
Secondary antibody
Each dilution was pipetted into two wells on the prepared ELISA plate, and allowed to incubate for an hour at room temperature. Following this, the plates were washed four times with wash buffer. Each well was filled with 100 µL of Mouse anti-Human IgG1 Fc Secondary Antibody, HRP (Thermo Fisher) diluted in sample diluent at a 1:5000 ratio. Then, the plates were incubated again for an hour at room temperature
Plate development
After incubation, the plates were washed four times with wash buffer Then, 100 µL of tetramethylbenzidine substrate solution (Thermo Fisher) was added to each well, and allowed to
incubate at room temperature for 10 minutes. Finally, 100 µL of stop solution (Invitrogen) was added to each well
Data analysis
The plates were scanned using a standard plate reader Data gathered was analyzed using GraphPad Prism version 8.0.0 for Windows.
Optimization
Solutions for sera dilution were varied to identify the optimal composition.
Solution A was composed of 20 µL of 1M NaCl and 1M KBr added to 100 µL of 2 mM EDTA, 0.02% NaN 3, and 2.5% BSA containing a dilution of the patient or control samples.
Solution B was 20 µL of 10mM EDTA, 0 02% NaN3, and 5% BSA added to 100 µL 2 mM EDTA, 0.02% NaN3, and 2.5% BSA containing a dilution of the patient or control samples
Solution C consisted of 100 µL of 2 mM EDTA, 0.02% NaN3, and 2.5% BSA containing a dilution of the patient or control samples
Duplicate control and patient samples were diluted in Solution A at concentrations ranging from 1:1000 to 1:32000 An ELISA was performed as described, including blank wells containing only Solution A. Adjusted absorbance levels were calculated by subtracting absorbance values from blank wells for each series (Table 1). Average absorbance of the duplicated samples showed a general, but inconsistent decrease with increased serum dilution factors. With the exception of the 1:1000 dilution, patient samples generated higher average adjusted absorbance than control samples (Figure 2).
Table 1. Adjusted absorbance values for control and patient samples diluted in Solution A relative to blank signal value for each dilution series

Figure 2. Average adjusted absorbance values for control and patient samples at six dilution levels
Duplicate control and patient samples were diluted in Solution B at concentrations ranging from 1:1000 to 1:32000 and an ELISA was performed as described, including blank wells containing only Solution B. Adjusted absorbance levels were calculated by subtracting absorbance values from blank wells for each series (Table 2). Average absorbance of the duplicated samples showed a general, but inconsistent decrease with increased serum dilution factors, and was higher for control samples than for patient samples The average adjusted absorbance levels for three patient dilution levels and one control dilution level fell below background (Figure 3)
Table 2. Adjusted absorbance values for control and patient samples diluted in Solution B relative to blank signal value for each dilution series
1:1000 0.1755 0.1265 0.1205 0.0105
1:2000 0 0355 0 1215 0 1205 -0 0545
1:4000 -0.0395 0.0275 0.0545 -0.1345
1:8000 0 0175 0 1065 0 0565 -0 1415
1:16000 0.0295 0.0135 0.1035 -0.1775
1:32000 -0 0345 0 1775 0 0245 -0 1515

Figure 3. Average adjusted absorbance values for control and patient samples at six dilution levels
Duplicate control and patient samples were diluted in Solution C at concentrations ranging from 1:1000 to 1:32000 and an ELISA was performed as described, including blank wells containing only Solution C. Adjusted absorbance levels were calculated by subtracting absorbance values from blank wells for each series (Table 3). Average absorbance of the control and patient samples showed dose dependence, and was higher for control samples than for patient samples (Figure 4).
Table 3. Adjusted absorbance values for control and patient samples diluted in Solution C relative to blank signal value for each dilution series
1:1000 1.0025 0.9755 0.7425 0.7955
1:2000 0 5075 0 5095 0 3955 0 3865
1:4000 0.2765 0.2525 0.1595 0.2025
1:8000 0 1675 0 0865 0 0225 0 0135
1:16000 0.1195 0.0745 -0.0145 -0.0025
1:32000 0 0975 0 0585 -0 0355 -0 0375

Figure 4. Average adjusted absorbance values for control and patient samples at six dilution levels
As a control, additional ELISA plates were coated with 4T1 breast cancer cell lysate rather than GBM6-AD lysate. ELISAs were otherwise performed as described Duplicate control and patient samples were diluted in Solution C at concentrations ranging from 1:1000 to 1:32000, including blank wells containing only Solution C Adjusted absorbance levels were calculated by subtracting absorbance values from blank wells for each series (Table 4) Average absorbance of the control and patient samples showed dose dependence, and was not consistently higher or lower in control versus patient samples (Figure 5)
Kendall White
Table 4. Adjusted absorbance values for control and patient samples diluted in Solution C relative to blank signal value for each dilution series The antigen coating is 4T1 breast cancer cell lysate instead of GBM6-AD
Control Control Patient Patient
1:1000 1.351 1.444 1.356 1.405
1:2000 0 725 0 738 0 746 0 782
1:4000 0.365 0.405 0.42 0.368
1:8000 0 193 0 212 0 242 0 163
1:16000 0.091 0.108 0.201 0.072
1:32000 0 078 0 109 0 114 0 04

Figure 5. Average adjusted absorbance values for control and patient samples at six dilution levels, with 4T1 breast cancer cell lysate coating instead of GBM6-AD
Discussion
The goal was to develop an ELISA with a high signal to background ratio to test for the presence of GBM specific antibodies. If optimized, wells with higher concentrations of sera would have a correspondingly high color change, and wells with lower concentrations of sera would be pale in color Tests with 4T1 antigen should have lower return than tests with GBM6-AD lysate. Assays with normal human antibodies should have lower signals than tests with patient sera. These objectives were not fully met. Across most tests, the control gave a slightly higher return than patient samples Furthermore, the control test with 4T1 lysate
delivered a similar curve to the GBM6-AD lysate
From the solutions tested, Solution C resulted in the highest sensitivity and produced the best gradient. This result contradicts with past studies, which suggest that Solution A and B should have performed better. Due to the higher concentration of ions and chelating agents, the level of background noise was expected to be lower. This contradiction could have several explanations. Perhaps the concentrations of solutions A and B were too high and also limited specific binding between components of the immune complex. Alternatively, the contradiction could be a result of differences from time elapsed between plate preparation and usage.
Anecdotally, the longer plates were stored before tests were run, the lower the signal to background ratio was. It’s possible that during the time after the initial plate coating, the antigen began to break down This would hinder specific binding to the primary antibody. To mitigate this issue, a standard could be set to use plates within one week of antigen coating Another factor that could have a n impact on return is that the patient samples were pooled. If only a subset of patients are experiencing immune activation, this could dilute antibody levels and that response may not be detectable. This could be addressed by running several tests with different individual samples.
After continued optimization attempts, if the GBM antigen coated plates have similar results to the 4T1 coated plates, this could prompt further reflection into the choice of ELISA. This method is an indirect ELISA In the case of continued failure with the indirect ELISA, it may be worthwhile to try a sandwich ELISA. Sandwich ELISAs typically have a higher signal-to-noise ratio, although they can be more difficult to optimize due to the addition of more elements to the already complicated immune complex (ELISA Technical Guide and Protocols, n.d.).
If the GBM antigen plates are producing better linearity and sensitivity than the 4T1 plates, but
the normal human and patient antibodies are producing similar results, this would lead to questions regarding either the efficacy of hP1A8 or the integrity of the patient sera.
I’d like to thank Dr Michael Olin and Sumant Dhawan in the Masonic Cancer Center of the University of Minnesota for their guidance and mentorship throughout my project I’d also like to express my gratitude to Dr Kati Kragtorp for her guidance in my project and paper development
ELISA technical guide and protocols (n d ) Pierce Biotechnology Retrieved December 26, 2022, from http://tools thermofisher com/content/sfs/brochures/TR0065-ELIS A-guide pdf
Factors Affecting Signal Generation in ELISA (n d ) Thermo Fisher Scientific Retrieved December 18, 2022, from https://www thermofisher com/us/en/home/life-science/protein-biol ogy/protein-biology-learning-center/protein-biology-resource-libra ry/pierce-protein-methods/overview-elisa/factors-affecting-ELISAsignal html
Glioblastoma Multiforme (n d ) Brain Tumour Research Retrieved August 24, 2022, from https://www braintumourresearch org/info-support/types-of-brain-t umour/glioblastoma-multiforme#:~:text=Is%20Glioblastoma%20al ways%20fatal%3F,of%20cases%2C%20it%20is%20fatal
Hornbeck, P , Winston, S , & Fuller, S (1991) Enzyme-Linked Immunosorbent Assays (ELISA) Current Protocols https://doi org/10 1002/0471142727 mb1102s15
Immune Checkpoint Inhibitors (2022) National Cancer Institute https://www cancer gov/about-cancer/treatment/types/immunothera py/checkpoint-inhibitors
Ostrom, Q T , Gittleman, H , Liao, P , Vecchione-Koval, T , Wolinsky, Y , Kruchko, C , & Barnholtz-Sloan, J S (2017) CBTRUS Statistical Report: Primary brain and other central nervous system tumors diagnosed in the United States in 2010–2014. Neuro-Oncology, 19(suppl 5), v1–v88. https://doi org/10 1093/neuonc/nox158
OX2 Therapeutics (2021) Study of CD200 Activation Receptor Ligand (CD200AR-L) and Allogeneic Tumor Lysate Vaccine Immunotherapy for Recurrent Glioblastoma (Clinical Trial Registration study/NCT04642937) clinicaltrials gov https://clinicaltrials gov/ct2/show/study/NCT04642937
Tan, A C , Ashley, D M , López, G Y , Malinzak, M , Friedman, H S , & Khasraw, M (2020) Management of glioblastoma: State of the art and future directions CA: A Cancer Journal for Clinicians, 70(4), 299–312 https://doi org/10 3322/caac 21613
Waldman, A D , Fritz, J M , & Lenardo, M J (2020) A guide to cancer immunotherapy: From T cell basic science to clinical
practice Nature Reviews Immunology, 20(11), 651–668 https://doi.org/10.1038/s41577-020-0306-5
Xiong, Z , Ampudia Mesias, E , Pluhar, G E , Rathe, S K , Largaespada, D A , Sham, Y Y , Moertel, C L , & Olin, M R (2020) CD200 Checkpoint Reversal: A Novel Approach to Immunotherapy Clinical Cancer Research, 26(1), 232–241 https://doi org/10 1158/1078-0432 CCR-19-2234
Breck School
123 Ottawa Avenue North Golden Valley, MN 55422
breckschool.org | 763.381.8100